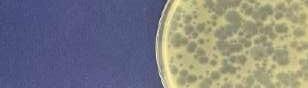

INDEX
● biocloth 1
● Daily palette ..................................... 9
● process#100 19
ベーシック │ Basic
■ カラーパレット.......................................... 27
■ カラーセレクション................................. 35
■ 壁紙の選び方 51
■ ベーシックセレクション.......................... 53
■ プロジェクター用壁紙............................ 62
■ 天井............................................................ 63
■ 機能性説明............................................... 67
■ ハードストレッチ壁紙............................. 71
■ ウレタンコート壁紙................................. 83
■ 抗ウイルス壁紙........................................ 89
■ 抗アレル壁紙............................................ 93
■ ライトフレッシュ壁紙 97
■ フィルム汚れ防止 バリアタイプ 103
■ スーパー耐久性.................................... 109
■ フィルム汚れ防止 バランスタイプ .... 115
■ スーパークリーン.................................. 119
■ 吸放湿壁紙............................................ 121
■ 通気性壁紙............................................ 127
■ 木目.......................................................... 129
■ コンクリート・ストーン......................... 137
■ タイル・レンガ........................................ 145
■ 和.............................................................. 155
■ MEGUReWALL................................. 161
パターン │ Pattern
■ EDA "HAMPSHIRE GARDENS" 163
■ Finlayson 171
■ kippis 179
■ パターン 185
■ 国立科学博物館 .................................... 219
■ 蓄光.......................................................... 227
特殊商品
■ デジタルプリント(HIGH GRAFICA) 229
■ マグネット................................................ 235
■ ホワイトボード....................................... 236
■ スマートジョイナー(見切り材) 237
■ モールド................................................... 239
■ ラウファーザー(塗装下地) 240
■ カラーコーク・接着剤........................... 241
サ ンゲ ツは持続 可能な開発目 標(SD G s )を 支 援しています。
地球環境を守るサステイナブルな社会の実現 気候変動、海洋・土壌汚染の深刻化の一方、高齢化・人 口減少が進み、使用されない住宅・建物が増加していま す。サンゲツグループは、サプライチェーン全体の環境負 荷を低減し、長く使い続けられる空間の創造を通じ、ス トック建築物の有効活用とともに、地球環境を守るサス テイナブルな社会の実現に貢献します。
リザーブ専用検索ページはこちら
こちらの二次元コードを読み込むとリザーブに 掲載の商品を などか ら検索することができます。
品番 デザイン 機能性
PFCフリーの商品を 掲載しています
2024-2027 リザーブ見本帳では、より環境負荷の少な い非フッ素系の撥水剤を採用しています。従来品と同等 の撥水性能を有しており、安心してご使用いただけます。
※掲載商品全点ではありません。対象品番については 二次元コードよりご確認いただけます。
※新仕様と旧仕様の在庫が混在する期間がございます。
対象商品・詳細はこちら▶
各ページの二次元コードから
全商品の施工例写真を チェック


商品検索 はこちら。
セ ク

各ページの二次元コードを読み込む と、掲載商品全ての施工例写真を WEB上でご覧いただけます。






-
Wallcoverings for the sustainable future, created from plant-based materials.
ー バイオクロス ー
biocloth(バイオクロス)は、
植物由来の原材料を使用したサステイナブルな壁紙です。
01
植物油を主原料とした可塑剤を使用した、バイオマスマーク認定ビニル壁紙
一般的な石油由来の可塑剤を使用しないため、天然資源の節約に貢献します。
安心・安全のフタル酸フリー フタル酸エステル系可塑剤を不使用。より安心・安全にお使いいただけます。
より環境負荷の少ない非フッ素系の撥水剤 従来品と同等の撥水性能を有しながら、環境負荷の少ない撥水剤を使用しています。 02
変わらない施工性 サステイナブルな壁紙でありながら、一般的なビニル壁紙と同等の施工性を有します。 04 03
Verdant Grounds
緑あふれる大地に包まれて 深呼吸をする


RE55006
WEBサイトで見る。 1
Airy Moment
澄んだそよ風が通り抜ける 軽やかな空気感


Quiet Canvas
自分だけの穏やかな空間を彩る 繊細なキャンバス
RE55018 TRISHNA JIVANA ▶ GUBI / 1965 Pendant Base:Brass Shade:Soft Black Semi Matt www.trishnajivana.jp
RE55011 バイオマスマークとは? 使用部位:壁紙 No.210125 バイオマスマークは生物由 来の資源(=バイオマス)を 活用し、品質および安全性 が関連する法規、基準、規格 等に適合している環境商品 の目印です。一般社団法人 日本有機資源協会によって 認定されています。 2
自然の風合いを感じるおおらかな塗りのテクスチャーに、自然界の色調から抽出したカラーリング。 緑あふれる大地で深呼吸するかのような、優しく癒される空間を演出します。
Verdant Grounds
ヴァーダント グラウンズ


RE55003
3
巾92.5cm ↕64cm ↕ 92.5cm エンボスリピート 防かび 抗菌 表面強化 吸放湿 撥水 ストレッチ 撥水
防火種別2-3 AA 1,090円/㎡
準不燃







壁紙:RE55006 床材:IS-2104(2023-2026 FLOOR TILE)
mugwort mimosa erde ecru origin RE55001 NEW リフォームおすすめ RE55003 NEW リフォームおすすめ RE55005 NEW リフォームおすすめ
NEW リフォームおすすめ
NEW リフォームおすすめ RE55006 NEW リフォームおすすめ リフォームおすすめ イメージ写真を 全点見る 4
verdant
RE55002
RE55004

ACTUS ▶ NATADORA / BUREAU SOFA / https://www.actus-interior.com
TRISHNA JIVANA ▶ GUBI / Gravity Table Lamp – Small [ Grey Marble, Canvas shade] / https://www.trishnajivana.jp
軽やかに通り抜ける風のように、爽やかなカラーのスタッコ調。
まるで空気のように空間に溶け込みながらも、しっかりとインテリアを引き立ててくれるデザインです。
Air y Moment RE55011
エアリー モーメント 5 防火種別2-3 AA 1,090円/㎡ 巾92.5cm ↕64.1cm ↕ 92.5cm エンボスリピート 防かび 抗菌 表面強化 吸放湿 撥水 ストレッチ 撥水 準不燃







RE55009 sprout seaglass haze shade moonlight airy RE55007 NEW リフォームおすすめ
RE55011 NEW
NEW リフォームおすすめ
NEW
RE55012 NEW リフォームおすすめ リフォームおすすめ イメージ写真を 全点見る 6
RE55009 NEW リフォームおすすめ
リフォームおすすめ RE55008
RE55010
リフォームおすすめ
Quiet Canvas
クワイエット キャンバス
自分だけの穏やかな空間を彩る、落ち着きのあるアースカラーのキャンバス。 繊細な織物のテクスチャーとアンティークな色合いが、静かに感性を刺激します。
準不燃
防火種別2-3 AA 1,090円/㎡ 巾92cm


RE55017
7
防かび
吸放湿 撥水 ストレッチ 撥水
抗菌 表面強化







nightfall history time dusk quiet blanc RE55016 RE55013 NEW RE55015 NEW リフォームおすすめ RE55017 NEW リフォームおすすめ RE55014 NEW RE55016 NEW リフォームおすすめ RE55018 NEW リフォームおすすめ リフォームおすすめ イメージ写真を 全点見る 8
Daily palette
生活の色彩
ささやかな日常の景色から生まれた
季節のカラーコレクション


[ P.
[ P. 13 - 14 ] 夏の畑 Autumn
[ P. 15 - 16 ] 秋の収穫 Winter
[ P. 17 - 18 ] 冬の森林
palette」の
9 Daily palette
Spring Nap
11 - 12 ] 春の昼寝 Summer Field
Harvest
Forest
「Daily
特設サイトはこちら。
Basic Color
ベーシックカラー
巾92cm 施工注意 濃色の商品は、ひっかきキズや糊の拭き残しにご注意ください。
※ それぞれのカラーに適したデザイン表現となっており、品番によってテクスチャーが若干異なります。



わた毛
イメージ写真を 全点見る

RE55024 (P.12)

RE55021
にゅうどう雲

RE55022
キャンバス



RE55023
雪だるま
RE55025 (P.12) NEW NEW
にわか雨

RE55036 (P.14)
リネン

RE55047 (P.16)
木枯らし

RE55057 (P.18) NEW
しんしん
RE55026 (P.12)
ヒヨドリ

RE55027 (P.12)
こかげ

RE55037 (P.14) NEW また明日
RE55038 (P.14) NEW
かげろう


RE55048 (P.16)
すすき
RE55058 (P.18) NEW NEW
RE55039 (P.14)
ひみつきち

足あと

RE55059 (P.18) NEW
しぐれ
※RE55021~RE55024 は、間接照明の場合など使用環境によって下地が目立つ商品です。入念な下地処理を行い、糊ダマリに注意して施工してください。 10 防火種別2-3 AA
準不燃 防かび 抗菌 吸放湿 撥水 Daily palette
1,090円/㎡


ふわふわ やわらかな
陽だまりに誘われて うとうとまどろむ午後
ゆったり流れる
わたしだけの時間
11 Daily palette
Spring Nap
春の昼寝
防火種別2-3 AA 1,090円/㎡ 準不燃 防かび 抗菌



吸放湿 撥水
春の昼寝 巾92cm 施工注意 濃色の商品は、ひっかきキズや糊の拭き残しにご注意ください。 ※ それぞれのカラーに適したデザイン表現となっており、品番によってテクスチャーが若干異なります。 イメージ写真を 全点見る









※RE55024は、間接照明の場合など使用環境によって下地が目立つ商品です。入念な下地処理を行い、糊ダマリに注意して施工してください。
NEW NEW NEW NEW NEW NEW NEW NEW NEW わた毛 RE55024 にわか雨 RE55025 ヒヨドリ RE55026 こかげ RE55027
RE55033 洗濯びより RE55034
RE55035 Spring
陽だまり RE55028 母の日 RE55029 まどろみ RE55030 花曇り RE55031 そよ風 RE55032 ピクニック
13:00
Nap
12
Daily palette
Summer Field
夏の畑


サワサワと風が運ぶ かわいた緑と土のにおい またねと手を振り 見えなくなっていく君 あしたもまた会えるかな
13 Daily palette
Summer Field
夏の畑


防火種別2-3 AA 1,090円/㎡ 準不燃
防かび 抗菌
吸放湿 撥水
巾92cm 施工注意 濃色の商品は、ひっかきキズや糊の拭き残しにご注意ください。
※ それぞれのカラーに適したデザイン表現となっており、品番によってテクスチャーが若干異なります。
イメージ写真を 全点見る



RE55028 (P.12)
陽だまり

ひぐらし

ひまわり


夏 至


木のぼり

リネン RE55036 かげろう RE55037 また明日 RE55038 ひみつきち RE55039
RE55040
RE55041
RE55042
RE55043 いぐさ RE55044 かえり道 RE55045 虫の声 RE55046 NEW NEW NEW NEW NEW NEW NEW NEW
14
Daily palette
Autumn Harvest
秋の収穫


実りの季節を迎えたら とれたて果実をことこと煮込む ぎっしりつまった
『ありがとう』の気持ち 大切なあの人におすそわけ
15 Daily palette

Autumn
Harvest 秋の収穫 木枯らし

お茶会

(P.12)

防火種別2-3 AA 1,090円/㎡ 準不燃 防かび 抗菌 吸放湿 撥水
巾92cm 施工注意 濃色の商品は、ひっかきキズや糊の拭き残しにご注意ください。 ※ それぞれのカラーに適したデザイン表現となっており、品番によってテクスチャーが若干異なります。
イメージ写真を 全点見る


RE55039 (P.14)



ジャム作り



RE55047 すすき RE55048 ひみつきち
十五夜 RE55049
RE55050 夕暮れ RE55051
RE55052
RE55053
もみじ狩り
RE55054 晩 餐 RE55055 さつまいも
NEW NEW NEW NEW NEW NEW
まどろみ RE55030
コスモス
RE55056
16
Daily palette
Winter Forest


凛と透きとおる空気が 窓の外にはりつめる しんしん深い雪の中
光も闇も冴えわたり わたしを包む 冬のいろ
冬の森林 17 Daily palette
Winter Forest
冬の森林




(P.12)
1,090円/㎡
巾92cm 施工注意 濃色の商品は、ひっかきキズや糊の拭き残しにご注意ください。 ※ それぞれのカラーに適したデザイン表現となっており、品番によってテクスチャーが若干異なります。








(P.12)
しんしん RE55057 足あと RE55058 しぐれ RE55059 冬 眠 RE55060
RE55061 冬
RE55062 もみの木 RE55063 13:00 RE55035
樹 氷 RE55064 湖 畔 RE55065 天体観測 RE55066 NEW NEW NEW NEW NEW
18
Daily palette
洗濯びより RE55034
しもばしら
至
イメージ写真を 全点見る
防火種別2-3 AA
準不燃 防かび 抗菌 吸放湿 撥水
process#100は「個性と洗練」をコンセプトに、 デザインから仕上げまで プロセスを大切につくられたサンゲツのプライベートブランド。
ゆるぎない美意識をもつ人々に、 洗練された上質な暮らしを提案します。

「process#100」の 特設サイトはこちら。
MISTY MEMORIE S
19
FLORAL MEMORY
[フローラル メモリー]
さまざまな花の表情をモチーフにデザインされた有機的なタイルのテクスチャー。 霞がかっ
た夢の中の庭園を思わせる透明感が魅力で、見る角度や照明により表情が豊かに変化します。

RE55071 NEW
準不燃
防火種別2-3 AA 1,090円/㎡
巾92.5cm ↕64cm ↕ 92.5cm
防かび 抗菌
▶ 施工注意
濃色の商品は、ひっかきキズや糊の拭き残しにご注意ください。

RE55072 NEW

RE55073 NEW

壁紙:RE55072 床材:IS-2072-A(2023-2026 FLOOR TILE)
イメージ写真を 全点見る 20
イメージ写真を
リフォームおすすめ
PLEUVOIR
[プルヴォワール]
縦に流れる抽象的な細石の表情。 穏やかに降る雨を彷彿とさせる無作為で繊細なニュア ンスが、 空間にさりげない個性を与えてくれます。

準不燃
防火種別2-3 AA 1,090円/㎡
巾92.5cm ↕64cm ↕ 92.5cm
防かび 抗菌
▶ 施工注意
濃色の商品は、ひっかきキズや糊の拭き残しにご注意ください。




 RE55076
RE55076
壁紙:RE55074 床材:IS-2153(2023-2026 FLOOR TILE)
NEW
NEW
RE55076 NEW リフォームおすすめ
RE55074
リフォームおすすめ RE55075
リフォームおすすめ
全点見る 21
ETHEREAL HARMONY
[エーセリアル ハーモニー]
星を散りばめたようなパールの煌めきと、 粒立ちの細かな石のテクスチャー。
リュクスな重厚感を醸し出す洗練されたデザインです。

RE55077 NEW

RE55078 NEW リフォームおすすめ
準不燃
防火種別2-3 AA 1,090円/㎡
巾92cm ↕64cm ↕ 92cm ● 無地貼可
防かび 抗菌
▶ 施工注意
濃色の商品は、ひっかきキズや糊の拭き残しにご注意ください。

RE55079 NEW リフォームおすすめ
SCANDEX ▶ LE KLINT / MUTATIO TABLE LAMP / https://www.leklint.jp/
 RE55079
RE55079
イメージ写真を 全点見る 22
リフォームおすすめ
POTTERY ESSENCE
[ポッタリー エッセンス]
陶芸家の製作した素焼きの陶器がモチーフの、工芸的な美しさと心地よさを感じるデザイン。
空間にそっと上質感をプラスしてくれます。





OMOBiTO ▶ MERIDIANI / RENÈ SOFA / https://meridiani.omobito.jp SCANDEX ▶ LE KLINT / CLASSIC TABLE LAMP MODEL 307 / https://www.leklint.jp
RE55082 RE55080 RE55082 NEW RE55080 NEW RE55081 NEW イメージ写真を 全点見る 23 防火種別2-3 AA 1,090円/㎡ 巾92.5cm ↕64cm ↕ 92.5cm エンボスリピート 防かび 抗菌 準不燃
LAYERED STRINGS
[レイヤード ストリングス]
光沢感がある上質な糸がいくつも重なりあった、深みのあるファブリックの素材感を再現。
リッチで心地よく、洗練された雰囲気を醸し出します。

RE55083 リフォームおすすめ
準不燃
防火種別2-3 AA 1,090円/㎡
巾92cm ↕64.1cm ↕ 92cm
防かび 抗菌

RE55084 NEW リフォームおすすめ

RE55085 NEW リフォームおすすめ リフォームおすすめ
OMOBiTO ▶ GERVASONI / INOUT43 (STOOL) / https://gervasoni.jp/
 RE55084
RE55084
イメージ写真を 全点見る 24
SERENITY SLATE
[セレニティ スレート]
天然の石の表面加工時にできる自然な流れのあるテクス チャー。シンプルな中にも豊かで繊細な表情があり、自然の 光や照明によってきれいな陰影が引き立つデザインです。



壁紙:RE55087 床材:IS-2072-A(2023-2026 FLOOR TILE) RE55086 NEW リフォームおすすめ RE55087 NEW リフォームおすすめ リフォームおすすめ イメージ写真を 全点見る 25 防火種別2-3 AA 1,090円/㎡ 巾92.5cm ↕64.2cm ↕ 92.5cm エンボスリピート 防かび 抗菌 準不燃
GENTLE LOUVER
[ジェントル ルーバー]
よろい窓のルーバーを想起させる、ライン状のエンボスが 印象的な柄。幾何学状の大きなパターンと落ち着きのある カラーリングで上質感を演出します。

RE55088

RE55089
準不燃
防火種別2-3 AA 1,090円/㎡ 巾92.5cm ↕92.5cm ↕ 92.5cm エンボスリピート 防かび 抗菌 ※製法やデザインの特性により、ジョイント部分を正確に合わせることが困難です。


RE55089・55081
イメージ写真を 全点見る 26

壁紙:RE55024・55241
床材:WD-2040-W(2023-2026 FLOOR TILE)
RE55756・55229

カラーパレット
Light beige

RE55024(P.12)

RE55751(P.170)

RE55141(P.47) ルームエアー(消臭)

RE55151(P.49) ルームエアー(消臭)

RE55117(P.42)

RE55752(P.170)

RE55023(P.10)

RE55036(P.14)

RE55092(P.35) ハードストレッチ壁紙

RE55096(P.36)

RE55021(P.10)

RE55131(P.45)

RE55121(P.43)

RE55047(P.16)

RE55755(P.170)

RE55611(P.137) ウレタンコート壁紙

RE55111(P.41) ルームエアー(消臭)

RE55102(P.37)

RE55136(P.46)

RE55756(P.170)
27
Beige / Brown

RE55152(P.49) ルームエアー(消臭)

RE55037(P.14)

RE55097(P.36)



RE55127(P.44)

RE55091(P.35) ハードストレッチ壁紙

RE55038(P.14)



RE55128(P.44)

RE55004(P.4)

RE55129(P.44)



RE55048(P.16)


RE55614(P.137) ウレタンコート壁紙



 RE55614
RE55152
RE55614
RE55152
RE55100
RE55757(P.170) RE55095(P.35) ハードストレッチ壁紙 RE55619(P.138)
(P.36)
RE55126(P.44) RE55049(P.16)
RE55039(P.14) RE55159(P.50) ウレタンコート壁紙
RE55104(P.37)
28 カラーパレット

壁紙:RE55113・55111
床材:WD-2013(2023-2026 FLOOR TILE)


RE55022(P.10)

RE55025(P.12)

RE55101(P.37)

RE55112(P.41) ルームエアー(消臭)

RE55383(P.99) ライトフレッシュ壁紙

RE55001(P.4)

RE55753(P.170)

RE55026(P.12)

RE55157(P.50) ウレタンコート壁紙

RE55618(P.138)

RE55617(P.138)

RE55057(P.18)

RE55058(P.18)

RE55113(P.41) ルームエアー(消臭)

RE55059(P.18)

RE55397(P.102) ライトフレッシュ壁紙

RE55106(P.38)

RE55613(P.137) ウレタンコート壁紙

RE55118(P.42)

RE55615(P.137) ウレタンコート壁紙
RE55022
29
Light gray
Gray / Black

RE55398(P.102) ライトフレッシュ壁紙

RE55003(P.4)

RE55260 (P.78) ハードストレッチ壁紙

(P.46)


RE55139(P.46)

RE55107(P.38)

RE55108(P.38)




RE55754(P.170)


RE55027(P.12)


RE55119(P.42)






RE55135・55131
RE55754
RE55109(P.38)
RE55140
RE55616(P.137)
ウレタンコート壁紙
ウレタンコート壁紙
RE55085(P.24) RE55160 (P.50)
RE55110 (P.38) RE55135(P.45)
ルームエアー(消臭)
RE55622(P.138) RE55115(P.41)
RE55758(P.170)
RE55114(P.41) ルームエアー(消臭)
30 カラーパレット

RE55122
RE55147・55242

Yellow / Orange

RE55028(P.12)

RE55153(P.49) ルームエアー(消臭)

RE55143(P.47) ルームエアー(消臭)

RE55303(P.85) ウレタンコート壁紙

RE55041(P.14)

RE55540 (P.123) 吸放湿壁紙

RE55123(P.43)

RE55534(P.122) 吸放湿壁紙

RE55040 (P.14)

RE55042(P.14)

RE55175(P.55)

RE55124(P.43)

RE55147(P.48) ウレタンコート壁紙

RE55154(P.49) ルームエアー(消臭)

RE55120 (P.42)

RE55122(P.43)

RE55094(P.35) ハードストレッチ壁紙

RE55125(P.43)

RE55130 (P.44)

RE55399(P.102) ライトフレッシュ壁紙
31

RE55541(P.123) 吸放湿壁紙 Red / Purple

RE55050 (P.16)

RE55051(P.16)


(P.138)

RE55029(P.12)

RE55142(P.47) ルームエアー(消臭)

RE55146(P.48) ウレタンコート壁紙

吸放湿壁紙


RE55137(P.46)

RE55054(P.16)

RE55103(P.37)



(P.12)


吸放湿壁紙




RE55052 RE55054・55057
RE55542(P.123)
RE55052(P.16)
RE55620
RE55532(P.122)
RE55053(P.16)
RE55055(P.16)
RE55134(P.45)
RE55762(P.170)
RE55056(P.16)
RE55031(P.12)
RE55030
32 カラーパレット



RE55032(P.12)

RE55043(P.14)

RE55044(P.14)

RE55093(P.35) ハードストレッチ壁紙

RE55045(P.14)

RE55384(P.99) ライトフレッシュ壁紙

RE55759(P.170)

RE55149(P.48) ウレタンコート壁紙

RE55155(P.49) ルームエアー(消臭)

RE55046(P.14)

RE55033(P.12)

RE55144(P.47) ルームエアー(消臭)

RE55535(P.122) 吸放湿壁紙

RE55150 (P.48) ウレタンコート壁紙

RE55116(P.42)

RE55138(P.46)

RE55132(P.45)

RE55148(P.48) ウレタンコート壁紙

RE55006(P.4)

RE55063(P.18)
RE55046
RE55132
33
Green

RE55538(P.123) 吸放湿壁紙

RE55158(P.50) ウレタンコート壁紙

RE55621(P.138)

RE55062(P.18)


RE55760 (P.170)

RE55061(P.18)

RE55133(P.45)

RE55156(P.50) ウレタンコート壁紙


RE55034(P.12)

RE55105(P.37)

RE55064(P.18)

RE55079(P.22)

(P.18)

RE55035(P.12)

RE55145(P.47) ルームエアー(消臭)

RE55761(P.170)



RE55133・55131
 RE55066
RE55099(P.36)
RE55098(P.36)
RE55060
RE55065(P.18)
RE55066(P.18)
RE55066
RE55099(P.36)
RE55098(P.36)
RE55060
RE55065(P.18)
RE55066(P.18)
Blue 34 カラーパレット
カラーセレクション
壁紙:RE55093・55229
RE55091 NEW ハードストレッチ
ハードストレッチ
ハードストレッチ



RE55092 NEW

RE55093 NEW
準不燃
ハードストレッチ

RE55094 NEW
ハードストレッチ

RE55095 NEW
防火種別2-3 AA 1,090円/㎡ 巾92cm ↕64cm ↕ 92cm エンボスリピート 防かび 抗菌 表面強化 吸放湿 撥水 ストレッチ 撥水 ▶ 施工注意 入念な下地処理を行い、糊ダマリに注意して施工してください。 糊付け後は大きくたたみ、折りジワに注意して、上積みは避けてください。 濃色の商品は、ひっかきキズや糊の拭き残しにご注意ください。
ナチュラルな空間に仕上げてくれる塗り調の壁紙。 トレンド感あふれるアースカラーの5配色です。
床材:WD-2051(2023-2026 FLOOR TILE)
イメージ写真を 全点見る 35

RE55096 NEW


RE55097 NEW


準不燃
防火種別2-3 AA 1,090円/㎡ 巾92cm
防かび 抗菌
▶ 施工注意
濃色の商品は、ひっかきキズや糊の拭き残しにご注意ください。
商品特性上、ベース原反に着色をしていないため、施工環境、条件、品番によってジョイント部分が白いライン状に目立ちます。
また断面がより目立ちやすくなるため、突き付けでの施工を避け、重ね切りで施工してください。
重ね切り施工時、カッターが斜めに入るとカット断面が目立ちやすくなるため、必ず垂直に入れていただき、また、下地を切らないよう にご注意ください。
特に濃色の商品については、目立ちやすくなるためご注意ください。
さりげなく光るパールがアクセントのシックな5配色。 クセが無く、さまざまなテイストの空間とマッチします。
 RE55098 NEW
RE55099 NEW
RE55098 NEW
RE55099 NEW
RE55096・55098 イメージ写真を 全点見る 36
RE55100 NEW
カラー セレクション

RE55101 NEW

RE55102 NEW


RE55103 NEW RE55104 NEW RE55105 NEW
準不燃
防火種別2-3 AA 1,090円/㎡ 巾92cm 防かび 抗菌
繊細なシルバーラメが上品に輝く石目調。 エレガントやライトモダンにもお使いいただけます。


RE55103・55243 イメージ写真を 全点見る 37
カラーセレクション
壁紙:RE55107・55181
カーテン:AC2296(2023-2026 AC)
床材:WD-2075(2023-2026 FLOOR


RE55106 NEW リフォームおすすめ

RE55107 NEW リフォームおすすめ

RE55108 NEW リフォームおすすめ
準不燃
防火種別2-3 AA 1,090円/㎡
巾92cm ↕23cm ↕ 46.2cm
防かび 抗菌
▶ 施工注意
濃色の商品は、ひっかきキズや糊の拭き残しにご注意ください。
何層にも重なった織物のテクスチャーが、 奥行きを感じさせる縦流れのデザイン。

RE55109 NEW リフォームおすすめ

RE55110 NEW リフォームおすすめ
TILE)
イメージ写真を 全点見る 38
リフォームおすすめ
カラーセレクション カラー セレクション


RE55611 (P.137 )

RE55613 (P.137 )

RE55614 (P.137 ) ロングセラー
準不燃

RE55615 (P.137 )

RE55616 (P.137 ) ロングセラー
モヤががったニュアンスが特徴のコンクリート調壁紙。 上質な素材感が、ワンランク上の空間に仕上げてくれます。
品番が青字の商品は別のページにも掲載があります。
ウレタンコート
ウレタンコート
ウレタンコート
ウレタンコート
ウレタンコート 壁紙:RE55613・55229 床材:IS-2071-B・WD-2138(2023-2026 FLOOR TILE) ロングセラー イメージ写真を 全点見る 39
表面強化 抗ウイルス ウレタンコ ト
撥水
防火種別2-3 AA 1,090円/㎡ 巾92cm ↕64cm ↕ 92cm 防かび 抗菌
吸放湿




リフォームおすすめ

準不燃
防火種別2-3 AA 1,090円/㎡ 巾92cm ↕63.8cm ↕ 92cm 防かび 抗菌 吸放湿 撥水 ▶ 施工注意 濃色の商品は、ひっかきキズや糊の拭き残しにご注意ください。
MOTTLED RUST
まだらに覆われた「錆」がモチーフのデザイン。 日常ではネガティブに感じられる錆も、静謐で美しい魅力を内包しています。 錆の立体感と艶感の異なる質感が入り混じった表情を、繊細なプリントと特殊配合 のハードなテクスチャーによって実現しています。
MIKIYA KOBAYASHI/小林幹也
1981年東京都生まれ。2005年武蔵野美術大学工芸工業デザイン学科卒業。インテリ アデザイン会社勤務後、株式会社小林幹也スタジオ設立。家具、プロダクト、テキスタイ ル、モビリティからインテリアデザインまで幅広く携わり、国内外のクライアントとともに デザインを提案している。
品番が青字の商品は別のページにも掲載があります。


壁紙:RE55621 床材:IS-2071-B(2023-2026 FLOOR TILE)
RE55619 (P.138) NEW リフォームおすすめ
RE55617 (P.138) NEW リフォームおすすめ
RE55620 (P.138) NEW
RE55621 (P.138) NEW リフォームおすすめ
イメージ写真を 全点見る 40
RE55622 (P.138) NEW リフォームおすすめ
リフォームおすすめ
カラー セレクション
ルームエアー(消臭)



準不燃
防火種別2-3 AA 1,090円/㎡ 巾92cm ↕32.1cm ↕ 30.8cm エンボスリピート 防かび 抗菌 消臭
ルームエアー(消臭)

ルームエアー(消臭)

繊細な織目の入ったシャープな布地を表現した壁紙です。 壁面を落ち着いたグレーで統一して、クールモダンなお部屋を実現。
 RE55112
RE55111
RE55112
RE55111
ルームエアー(消臭)
RE55113
ルームエアー(消臭)
RE55114
RE55115
壁紙:RE55111・55113・55237 床材:WD-2068(2023-2026 FLOOR TILE) イメージ写真を 全点見る 41
カラーセレクション






準不燃
防火種別2-3 AA 1,090円/㎡
巾92cm ↕32cm ↕ 46cm ● 無地貼可
防かび 抗菌
吸放湿 撥水
パールがほのかにきらめくシックな織物調です。
書斎など、大人っぽい雰囲気を演出したい空間にもおすすめ。
RE55117
RE55116
RE55118
RE55119
壁紙:RE55117・55120 床材:WD-2074(2023-2026
TILE) イメージ写真を 全点見る 42
RE55120
FLOOR
カラーセレクション カラー セレクション






NEW
準不燃
防火種別2-3 AA 1,080円/㎡ 巾93cm ↕31.5cm ↕ 62cm エンボスリピート ● ステップ柄合せ 防かび 抗菌
吸放湿 撥水
人気のスタッコ調にテラコッタカラーを追加。 ヨーロピアンテイストの空間によく合います。
RE55122
ロングセラ
RE55121 ロングセラ
ロングセラー イメージ写真を 全点見る 43
RE55123 ロングセラー RE55124 ロングセラ RE55125
壁紙:RE55125・55121・55229





準不燃
防火種別2-3 AA 1,090円/㎡ 巾92.5cm ↕64.2cm ↕ 92.5cm 防かび 抗菌 ▶ 施工注意 濃色の商品は、ひっかきキズや糊の拭き残しにご注意ください。
古い羊皮紙をイメージした壁紙。アンティークな 質感が、雰囲気を高めてくれます。
 RE55127 NEW
RE55126 NEW
RE55128 NEW
RE55129 NEW
RE55127 NEW
RE55126 NEW
RE55128 NEW
RE55129 NEW
壁紙:RE55129・55127・55229 モールド:MM84・88・89 床材:WD-2137(2023-2026 FLOOR TILE) イメージ写真を 全点見る 44
RE55130 NEW
カラー セレクション





準不燃
防火種別2-3 AA 1,090円/㎡ 巾92.5cm ↕23cm ↕ 46.3cm ● 無地貼可 防かび 抗菌
はっきりとしたカラーが美しい織物調壁紙。 照明が当たるとシルバーのラメがキラキラと輝きます。
 RE55132
RE55131
RE55133
RE55134
RE55132
RE55131
RE55133
RE55134
RE55134 イメージ写真を 全点見る 45
RE55135
カラーセレクション

RE55137

リフォームおすすめ
壁紙:RE55136・55139
床材:WD-2085(2023-2026 FLOOR TILE)


RE55137 リフォームおすすめ

RE55138 リフォームおすすめ
準不燃
防火種別2-3 AA 1,090円/㎡
巾92cm ↕32.1cm ↕ 30.8cm
防かび 抗菌
▶ 施工注意 濃色の商品は、ひっかきキズや糊の拭き残しにご注意ください。
ラメを贅沢に使った高級感のある織物調壁紙。 エレガントなお部屋におすすめです。

RE55139 リフォームおすすめ

RE55140 リフォームおすすめ
RE55136
リフォームおすすめ イメージ写真を 全点見る 46
カラーセレクション カラー セレクション
ルームエアー(消臭)
ルームエアー(消臭)
壁紙:RE55145・55778
床材:WD-2128(2023-2026 FLOOR TILE)


RE55141

RE55142

RE55143
準不燃
防火種別2-3 AA 1,090円/㎡ 巾92cm 防かび 抗菌 消臭
ルームエアー(消臭)

RE55144
ルームエアー(消臭)

RE55145
さわやかな塗り調の壁紙。 消臭機能付きなので、ニオイが気になる場所にもおすすめです。
ルームエアー(消臭)
イメージ写真を 全点見る 47
ウレタンコート

ウレタンコート RE55146 リフォームおすすめ


ウレタンコート
RE55147 リフォームおすすめ


RE55148 リフォームおすすめ
準不燃
防火種別2-3 AA 1,090円/㎡ 巾92cm ↕30.6cm ↕ 46cm エンボスリピート 防かび 表面強化 抗ウイルス ウレタンコ ト
カラフルで可愛いらしい塗り調の壁紙です。 ウレタンコート機能付きでキズや汚れに強く、 ニッチのアクセントにもお使いいただけます。


壁紙:RE55146・55149・55024 床材:WD-2018(2023-2026 FLOOR TILE)
イメージ写真を 全点見る 48
RE55149 リフォームおすすめ ウレタンコート RE55150 リフォームおすすめ ウレタンコート
RE55147・55148・55021・K304(サンマグネシタジ) リフォームおすすめ
カラー セレクション
イメージ写真を
ルームエアー(消臭)

ルームエアー(消臭)

RE55152 リフォームおすすめ
ルームエアー(消臭)

RE55153 リフォームおすすめ
準不燃
防火種別2-3 AA 1,090円/㎡ 巾92cm ↕32.1cm ↕ 46.2cm 防かび 抗菌 消臭
ざっくりとした麻袋がモチーフの温かみのあるデ ザイン。ナチュラルなお部屋にぴったりです。
リフォームおすすめ

RE55154 NEW リフォームおすすめ ルームエアー(消臭)

RE55155 リフォームおすすめ ルームエアー(消臭)

床材:WD-2029(2023-2026 FLOOR TILE)
RE55151
壁紙:RE55154・55151・55181
全点見る 49
カラーセレクション






リフォームおすすめ ウレタンコート
RE55157
リフォームおすすめ ウレタンコート
リフォームおすすめ ウレタンコート RE55159 NEW リフォームおすすめ ウレタンコート RE55160 NEW リフォームおすすめ ウレタンコート 壁紙:RE55158・55181 床材:WD-2137(2023-2026 FLOOR TILE) リフォームおすすめ イメージ写真を 全点見る 50 防火種別2-3 AA 1,090円/㎡ 巾92cm ↕64.1cm ↕ 92cm 防かび 抗菌 表面強化 抗ウイルス ウレタンコ ト 吸放湿 撥水 準不燃 洗いざらしのデニムをイメージしたデザイン。 かすれた質感が、ヴィンテージな雰囲気を高めてくれます。 カラーセレクション カラー セレクション
RE55156
RE55158
壁紙 選び 方
お部屋の中で一番面積が広い壁紙は、インテリアのイメージを左右する重要なアイテムです。
ここでは壁紙選びのポイントをご紹介します。
どのようなお部屋にしたいかイメージする
お部屋での過ごし方や、身のまわりの家具、雑貨などをイメージ。
自分のライフスタイルに合わせてインテリアスタイルを決めましょう。
シンプルですっきりしたお部屋で過ごしたい方には…
シンプルモダン ジャパンディ


床材やドアの色調と合わせて基本色を決める
木目の色調は、赤味、黄味、グレー味のあるものなど、さまざまです。
壁紙の基本色を木目の色調に合わせることで、お部屋に統一感が生まれます。
ホワイト・グレー色の床 ライト・ナチュラル色の床 ミディアム・ダーク色の床






ホワイト系の壁紙 ベージュ系の壁紙 グレー系の壁紙 自分のお気に入りの空間で過ごしたい方には…
インダストリアル エレガント


ナチュラル、モダン、エレガントなど、インテリアスタイルの 種類は多様です。リザーブ巻頭に付属の「インテリアスタイル ブック」は、9つのインテリアスタイルを収録した写真集です。
こちらを参考に、お気に入りのスタイルを探してみるのもお すすめです。












ONE POINT !
床、壁、天井の色のバランスを考えましょう
①床→②壁→③天井の順に、上にいくほど 明るくすると天井が高く広く感じられます。 広く見せたい玄関やリビングは明るい色の 天井を選びましょう。逆に、天井を一段暗く すると、空間に落ち着きがでます。寝室や 書斎など、リラックスして過ごしたいお部屋 におすすめのコーディネートです。

インテリアスタイルブック WEB版はこちら。
たとえば…
1 2 3 51
ベースクロスを選ぶ
お部屋の大部分を占めるベースクロス。
大きく分けると、石目調と織物調のデザインがあります。
テクスチャー によってお部屋の雰囲気が変わるので 、インテリアに あわせてお好みのものを選びましょう。
石目調 ]
おだやかなテクスチャ はっきりとしたコテ跡 ごつごつとしたラフな塗り



シンプルモダンにおすすめ ナチュラルにおすすめ ビンテージにおすすめ



織物調 ]
シンプルですっきりとした織り ざっくりとした質感 パールやラメが入ったもの



ベーシックにおすすめ ナチュラル・和におすすめ エレガントにおすすめ



また、お部屋の用途やシーンに合わせた機能を選ぶことで、 より快適なお 部屋 づくりができます。汚れが落ちやすい、 キズがつきにくい機能など、お手入れのしやすさにも着目し てみましょう。機能性についてはP.67~70をご覧ください。

アクセントクロスを取り入れる
ア クセ ントクロ ス の種類
ワンランク上のインテリアを楽しみたいなら、アクセントクロスを 取り入れてみては。アクセントクロスにはさまざまなバリエーションがあります。 お好みの壁紙を選びましょう。



ア クセ ントクロス を貼る部屋や位置を考える
アクセントクロスを取り入れることで、お部屋の雰囲気がガラっと変わります。 貼る場所や面積を考えながら取り入れましょう。

ト イレの1面 キッチ ンのカップボード奥 寝 室のベ ッド ヘ ッド面



/ P.53・73 / P.43 / P.54・126 P.9 、P.35 P.129 P.185 / P.81 / P.125 / P.46 RE55122 RE55553
RE55229
収 納の中
RE55269
RE55548 RE55139
カラー マテリアル パターン
52
[
[
壁紙の選び方
ハードストレッチ(消臭)
ベーシックセレクション
シンプルで使いやすいものからデザイン性の高いものまで こだわりのベース向けの壁紙をラインアップ。
豊富なバリエーションの中からお選びいただけます。

厚みのある壁紙は下地の凹凸が目立ちにくくきれいに貼り上が るので、リフォームにもおすすめです。
厚みと不陸隠蔽性の自社基準に適合したリフォーム推奨品は リフォームおすすめ マークでご確認ください。
ハードストレッチ(消臭) リフォーム推奨品で仕上がりきれい
ハードストレッチ(消臭)

(P.73) リフォームおすすめ
防火種別2-3 AA 1,090円/㎡ 巾92.5cm ↕31.5cm ↕ 46.4cm エンボスリピート ● 無地貼可 防かび 抗菌 表面強化 消臭 吸放湿 撥水 ストレッチ 撥水 準不燃

ハードストレッチ(消臭)

(P.73) リフォームおすすめ

(P.73) リフォームおすすめ

(P.73) リフォームおすすめ
品番が青字の商品は別のページにも掲載があります。
RE55229
RE55230
RE55231
RE55232
RE55229・55232
リフォームおすすめ
53
イメージ写真を 全点見る
抗ウイルス
ハードストレッチ(消臭)

RE55245 (P.75)
準不燃
巾92cm
防火種別2-3 AA 1,090円/㎡
防かび 抗菌 表面強化 消臭 吸放湿 撥水 ストレッチ 撥水

RE55246 (P.75) リフォームおすすめ

RE55171 リフォームおすすめ
準不燃
防火種別2-3 AA 1,090円/㎡
巾92cm ↕32cm ↕ 92cm
防かび 抗菌

RE55172 リフォームおすすめ
抗ウイルス

RE55389 (P.100) NEW
準不燃
防火種別2-3 AA 1,090円/㎡
巾92.5cm ↕31.4cm ↕ 46.3cm エンボスリピート 防かび 抗菌 通気性 抗ウイルス

RE55390 (P.100) NEW
吸放湿

RE55553 (P.126) リフォームおすすめ
準不燃
巾92cm
防火種別2-3 AA 1,090円/㎡
防かび 吸放湿 ウレタンコ ト
吸放湿

RE55554 (P.126) リフォームおすすめ
※親水性高分子ポリマーが空気中や接着剤の水分を吸収し、白い粉末状となって撫で刷毛等に付着することがありますが、 品質や性能には問題ございません。
品番が青字の商品は別のページにも掲載があります。
ハードストレッチ(消臭)
ロングセラ
ロングセラー
イメージ写真を 全点見る 54
リフォームおすすめ
ベーシックセレクション
ベーシックセレクション
ただけます。

壁紙:RE55226 床材:WD-2031-W(2023-2026 FLOOR TILE)
準不燃 ほどよく表情のある石目調にシルバーのラメを施した商品。
RE55174 リフォームおすすめ


リフォームおすすめ


リフォームおすすめ
防火種別2-3 AA 1,090円/㎡ 巾92cm ↕29.3cm ↕ 46.2cm エンボスリピート ● 無地貼可 防かび 抗菌

リフォームおすすめ RE55176 リフォームおすすめ
RE55173
RE55174
RE55175
イメージ写真を 全点見る 55
モダン、和、エレガントなどさまざまなテイストにお使いい
ハードストレッチ
ハードストレッチ
ハードストレッチ

RE55221 (P.72) NEW リフォームおすすめ
準不燃
巾92cm
防火種別2-3 AA 1,090円/㎡
防かび 抗菌 表面強化 吸放湿 撥水 ストレッチ 撥水

RE55225 (P.72) NEW リフォームおすすめ
準不燃

RE55222 (P.72) NEW リフォームおすすめ

ざっくりとしたラフな横流れは、 空間のリラックス感を高めてくれます。


RE55177・55178

ハードストレッチ RE55177 リフォームおすすめ RE55178 リフォームおすすめ
防火種別2-3 AA 1,090円/㎡
巾92.5cm ↕63.9cm ↕ 92.5cm エンボスリピート 防かび 抗菌 表面強化 吸放湿 撥水 ストレッチ 撥水
品番が青字の商品は別のページにも掲載があります。
RE55226 (P.72) NEW リフォームおすすめ
準不燃
防火種別2-3 AA 1,090円/㎡ 巾92.5cm ↕32.1cm ↕ 92.5cm エンボスリピート 防かび 抗菌
リフォームおすすめ
イメージ写真を 全点見る 56
ベーシックセレクション

ハードストレッチ
ハードストレッチ

RE55269 (P.81) リフォームおすすめ
準不燃
巾92cm
防火種別2-3 AA 1,090円/㎡
防かび 抗菌 表面強化 吸放湿 撥水 ストレッチ 撥水
抗アレル
品番が青字の商品は別のページにも掲載があります。

RE55271 (P.81) リフォームおすすめ

RE55365 (P.96) リフォームおすすめ
準不燃
巾92cm
準不燃 厚みのある織物調壁紙。さりげなく輝くラメが魅 力的です。
防火種別2-3 AA 1,090円/㎡
防かび 消臭 抗 アレ ル

RE55179 リフォームおすすめ
巾92cm
防火種別2-3 AA 1,090円/㎡
防かび 抗菌

RE55366 (P.96) リフォームおすすめ 抗アレル

RE55180 リフォームおすすめ
イメージ写真を 全点見る 57
RE55180
リフォームおすすめ
ハードストレッチ

RE55181 リフォームおすすめ
準不燃
巾92cm
防かび
防火種別2-3 AA 1,090円/㎡

RE55182 リフォームおすすめ

ハードストレッチ

RE55258 (P.78) NEW
準不燃
巾92cm
防火種別2-3 AA 1,090円/㎡
防かび 抗菌 表面強化 吸放湿 撥水 ストレッチ 撥水
▶ 施工注意
入念な下地処理を行い、糊ダマリに注意して施工してください。
糊付け後は大きくたたみ、折りジワに注意して、上積みは避けてください。
ハードストレッチ(消臭)

RE55259 (P.78) NEW
品番が青字の商品は別のページにも掲載があります。
ハードストレッチ(消臭)

RE55183 NEW リフォームおすすめ
準不燃
防火種別2-3 AA 1,090円/㎡
巾92.5cm ↕32cm ↕ 46.4cm

RE55184 NEW リフォームおすすめ
撥水
防かび 抗菌 表面強化 消臭 吸放湿 撥水 ストレッチ
ナチュラルにも和テイストにも合わせやすい織物調壁紙。 リネンのような繊細な織目が魅力です。
イメージ写真を 全点見る 58
RE55184
リフォームおすすめ
ベーシックセレクション



防火種別2-3 AA 1,090円/㎡ 巾92.4cm ↕2.1cm ↕ 2.2cm



準不燃
防火種別2-3 AA 1,090円/㎡ 巾92cm ↕2cm ↕ 2.9cm
RE55185 ロングセラ RE55186 ロングセラ RE55187 リフォームおすすめ ロングセラ RE55188 リフォームおすすめ ロングセラ
RE55187
ロングセラー リフォームおすすめ イメージ写真を 全点見る 59
RE55186
防かび
準不燃
防かび
抗菌


準不燃
防火種別2-3 AA 1,090円/㎡
巾92cm ↕32cm ↕ 92cm 防かび 抗菌






準不燃
防火種別2-3 AA 1,090円/㎡
巾92cm ↕32cm ↕ 46cm 防かび 抗菌
準不燃
防火種別2-3 AA 1,090円/㎡
巾92cm ↕12.8cm ↕ 13.2cm 防かび
準不燃
防火種別2-3 AA 1,090円/㎡
巾92cm ↕23cm ↕ 46.2cm 防かび 抗菌
品番が青字の商品は別のページにも掲載があります。 RE55189 リフォームおすすめ ロングセラ RE55190 リフォームおすすめ ロングセラ RE55191 リフォームおすすめ ロングセラ RE55106 (P.38) NEW リフォームおすすめ
RE55106
RE55191
RE55190
ロングセラー リフォームおすすめ イメージ写真を 全点見る 60
RE55189
ベーシックセレクション



準不燃
防火種別2-3 AA 1,090円/㎡ 巾92cm ↕32.1cm ↕ 92cm エンボスリピート ● 無地貼可 防かび 抗菌 表面強化 吸放湿 撥水


準不燃
防火種別2-3 AA 1,090円/㎡
ウレタンコ ト
巾92.5cm ↕32cm ↕ 92.5cm エンボスリピート 防かび 吸放湿
※親水性高分子ポリマーが空気中や接着剤の水分を吸収し、白 い粉末状となって撫で刷毛等に付着することがありますが、 品質や性能には問題ございません。


準不燃
防火種別2-3 AA 1,090円/㎡ 巾92cm ↕32cm ↕ 46.2cm 防かび 抗菌

準不燃
防火種別2-3 AA 1,090円/㎡
ウレタンコ ト
巾92cm ↕21cm ↕ 18.5cm エンボスリピート 防かび 吸放湿
※親水性高分子ポリマーが空気中や接着剤の水分を吸収し、白 い粉末状となって撫で刷毛等に付着することがありますが、 品質や性能には問題ございません。
品番が青字の商品は別のページにも掲載があります。
吸放湿
リフォームおすすめ ロングセラ
ロングセラ 吸放湿
RE55192
リフォームおすすめ RE55545 (P.124)
RE55193
RE55546 (P.124)
RE55546
RE55193
RE55545
ロングセラー リフォームおすすめ イメージ写真を 全点見る 61
RE55192
プロジェクター用壁紙
プロジェクターの映像がきれいに映る
P O N T
映 像 の 再現 性 が 高 い
画像や文字の歪みが少なく、映像の再現性に 優れ、正面はもちろん、斜めからでもきれいな 映像を見ることができます。
[視野角160度以上]
● プロジェクター投映適性
壁紙 文字 画像 動画
プロジェクター用壁紙 ◎ ○ ○
一般ビニル壁紙 △ △ × ※投映した画像の品質は、下地の状態やプロジェクターの種類、投映環境によって異なります。 また、壁紙のジョイント部分では文字や画像が若干ずれて見える場合があります。 ※下地に配慮した施工を行うため、施工費が割増しになる場合があります。

ルームエアー(消臭)

準不燃
巾92cm
防火種別2-3 AA 1,090円/㎡
防かび 抗菌 吸放湿 撥水
▶
施工注意
間接照明の場合など使用環境によって下地が目立つ商品です。
入念な下地処理を行い、糊ダマリに注意して施工してください。

NEW
準不燃
防火種別2-3 AA 1,090円/㎡ 巾92cm
防かび 抗菌

準不燃
防火種別2-3 AA 1,090円/㎡ 巾92.5cm
防かび 抗菌 消臭

NEW
準不燃
防火種別2-3 AA 1,090円/㎡ 巾92cm 防かび 抗菌
プロジェクター
品番が青字の商品は別のページにも掲載があります。
RE55021 (P.10)
RE55859 (P.196)
RE55194
RE55195
RE55194 イメージ写真を 全点見る 62
間接照明におすすめ
P63~64に掲載している商品は、 特に下地の凹凸が目立ちにくく、 間接照明のある空間にも おすすめの商品です。
ハードストレッチ(消臭)

RE55202

ハードストレッチ(消臭)

RE55241 (P.75) リフォームおすすめ
準不燃
防火種別2-3 AA 1,090円/㎡ 巾92cm
防かび 抗菌 表面強化 消臭
ハードストレッチ(消臭)
RE55568
ハードストレッチ

RE55242 (P.75) リフォームおすすめ
吸放湿 撥水 ストレッチ 撥水

RE55544 (P.124) リフォームおすすめ
準不燃
巾92cm
防火種別2-3 AA 1,090円/㎡
ウレタンコ ト
防かび 吸放湿
※親水性高分子ポリマーが空気中や接着剤の水分を吸収し、白 い粉末状となって撫で刷毛等に付着することがありますが、 品質や性能には問題ございません。
ハードストレッチ

RE55270 (P.81) リフォームおすすめ
準不燃
巾92cm
防火種別2-3 AA 1,090円/㎡
防かび 抗菌 表面強化

RE55246 (P.75) リフォームおすすめ
準不燃
巾92cm
撥水
防火種別2-3 AA 1,090円/㎡
防かび 抗菌 表面強化 消臭
ストレッチ
吸放湿 撥水

RE55271 (P.81) リフォームおすすめ
撥水
吸放湿 撥水 ストレッチ
品番が青字の商品は別のページにも掲載があります。
吸放湿
全点見る 63
リフォームおすすめ イメージ写真を
天井 天 井

RE55201 リフォームおすすめ
準不燃
防火種別2-3 AA 1,090円/㎡ 巾92cm
防かび 抗菌 表面強化 消臭 吸放湿 撥水 ストレッチ 撥水

RE55202 リフォームおすすめ ロングセラ
準不燃
防火種別2-3 AA 1,090円/㎡
巾92cm 防かび 抗菌

RE55243 (P.75) リフォームおすすめ
準不燃
防火種別2-3 AA 1,090円/㎡ 巾92cm
防かび 抗菌 表面強化 消臭 吸放湿 撥水 ストレッチ 撥水

RE55203 リフォームおすすめ 通気性
準不燃
防火種別2-3 AA 1,090円/㎡
抗 アレ ル
巾92cm ↕21.3cm ↕ 23.1cm ● 無地貼可 防かび 通気性
▶ 選択上の注意

RE55205 リフォームおすすめ
準不燃
防火種別2-3 AA 1,090円/㎡
巾92.5cm ↕32cm ↕ 46.3cm エンボスリピート ● 無地貼可 防かび 抗菌 消臭

RE55204 リフォームおすすめ
準不燃
防火種別2-3 AA 1,090円/㎡
抗 アレ ル
巾92cm ↕21.3cm ↕ 46.2cm
防かび 通気性
▶ 選択上の注意

RE55206 リフォームおすすめ
準不燃
防火種別2-3 AA 1,090円/㎡
巾92cm ↕32cm ↕ 23cm
防かび 抗菌
RE55244 (P.75) リフォームおすすめ ハードストレッチ(消臭)

RE55207 リフォームおすすめ ロングセラ
準不燃
防火種別2-3 AA 1,090円/㎡
巾92.5cm ↕3.4cm ↕ 2.9cm 防かび

RE55208 リフォームおすすめ
準不燃


RE55568 (P.128) リフォームおすすめ ロングセラ
準不燃
防火種別2-3 AA 1,090円/㎡
抗 アレ ル
巾92cm ↕32cm ↕ 30.8cm 防かび 通気性
▶ 選択上の注意

RE55240 (P.74) リフォームおすすめ ハードストレッチ
防火種別2-3 AA 1,090円/㎡
抗 アレ ル
巾92cm ↕32.2cm ↕ 46.2cm ● 無地貼可
防かび 通気性
▶ 選択上の注意
準不燃
防火種別2-3 AA 1,090円/㎡ 巾92cm
防かび 抗菌 表面強化
撥水
吸放湿 撥水 ストレッチ
品番が青字の商品は別のページにも掲載があります。
▶ 選択上の注意 「通気性壁紙」の選択上の注意につきましてはP.127をご参照ください。
通気性
ロングセラ
通気性
通気性
ハードストレッチ(消臭)
ルームエアー(消臭)
ハードストレッチ(消臭) ロングセラー リフォームおすすめ イメージ写真を 全点見る 64
天井 天 井
通気性

RE55564 (P.128) リフォームおすすめ
準不燃
防火種別2-3 AA 1,090円/㎡
巾92.5cm ↕32cm ↕ 46.3cm 防かび 通気性 抗 アレ ル
▶ 選択上の注意
通気性

RE55570 (P.128) リフォームおすすめ
準不燃
防火種別2-3 AA 1,090円/㎡ 巾92cm ↕32.1cm ↕ 46.2cm ● 無地貼可 防かび 通気性 抗 アレ ル
▶ 選択上の注意

準不燃
防火種別2-3 AA 1,090円/㎡
巾92cm ↕16cm ↕ 18.5cm 防かび

準不燃
防火種別2-3 AA 1,090円/㎡
巾92cm ↕32.1cm ↕ 30.8cm 防かび

準不燃
防火種別2-3 AA 1,090円/㎡
巾92cm ↕4cm ↕ 4cm 防かび

準不燃
防火種別2-3 AA 1,090円/㎡
巾92cm ↕21.4cm ↕ 23.1cm 防かび 通気性 抗 アレ ル
▶ 選択上の注意
▶ 選択上の注意 「通気性壁紙」の選択上の注意につきましてはP.127をご参照ください。 品番が青字の商品は別のページにも掲載があります。



リフォームおすすめ 通気性 RE55211 ロングセラ
ロングセラー
イメージ写真を 全点見る 65
RE55210 RE55209 リフォームおすすめ RE55212
RE55209・55587 RE55210 RE55211
リフォームおすすめ
エレガントなお部屋におすすめ クラシックなモチーフや温かみのあるリッチなテクスチャー 天 井
ルームエアー(消臭)
ルームエアー(消臭)

RE55213
準不燃
巾92cm
防火種別2-3 AA 1,090円/㎡
防かび 抗菌 消臭

リフォームおすすめ
RE55615 (P.137 ) ウレタンコート
リフォームおすすめ
準不燃
巾92cm
防火種別2-3 AA 1,090円/㎡
防かび 抗菌 消臭
ハードストレッチ(消臭)

RE55214
準不燃
防火種別2-3 AA 1,090円/㎡ 巾92cm
防かび 抗菌 表面強化 消臭 吸放湿 撥水 ストレッチ 撥水

(P.76)
準不燃
防火種別2-3 AA 1,090円/㎡
巾92.5cm ↕32cm ↕ 46.4cm エンボスリピート
防かび 抗菌 表面強化 消臭

準不燃
防火種別2-3 AA 1,090円/㎡
巾92cm ↕64cm ↕ 92cm
防かび 抗菌 表面強化
抗ウイルス ウレタンコ ト 吸放湿 撥水

リフォームおすすめ
吸放湿 撥水 ストレッチ 撥水
品番が青字の商品は別のページにも掲載があります。
準不燃
巾92cm 防かび
防火種別2-2 AA 1,090円/㎡
壁紙:RE55215

床材:WD-2085(2023-2026 FLOOR TILE)


リフォームおすすめ ハードストレッチ(消臭)
RE55251
RE55215
RE55216 リフォームおすすめ ロングセラ
RE55615・55230
ロングセラー リフォームおすすめ イメージ写真を 全点見る 66
RE55216・55700
天井 天 井
暮らしの 困りごとを 壁紙で解決
お部屋別おすすめ機能性壁紙

玄 関・廊下
お客さまをお迎えする玄関はきれいに保 ちたい。メンテナンスしやすく貼り上がり も良い壁紙がおすすめ。
▲ P 71 ハードスト
▲ P 83 ウレタンコート壁紙
花粉やウイルスの侵入口。壁紙でも対策!
▲ P 89 抗ウイルス壁紙
▲ P 93 抗アレル壁紙
トイレ
抗菌・抗ウイルス機能で清潔 な空間を保つ。
▲ P. 97
毎日のお掃除が簡単。 ニオイ対策もバッチリ。
P
▲



機能性の壁紙はWEBサイトからも ご覧いただけます。
リビング
家族が過ごす空間は快適に。 キズや汚れにも強く、吹き抜け のある空間にも安心の施工性。

ペットのいる空間にはキズに 強い壁紙がおすすめ。
花粉の侵入口になる大きな窓 があるお部屋は壁紙でも花粉 対策を。
シューズクローク
ニオイのこもる空間には“防臭”効果のある壁 キャンプ・釣り・ゴルフ用品や自転車などを収 納したいスぺース。うっかりキズがついてしま うのを防ごう。


水はねしてもさっと拭き取れる! 清潔感のある洗面所で爽やか な1日のはじまりを! ▲
油汚れも中性洗剤でらくらくメンテナンス。 防臭効果もあるので、お料理のニオイも換気 するだけでクリアに!

2
6
5 キッチン・ダイニン
1
レッチ壁紙
6 1 F 2
ライトフレッシュ壁紙 ▲
103 フィルム汚れ防止壁紙 (バリアタイプ)
P. 115 フィルム汚れ防止壁紙 (バランスタイプ) ▲ P 103 フィルム汚れ防止壁紙 (バリアタイプ) ▲ P 109 スーパー耐久性 4 洗面室
97 イトフレッシュ壁紙
115 ィルム汚れ防止壁紙 ランスタイプ) ▲ P. 71 ハードストレッチ壁紙 ▲ P. 83 ウレタンコート壁紙 ▲ P. 109 スーパー耐久性 ▲ P. 93 抗アレル壁紙 ▲ P 103 フィルム汚れ防止壁紙 (バリアタイプ) 67
P
▲ P.
ライベートルーム
▲ P 121 吸放湿壁紙


子ども部 屋
書 斎
リラックスして過ごしたいお部 屋はキズや汚れに強い壁紙で 美観維持を。


ニオイが気になる場合は防臭 機能のある壁紙もおすすめ。
お子さまが過ごす空間には、キズや汚れ がつきにくい壁紙を。
▲ P. 83 ウレタンコート壁紙
▲ P. 119 スーパークリーン 湿気のこもりやすい北側のお 部屋には湿気対策ができる壁 紙を。
大切なお子さまのお部屋にはより安全、 安心な空間づくりを。
▲ P. 89 抗ウイルス壁紙
▲ P. 93 抗アレル壁紙


収納内は湿気のこもりやすい空間。
湿気対策を壁紙でも。
▲ P 121 吸放湿壁紙
調湿効果のある石膏ボードを使用する場 合は通気性のある壁紙がおすすめ。
▲ P 127 通気性壁紙

寝室
落ち着いて過ごしたい空間は、壁紙でも 安心をプラス。
▲ P. 89 抗ウイルス壁紙
ハウスダストが溜まりやすいカーテンや 寝具、棚のある空間には、アレル物質の 対策ができる壁紙が効果的。
プロジェクターで映画鑑賞を楽しむなら きれいに投映できる壁紙がおすすめ。
8
10
9 クローゼット
1
10 2 7 9 11 8 F 7 プ
ィルム汚れ防止壁紙 (バリアタイプ)
ハードストレッチ壁紙 ▲
▲ P. 93 抗アレル壁紙 ▲ P. 62 プロジェクター用壁紙 ▲ P 103 フ
▲ P. 71
P. 83 ウレタンコート壁紙
68 機能性説明
ハ ードストレッチ 壁紙
■ ひび割れを軽減する特殊配合で美観維持ができる
■ キズや汚れに強く、施工性が良い
抗ウイルス壁紙
P.71~
ウレタンコート壁紙
P.89~
■ 抗 ウイルス成分が壁紙表面に付着した ウイルスを分解
■ 抗菌性に優れ、菌の増殖を抑える
P.83~
■ 壁紙表面のウレタンコートでキズや汚れがつきにくい
■ 施工性がよく、貼り上がりが きれい
抗アレル壁紙
P.93~
■ 壁紙の表面に付着したアレル物質の働きを低減
■ 日本アトピー協会推薦品
P.109~ フィルム汚れ防止 バリアタイプ
P.103~
■ ニオイや汚れの防止と表面強度
■ キッチンまわりの油汚れに強い
フィルム汚れ防止
バランスタイプ
■ ニオイや汚れの防止と貼り上がりのきれいさ
■ 水まわりの汚れに強い
P.115~
スーパー耐久性
■ 非常に高い表面強度で引っかき キズや衝撃に強い
■ 汚れに強く、壁紙にニオイが染みつかない
スーパークリーン
P.119~
■ 防汚性が高く、拭き取りで簡単に汚れが落ちる
■ シックハウス症候群の原因物質を未使用の環境対応品
吸放湿壁紙
P.121~
■ 吸水ポリマーによってお部屋の湿度を調節
■ 結露やカビの発生リスクを軽減
pick up !
T OT O の環境浄化技 術「 ハ イドロテ クト 」を活用した、光触媒作用による抗 ウ イ ル ス壁紙
■ 壁紙表面に発生する活性酸素層により、有害なウイルスをブロック
■ 抗菌成分も含まれており、ニオイや汚れの原因となる菌の増殖を抑制
通気性壁紙
P.127~
■ 高い通気性で壁を通して湿気を排出
■ 調湿効果のある石膏ボードとの組み合わせがおすすめ
WEBサイトで見る。
HYDROTECT ハイドロテクト
ハイドロテクトは光触媒を利用し、光や水の力 で地球も暮らしもきれいにする TOTO 株式会社 の環境浄化技術です。光のエネルギーでお部屋 を清潔に保つことができる、住まいに安心を与 えてくれる壁紙です。
り
適 な 暮 らし を ラ
機能性壁 紙 で 、よ
快
イトフレッシュ 壁 紙 Light Fresh WALL
P.97~
69
汚れを落としやすい
優れた防汚性能 スーパークリーン
キズにも強い スーパー耐久性
油汚れに強い フィルム汚れ防止 バリアタイプ
水汚れに強い フィルム汚れ防止 バランスタイプ
安心の施工性 ウレタンコート
オールマイティな 多機能壁紙 ハードストレッチ
施工性が良く貼り上がり安心
フィルム汚れ防止 バリアタイプ スーパー耐久性 スーパークリーン 拭き取り前
コーヒー (水拭き)



フィルム汚れ防止 バランスタイプ ウレタンコート ハードストレッチ 一般ビニル壁紙

水性ペン (洗剤で拭き取り)










拭き取りのタイミング
お手入れのポイント
機能性説明
1POINT
壁紙を汚してしまったら、でき るだけ早く水拭きしましょう。
2POINT
汚れが落ちにくい場合は、台 所用洗剤などの中性洗剤をご 使用ください。
3POINT
変色の原因になるため、壁紙 に汚れや洗剤が残らないよう にきれいに拭き取りましょう。
拭き取り前 直後
1 時間後
クレヨン (洗剤で拭き取り)







ヘアカラー (洗剤で拭き取り)



汚れ付着1時間後に拭き取り ※上記は自社試験における結果であり、色や柄によって試験結果は異 なります。








24 時間後 一週間後

フィルム汚れ防止壁紙 バリアタイプに付着し たヘアカラー剤を中性洗剤で拭き取り 時間が経つにつれて、汚れが落ち にくくなってしまいます。汚れたらす ぐにお手入れするのがポイント。
[ 徹底比較 ]
汚 れを落としやすい 壁紙
70
ハードストレッチ壁紙
キズや汚れに強く、 ひび割れを軽減する「多機能」壁紙
P O N T
キズがつきにくい表面構造で表面強度 をアップ!キズに強く、元気なお子さまが 過ごす空間にも安心。
O N T
表面の撥水コートが水汚れをはじくの で、メンテナンスがらくらく。汚れを拭き 取りやすい壁紙です。抗菌機能もついて 衛生的!


ハードストレッチ壁紙 一般ビニル壁紙 水分をはじく 水滴が全体に広がる
ひび割れを軽減 P O N T
壁紙にストレッチ性があり、ひび割れを軽 減。ストレッチ性のある特殊配合で、 2.7mm引っ張っても破断しない!
各種機能性データ
● 表面強化性能試験
ハードストレッチ壁紙 一般ビニル壁紙
[試験方法]
壁紙工業会規定 表面強化壁紙性能試験に準ずる。
[評価基準]

性能:4〜5級 性能:1〜3級
● 引っ張り試験

所定の摩擦子(荷重200g)を 取り付け5回往復さ せ、目視により表面のキズつき度合いを評価する。
5級:一見視で特に変化がみられない
4級:多少表面キズがみられるが、比較的大きな表 面層の破れなどはみられない
3級:表面層の破れが明確にみえる
2級:表面が破れて紙などの裏打ち材が明らかにみ える(長さ1cm未満)
1級:表面が破れて紙などの裏打ち材が明らかにみ える(長さ1cm以上)
ハードストレッチ 壁紙 一般ビニル 壁紙
[試験方法] 基材に両面テープで壁紙を貼り 付け試験体とする。試験装置で 試験体を引っ張り、状態変化が 起こる変位量を測定する。 (※自社オリジナル試験) ※試験結果は実測値であり、ひ び割れが起こらないことを保 証するものではありません。 試験材 変位1.5mm 変位2.7mm





メンテナンスが簡単
キズがつき
P
にくい
◯ : 変化軽微 △ : 破損 ◯ : 変化軽微 × : 破断
壁紙:RE55221・55223 床材:WD-2031-W(2023-2026 FLOOR TILE) 71

RE55221 NEW リフォームおすすめ
準不燃
巾92cm
防火種別2-3 AA 1,090円/㎡
防かび 抗菌 表面強化 吸放湿 撥水 ストレッチ 撥水

RE55225 NEW リフォームおすすめ
準不燃
防火種別2-3 AA 1,090円/㎡
巾92.5cm ↕63.9cm ↕ 92.5cm エンボスリピート
防かび 抗菌 表面強化 吸放湿 撥水 ストレッチ 撥水

RE55222 NEW リフォームおすすめ

RE55223 NEW リフォームおすすめ

RE55226 NEW リフォームおすすめ

RE55227 NEW リフォームおすすめ

RE55224 NEW リフォームおすすめ
自然な石の質感をリアルに再現したモダンな石目調。グレー系の4配色です。 おおらかな石目の横流れを表現したシリーズ。温かみのあるベージュ系の4配色です。

RE55228 NEW リフォームおすすめ
リフォームおすすめ イメージ写真を 全点見る 72
ハードストレッチ壁紙 ハードストレッチ

壁紙:RE55234 床材:WD-2032-W(2023-2026 FLOOR TILE)





RE55229 リフォームおすすめ RE55230 リフォームおすすめ RE55231 リフォームおすすめ RE55232 リフォームおすすめ RE55236
リフォームおすすめ イメージ写真を 全点見る 73
1,090円/㎡ 巾92.5cm ↕31.5cm ↕ 46.4cm エンボスリピート ● 無地貼可 防かび 抗菌 表面強化 消臭 吸放湿 撥水 ストレッチ 撥水 準不燃
防火種別2-3 AA

準不燃
防火種別2-3 AA 1,090円/㎡
巾92.5cm ↕31.4cm ↕ 46.3cm エンボスリピート 防かび 抗菌 表面強化 消臭 吸放湿 撥水 ストレッチ 撥水

準不燃
防火種別2-3 AA 1,090円/㎡ 巾92.5cm ↕35.1cm ↕ 92.5cm エンボスリピート 防かび 抗菌 表面強化 吸放湿 撥水 ストレッチ 撥水


準不燃
巾92cm
防火種別2-3 AA 1,090円/㎡
防かび 抗菌 表面強化 吸放湿 撥水 ストレッチ 撥水


準不燃
巾92cm
防火種別2-3 AA 1,090円/㎡
防かび 抗菌 表面強化 吸放湿 撥水 ストレッチ 撥水

リフォームおすすめ

RE55233 RE55235 RE55234 RE55236 RE55237 RE55239
RE55238
RE55240
イメージ写真を 全点見る 74
リフォームおすすめ
リフォームおすすめ リフォームおすすめ
ハードストレッチ壁紙 ハードストレッチ

準不燃
防火種別2-3 AA 1,090円/㎡ 巾92cm
防かび 抗菌 表面強化 消臭 吸放湿 撥水 ストレッチ 撥水

準不燃
防火種別2-3 AA 1,090円/㎡ 巾92cm
防かび 抗菌 表面強化 消臭 吸放湿 撥水 ストレッチ 撥水



準不燃
防火種別2-3 AA 1,090円/㎡ 巾92cm
防かび 抗菌 表面強化 消臭 吸放湿 撥水 ストレッチ 撥水



RE55241
RE55245 RE55242
RE55246
RE55243 リフォームおすすめ RE55247 NEW リフォームおすすめ RE55244 リフォームおすすめ RE55248 リフォームおすすめ リフォームおすすめ イメージ写真を 全点見る 75
リフォームおすすめ
リフォームおすすめ
リフォームおすすめ
ハードストレッチ壁紙
販売 を停 止してい ます

壁紙:RE55249・55252
床材:WD-2090(2023-2026 FLOOR TILE)



リフォームおすすめ


RE55250
RE55249 リフォームおすすめ RE55250 リフォームおすすめ RE55251
RE55252 リフォームおすすめ
リフォームおすすめ イメージ写真を 全点見る 76
エンボスリピート 防かび
表面強化 消臭 吸放湿 撥水 ストレッチ 撥水 準不燃 ハードストレッチ壁紙 ハードストレッチ
防火種別2-3 AA 1,090円/㎡ 巾92.5cm ↕32cm ↕ 46.4cm
抗菌

RE55253 NEW リフォームおすすめ

RE55255 NEW リフォームおすすめ

RE55254 NEW リフォームおすすめ

RE55256 NEW リフォームおすすめ

壁紙:RE55254・55255 カーテン:AC2350(2023-2026 AC) 床材:WD-2071(2023-2026 FLOOR TILE) リフォームおすすめ イメージ写真を 全点見る 77 防火種別2-3 AA 1,090円/㎡ 巾92cm ↕32cm ↕ 92cm 防かび 抗菌 表面強化 吸放湿 撥水 ストレッチ 撥水 準不燃 リッチな素材感とパールの輝きが魅力の織物調です。 ナチュラルからシックまで幅広いテイストでお使いいただけます。 ハードストレッチ壁紙




準不燃
巾92cm
防火種別2-3 AA 1,090円/㎡
防かび 抗菌 表面強化
吸放湿 撥水 ストレッチ 撥水
▶ 施工注意
入念な下地処理を行い、糊ダマリに注意して施工してください。 糊付け後は大きくたたみ、折りジワに注意して、上積みは避けてください。

シャープな織りの凹凸をリアルに再現した織物調。 ライトモダンな空間におすすめです。
RE55257 NEW RE55258 NEW RE55259 NEW RE55260 NEW リフォームおすすめ 壁紙:RE55257・55260 カーテン:AC2531(2023-2026
床材:WD-2071(2023-2026 FLOOR TILE)
イメージ写真を 全点見る 78
AC)
リフォームおすすめ
ハードストレッチ壁紙 ハードストレッチ

壁紙:RE55263 床材:WD-2134(2023-2026 FLOOR TILE) RE55261





1,090円/㎡
RE55261
リフォームおすすめ
RE55262 リフォームおすすめ
RE55263 リフォームおすすめ RE55264 リフォームおすすめ
リフォームおすすめ イメージ写真を 全点見る 79 防火種別2-3 AA
巾92cm 防かび 抗菌 表面強化 吸放湿 撥水 ストレッチ 撥水 準不燃

RE55265 リフォームおすすめ
準不燃
巾92cm
防火種別2-3 AA 1,090円/㎡
防かび 抗菌 表面強化 消臭 吸放湿 撥水 ストレッチ 撥水

RE55267 リフォームおすすめ
準不燃
防火種別2-3 AA 1,090円/㎡
巾92.5cm ↕32.1cm ↕ 30.9cm ● 無地貼可 防かび 抗菌 表面強化 消臭 吸放湿 撥水 ストレッチ 撥水

RE55266 リフォームおすすめ

壁紙:RE55265 床材:WD-2038-W(2023-2026 FLOOR TILE)

RE55268 リフォームおすすめ

RE55267・55268
リフォームおすすめ イメージ写真を 全点見る 80
ハードストレッチ

準不燃
防火種別2-3 AA 1,090円/㎡ 巾92cm
防かび 抗菌 表面強化 吸放湿 撥水 ストレッチ 撥水

準不燃
防火種別2-3 AA 1,090円/㎡ 巾92cm






準不燃
防火種別2-3 AA 1,080円/㎡
巾93cm ↕46.2cm ↕ 46.5cm 防かび 抗菌 表面強化 消臭 吸放湿 撥水 ストレッチ 撥水
RE55269
RE55270
RE55274
RE55271
RE55275
RE55272
RE55276
リフォームおすすめ イメージ写真を 全点見る 81
リフォームおすすめ RE55273 リフォームおすすめ
リフォームおすすめ
リフォームおすすめ
リフォームおすすめ
NEW
リフォームおすすめ
NEW
防かび 抗菌 表面強化 消臭 吸放湿 撥水 ストレッチ 撥水
ハードストレッチ壁紙

RE55269・55272





準不燃
防火種別2-3 AA
RE55278 RE55279 NEW RE55280 RE55280
RE55277
イメージ写真を 全点見る 82
吸放湿
撥水 ※エンボスリピートは合いません。
1,090円/㎡ 巾92.5cm ↕64cm ↕ 46.4cm 防かび 抗菌 表面強化 消臭
撥水 ストレッチ
ハードストレッチ壁紙 ハードストレッチ
ウレタンコート壁紙
汚れやキズに強く、貼り上がりがキレイ
環境に優しい水性のウレタン樹脂をコーティ ング。表面が強く壁にキズがつくのを軽減でき るので、小さなお子さまのいるお部屋に。
施工性が良いのでメインクロスにもおすすめ。 壁の面積が広いLDKや、往来の多い玄関、廊 下、階段にも。マットな表情でおしゃれな仕上 がりに。
一般的な壁紙に比べて汚れが拭き取りやすい。耐薬 品性に優れているのでお掃除がしやすく、汚れやすい けど美観を保ちたい空間におすすめ。
各種機能性データ
● 表面強化性能試験結果
試験材 評価 ウレタンコート壁紙 4〜5級 一般ビニル壁紙 1〜3級
[試験方法]
壁紙工業会規定 表面強化壁紙性能試験に準ずる。 [評価基準] 所定の摩擦子(荷重200g)を 取り付け5 回往 復させ、 目視により表面のキズつき度合いを評価する。
5級:一見視で特に変化がみられない
4級:多少表面キズがみられるが、比較的大きな表面 層の破れなどはみられない
3級:表面層の破れが明確にみえる
2級:表面が破れて紙などの裏打ち材が明らかにみ える(長さ1cm未満)
1級:表面が破れて紙などの裏打ち材が明らかにみ える(長さ1cm以上)
● 耐薬品性試験結果
● 耐汚染性試験結果
[試験結果] 各種薬品に対する24時間後の耐薬品性能を評価しています。
各種汚染物質に対する24時間後の汚れ防止性能を評価しています。
汚染物質 ウレタンコート壁紙 一般ビニル壁紙 アクリルコート品
コーヒー ○ ×〜△ △〜○
醤油 ◎ ×〜△ △
ソース △〜○ × △〜○
オレンジジュース ◎ ○ ◎
水性ペン ◎ × △〜○
クレヨン ○ × ○〜◎
油性ペン ××〜× ××〜× ××〜×
口紅 △〜○ × △〜○
[試験方法] コーヒー、醤油、ソース、ジュース:水で拭き取る。
水性ペン、油性ペン:水と台所用洗剤で歯ブラシを用いて汚れを落とす。 クレヨン、口紅:水と台所用洗剤で歯ブラシを用いて汚れを落とし、ウェスで水気を拭き取る。
[評価基準]
JIS L 0805に定める汚染用グレースケールを用い、汚染度合いを評価する。
◎:5級 汚れが残らない ◯:4級 ほとんど汚れが残らない
△:3級 やや汚れが残る ×:2級 かなり汚れが残る ××:1級 汚れが濃く残る
薬品名 ウレタンコート壁紙 一般ビニル壁紙 アクリルコート品
次亜塩素酸ナトリウム(6%) ◎ ○ △
無水エタノール(99.5vol%) ◎ ◎ ◎
アンモニア水(25%) ◎ ◎ ◎
過酸化水素水(3.5w/v%) ◎ ◎ ◎ ポピドンヨード(7%) △ × △
塩酸(9.5%) ○ △ ○
ベンザルコニウム水溶液(10%) ○ △ △
ホルマリン液(37%) ◎ ◎ ◎
クレゾール石鹸液(3%) ◎ ◎ ◎ シンナー(原液) ◎ ○ ◎
[試験方法] JIS K 6902Bに準じ、汚染物質については当社基準 による。
[評価基準] 色相変化および状態変化により総合評価を行う。 色相変化:JIS L 0805に定める汚染用グレース ケールを用い、汚染度合いを評価する。
状態変化:目視により外観の状態変化を評価する。
◎…変化なし ◯…軽微な変化 △…変化あり ×…明らかな変化
※試験結果は測定値であり、保証値ではありません。 ※色や柄によって試験結果は異なります。

汚 れが 拭 き取りやすい P O N T 貼り上 がりが キレイ P O N T キズ
が つ きにくい P O N T
壁紙:RE55291・55297・55298 床材:WD-2013(2023-2026 FLOOR TILE) 83

RE55291 NEW リフォームおすすめ

RE55292 NEW リフォームおすすめ

RE55295 NEW リフォームおすすめ
準不燃
巾92cm
防火種別2-3 AA 1,090円/㎡
防かび 抗菌 表面強化 抗ウイルス ウレタンコ ト 吸放湿 撥水
▶ 施工注意
濃色の商品は、ひっかきキズや糊の拭き残しにご注意ください。

RE55293 NEW リフォームおすすめ

RE55294 NEW リフォームおすすめ

RE55296 NEW リフォームおすすめ

RE55297 NEW リフォームおすすめ

RE55298 NEW リフォームおすすめ
人気のくすみカラーを取り入れたシリーズです。
シャビーな質感が魅力で、写真のようなアクセント使いにもおすすめ。
リフォームおすすめ イメージ写真を 全点見る 84
ウレタンコート壁紙 ウレタンコート








RE55299 NEW RE55303 NEW RE55300 NEW RE55304 NEW RE55301 NEW RE55305 NEW RE55302 NEW RE55306 NEW イメージ写真を 全点見る 85 防火種別2-3 AA 1,090円/㎡ 巾92cm 防かび 抗菌 表面強化 抗ウイルス ウレタンコ ト 吸放湿 撥水 準不燃 ウレタンコート壁紙



RE55305・55613・55678・55595



RE55307 リフォームおすすめ RE55308 リフォームおすすめ RE55309 リフォームおすすめ RE55310 リフォームおすすめ
壁紙:RE55307・55310 スマートジョイナー:SRJ-251 床材:WD-2013(2023-2026 FLOOR TILE) リフォームおすすめ イメージ写真を 全点見る 86 防火種別2-3 AA 1,090円/㎡ 巾92cm ↕32cm ↕ 23.1cm ● 無地貼可 防かび 抗菌 表面強化 抗ウイルス ウレタンコ ト 吸放湿 撥水 準不燃 ウレタンコート




準不燃
防火種別2-3 AA 1,090円/㎡ 巾92cm ↕21.4cm ↕ 46.2cm
防かび 抗菌 表面強化 抗ウイルス ウレタンコ ト 吸放湿 撥水
▶ 施工注意
糊付け後は大きくたたみ、折りジワや糊ダマリに注意して、上積みは避けてください。


準不燃
防火種別2-3 AA 1,090円/㎡ 巾92cm ↕32cm ↕ 46cm 防かび 表面強化 抗ウイルス ウレタンコ ト
準不燃
防火種別2-3 AA 1,090円/㎡
巾92.5cm ↕32cm ↕ 46.3cm エンボスリピート
防かび 抗菌 表面強化 抗ウイルス ウレタンコ ト 吸放湿 撥水 ※プリントリピートは合いません。


準不燃
防火種別2-3 AA 1,090円/㎡
巾92cm ↕30.6cm ↕ 46cm エンボスリピート
防かび 表面強化 抗ウイルス ウレタンコ ト
RE55311 RE55313 リフォームおすすめ ロングセラ RE55312 RE55314 リフォームおすすめ RE55315 RE55317 リフォームおすすめ ロングセラ RE55316 RE55318 リフォームおすすめ ロングセラー リフォームおすすめ イメージ写真を 全点見る 87
ウレタンコート壁紙
RE55320

RE55322


RE55319 NEW リフォームおすすめ
準不燃
防火種別2-3 AA 1,090円/㎡ 巾92cm ↕32cm ↕ 92cm エンボスリピート
防かび 抗菌 表面強化 抗ウイルス ウレタンコ ト 吸放湿 撥水

RE55321 ロングセラ
準不燃
防火種別2-3 AA 1,090円/㎡ 巾92cm ↕32cm ↕ 23cm ● 無地貼可
防かび 抗菌 表面強化 抗ウイルス ウレタンコ ト 吸放湿 撥水

RE55320 NEW リフォームおすすめ

RE55322 ロングセラ
ロングセラー リフォームおすすめ イメージ写真を 全点見る 88
ウレタンコート壁紙 ウレタンコート
感染価(
抗ウイルス壁紙
ウイルス対策に効果的
P O N T
ウイルスを分解
壁紙の表面に付着したウイルスを分解! 抗菌性にも優れ、よりよい衛生環境づ くりをお手伝い。ウイルスだけでなく、 細菌の増殖を抑制する働きも。
ウイルス
抗ウイルス壁紙の仕組み
塩化ビニル樹脂層
抗ウイルス性成分が、ウイルス表層の タンパク質を変性・破壊し、さらに有機 成分を分解。壁紙表面に付着したウ イルスに効果があります。
表面コート層 ( 抗ウイルス剤 入り)
各種機能性データ
■ 抗ウイルス性能試験結果
● 抗ウイルス性能試験結果
4.0E+04
3.0E+04
2.0E+04
1.0E+04
% 以上 減少
5.0E+04 感染価( P FU /㎠)
0.0E+00 24時間後 試験前
接触 減少
裏打紙下地基材
変 性・破 壊 分解
ウイルスA(エンベロープあり) ウイルスB(エンベロープなし)
5.0E+07
4.0E+07
3.0E+07
2.0E+07
1.0E+07
0.0E+00 試験前
[試験方法]JIS R 1756に準ずる。 [試験機関]北里環境科学センター ※上記は代表的な仕様での測定値であり、保証値ではありません。
● 抗ウイルス試験(プラーク法)結果
白く抜けている部分(プラーク)が、ウイルスの存在により細胞が侵された跡です。
ウイルスA (エンベロープあり) 初期



2時間後 抗ウイルス壁紙 2時間後 無加工品
※試験結果は測定値であり、保証値ではありません。
※製品上の特定ウイルスの数を減少させます。
99% 以上 減少
24時間後
ウイルスB (エンベロープなし) 初期



2時間後 抗ウイルス壁紙 2時間後 無加工品
※抗ウイルス加工は、病気の治療や予防を目的としたものではありません。 ※ウイルス自体を分解、忌避する効果はありません。
※壁紙表面に付着したウイルスや細菌に効果を発揮します。
※空気中のウイルスの吸着を促進したり、減少させる効果はありません。
※試験結果は特定のウイルス・菌を対象としたものであり、すべてのウイルス・菌への効果を示すものではありません。

P /㎠)
99
RE55336・55338 89




準不燃
防火種別2-3 AA 1,080円/㎡
巾93cm ↕31.5cm ↕ 46.5cm エンボスリピート ● 無地貼可
防かび 抗菌
通気性 抗ウイルス




準不燃
巾92cm
防火種別2-3 AA 1,090円/㎡
防かび 抗菌 通気性 抗ウイルス
RE55331 RE55335 RE55332 NEW RE55336 RE55333 RE55337 リフォームおすすめ RE55334 RE55338 リフォームおすすめ リフォームおすすめ イメージ写真を 全点見る 90
抗ウイルス壁紙 抗ウイルス

壁紙:RE55340
床材:WD-2032-W(2023-2026 FLOOR TILE)

準不燃
巾92cm
防火種別2-3 AA 1,090円/㎡

壁紙:RE55341
床材:WD-2034-W・IS2038(2023-2026 FLOOR TILE)



準不燃
巾92cm
防火種別2-3 AA 1,090円/㎡
RE55339 リフォームおすすめ RE55340 リフォームおすすめ RE55341 RE55342
イメージ写真を 全点見る 91
リフォームおすすめ
防かび 抗菌 通気性 抗ウイルス
防かび 抗菌 通気性 抗ウイルス






RE55343 リフォームおすすめ RE55344 リフォームおすすめ RE55345 NEW リフォームおすすめ RE55346 リフォームおすすめ 壁紙:RE55345 カーテン:AC2282・2539(2023-2026 AC)
リフォームおすすめ イメージ写真を 全点見る 92 防火種別2-3 AA 1,090円/㎡ 巾92cm ↕62.8cm ↕ 92cm エンボスリピート 防かび 抗菌 通気性 抗ウイルス 準不燃 抗ウイルス
RE55344
抗アレル壁紙
アレル物質の働きを低減する
P O N T
アレル 物 質を 低 減
アレル物質とは・・・
アレルギー症状の原因となる 物質のことです。よく知られて いるものとしては、ダニの糞や 死骸などのハウスダストやス ギ花粉等が挙げられます。ア レル物質の多くは部屋の中で 床上1mまでの空間を浮遊す ると言われており、抗アレル壁 紙を壁面にお使いいただくと 効果的です。
ダニアレル物質低減率
壁紙表面に付着したアレル物質を包みこ み、働きを低減。 スギ花粉アレル物質低減率
抗 アレル 壁紙の仕組み
壁紙表面のアレル物質低減剤がアレル 物質を包みこみ、その働きを低減します。
アレル物質 接触
塩化ビニル樹脂層
表面コート層 (アレル物質低減 剤入り)
裏打紙下地基材
低減
時間(h)
[試験方法]
抗アレル壁紙 ブランク
時間(h)
ダニならびにスギ花粉アレル物質溶液を壁紙表面に接触させ、2時間後のアレル物質残存量をELISA法にて測定する。 ELISA法(酵素免疫測定法):文部科学省「学校環境衛生の基準」(15文科ス第402号)推奨検査方法 ※上記の試験結果は測定値であり、保証値ではありません。
認証番号 S12104F03A:RE55351~55354・55361~55364・55369・55370
認証番号 S1411501A:RE55355~55360・55365~55368 ● アレル物質低減率

0 20 40 60 100 80 0 2 120 (% ) 0 20 40 60 100 80 0 2 120 (% ) 約 72 % 低減 約 82 % 低減
RE55356 93

RE55351 NEW
準不燃
防火種別2-3 AA 1,090円/㎡ 巾92cm ↕61.8cm ↕ 92cm エンボスリピート 防かび 消臭 抗 アレ ル

準不燃
防火種別2-3 AA 1,090円/㎡ 巾92cm 防かび 消臭 抗 アレ ル ※RE55356〜RE55358と同じエンボスの商品です。

NEW


NEW



準不燃
防火種別2-3 AA 1,090円/㎡
巾92.5cm ↕64.2cm ↕ 92.5cm 防かび 消臭 抗 アレ ル
RE55356
RE55357 リフォームおすすめ RE55354
RE55358
リフォームおすすめ イメージ写真を 全点見る 94
RE55355 NEW RE55352
リフォームおすすめ RE55353 NEW
リフォームおすすめ
抗アレル壁紙 抗アレル


準不燃
防火種別2-3 AA 1,090円/㎡
▶ 施工注意
濃色の商品は、ひっかきキズや糊の拭き残しにご注意ください。


防火種別2-3 AA 1,090円/㎡ 巾92cm ↕30.7cm ↕ 46.2cm エンボスリピート



RE55361 ロングセラ RE55362 NEW リフォームおすすめ RE55359 ロングセラ RE55363 NEW リフォームおすすめ RE55360 NEW RE55364 NEW リフォームおすすめ RE55359 ロングセラー
イメージ写真を 全点見る 95
リフォームおすすめ
巾92cm 防かび 消臭 抗 アレ ル
防かび 消臭 抗 アレ ル
準不燃


準不燃
巾92cm
防火種別2-3 AA 1,090円/㎡
防かび 消臭
アレ ル

準不燃
巾92cm
防火種別2-3 AA 1,090円/㎡
防かび 消臭 抗 アレ ル




準不燃
防火種別2-3 AA 1,090円/㎡
巾92.5cm ↕23.1cm ↕ 46.3cm
ロングセラ RE55369 RE55370
RE55366 リフォームおすすめ ロングセラ
RE55367 RE55368
RE55365 リフォームおすすめ ロングセラ
ロングセラー リフォームおすすめ イメージ写真を 全点見る 96
RE55367
抗
防かび 消臭 抗 アレ ル
抗アレル
ラ イトフレッシュ 壁 紙
L i g h t F r e s h WA L L
TOTO の 環境浄化技術「 ハイドロテ ク ト 」を活用した 光触媒作用による抗ウイルス壁紙
ライトフレッシュ壁紙の効果
〈 光の当たる場所 / 窓からの光、蛍光灯など 〉 光源
抗菌成分

活性酸素 ハイドロテクト層 可視光応答型光触 媒 + 抗ウイルス金属
ウイルス 菌 塩化ビニル樹脂層
可視光応答型光触媒作用に よ り、壁 紙表面に活性 酸素が 発 生。抗ウイルス金属とともに、 明時、暗時問わず有害なウイ ルスを抑制します。また、壁 紙に 含 ま れ る抗 菌成分に より、ニ オ イ、汚れなどの原因であ る菌も 抑 制します。
※本商品は、医薬品や医療機器などの医療を 目的としたものではありません。 また、本商品は表面に付着したウイルスを 抑制するものであり、感染予防を保証する ものではありません。 ※イラストはイメージです。
※ライトフレッシュ壁紙は、株式会社サンゲツがTOTO株式会社より技術提供を受けた製品です。 製品に関するお問い合わせは株式会社サンゲツまでお願いいたします。
HYDROTECT ハイドロテクト
ハイドロテクトは光触媒を利用し、光や水の力で地球も暮らし もきれいにする TOTO 株式会社の環境浄化技術です。光のエネ ルギーでお部屋を清潔に保つことができる、住まいに安心を与 えてくれる壁紙です。
JP0612489X0009U
SIAAマークはISO21702により評価された結果に 基づき、抗菌製品技術協議会ガイドラインで品質 管理・情報公開された製品に表示されています。 2024-0001
PIAJ製品認証とは、光触媒工業会が性能、利用方 法等が適切であることを認めた光触媒製品に与え る製品認証制度です。
試験結果等は こちら
ライトフレッシュ壁紙は S I A A・PIAJ の 抗ウイルス加工認証製品です。
WEBサイトで見る。
RE55381 97 sangetsu


抗ウイルス試 験(プラーク法 )結果
暗く抜けている部分(プラーク)が、ウイルスの存在により細胞が侵された跡です。


試験前
[試験方法 ]ISO 21702:2019 に準 ずる。 [試験機関 ]( 財 )日本繊維製品品質技術センター ※上 記 は 代表 的 な 仕 様 での
抗菌性能比較表
規定 値である[ < 0 63 ]の 性 能を有しています。
[試験方 法]壁紙工業会規定 抗菌壁紙性能試験に準ずる。 菌 A
無加工試験 片(ポリエチレンフィルム)
接種直

※製品 上の特 定ウイルスの数を減 少させます。
※試験 結 果は測 定 値であり、保 証 値ではありません。
また、特 定のウイルス 菌を対 象としたものであり、
すべてのウイルス 菌への効 果を示すものではありません。
※ウイルス自体を分 解 、忌 避する効 果はありません。
※壁紙 表 面に付 着したウイルスや細 菌に効 果を発 揮します。
空 気中のウイルスの吸 着を促 進したり、減 少させる効 果はありません。
※抗ウイルス加 工は、病 気の治 療や予 防を目的としたものではありません。
※防かび・抗菌性能は、壁紙に含まれる抗菌成分によって発現されます。
後 24時間後 接種直後 24時間後 菌 B ライトフレッシュ壁 紙 1 3×10 4 1 3×10 4 <0 6 3 5 1×10 5 1 4×10 4 1 4×10 4 <0 6 3 5 8×10 4
U F ) ㎠ /
ウイルス
ウイルスB(エンベロープなし)
2 1.0E+0 1 1.0E+0 3 1.0E+0 4 1.0E+0 5 1.0E+0 6 ( 価 染 感 P U F ) ㎠ / 1.0E+0 0 試験前 1.0E+0 1 1.0E+0 2 1.0E+0 3 1.0E+0 4 1.0E+0 5 1.0E+0 6 24時間後 99 % 以上 減少 99 % 以上 減少 抗ウイルス性能試験結果 4時間後 無加工品 4時間後 ライトフレッシュ壁紙 RE55398・55400 RE55391 98 sangetsu ライトフレッシュ
測定 値 であり 保証 値 ではありません 。 ( 価 染 感 P
1.0E+0 0 24時間後
A(エンベロープあり)
1.0E+0

RE55381 NEW

RE55382 NEW

RE55383 NEW
準不燃
防火種別2-3 AA 1,090円/㎡
巾92.5cm ↕64cm ↕ 92.5cm 防かび 抗菌 通気性 抗ウイルス
水まわりにおすすめの壁紙。 爽やかなグリーンが、空間に清潔感を与えてくれます。

RE55384 NEW

RE55385 NEW

RE55386 NEW

RE55384・55381・55181 イメージ写真を 全点見る 99
sangetsu
ライトフレッシュ壁紙



RE55387 NEW
準不燃
防火種別2-3 AA 1,090円/㎡
通気性
巾92.5cm ↕47.1cm ↕ 92.5cm エンボスリピート
防かび 抗菌
抗ウイルス

RE55388 NEW
※製法やデザインの特性により、ジョイント部分を正確に合わせることが困難です。

RE55389 NEW

RE55390 NEW
準不燃
防火種別2-3 AA 1,090円/㎡
ライトフレッシュ
光の当たり方で見え方が変わる、 モダンなブロック調壁紙です。

RE55391 NEW リフォームおすすめ

RE55392 NEW リフォームおすすめ
巾92.5cm ↕31.4cm ↕ 46.3cm エンボスリピート
防かび 抗菌
通気性 抗ウイルス
▶ 施工注意
濃色の商品は、ひっかきキズや糊の拭き残しにご注意ください。
ブルーグレーはアクセントの定番カラー。 ネイビーは空間を引き締めておしゃれに演出してくれます。
リフォームおすすめ
RE55392・55389
RE55388
イメージ写真を 全点見る 100
ライトフレッシュ壁紙 sangetsu


NEW

NEW
準不燃
防火種別2-3 AA 1,090円/㎡
通気性
巾92.5cm
防かび 抗菌
抗ウイルス
▶ 施工注意
濃色の商品は、ひっかきキズや糊の拭き残しにご注意ください。

NEW リフォームおすすめ

NEW リフォームおすすめ
シックなカラーリングの繊細な織物調壁紙。
落ち着いたウォームグレーの配色が魅力です。
RE55393
RE55394
RE55395
RE55393・55396・55181 リフォームおすすめ イメージ写真を 全点見る 101
RE55396
sangetsu

NEW リフォームおすすめ

NEW リフォームおすすめ
準不燃
防火種別2-3 AA 1,090円/㎡
通気性
巾92.5cm ↕62.8cm ↕ 92.5cm エンボスリピート
防かび 抗菌
抗ウイルス
▶ 施工注意
濃色の商品は、ひっかきキズや糊の拭き残しにご注意ください。

NEW リフォームおすすめ

NEW リフォームおすすめ
ラフな質感の石目調壁紙。ヴィンテージな配色 でお部屋をインダストリアルに。
 RE55397
RE55398
RE55399
RE55397
RE55398
RE55399
RE55398・55399・55181
イメージ写真を 全点見る 102
RE55400
リフォームおすすめ
sangetsu ライトフレッシュ
汚れが拭き取りやすく、キズにも強い
汚れがつきにくく、抗菌性と耐薬品性にも優れま す。油汚れが気になるキッチンにおすすめ。汚れ が拭き取りやすくお手入れ簡単!中性洗剤の使 用もOK!清潔な空間をキープできます。


一般ビニル壁紙 フィルム汚れ防止壁紙 バリアタイプ ※�壁紙表面にクレヨ ンで汚れを付着させ、 エタノールで拭き取りを行った。
ニオイをバリアする防臭 効果。お手洗いだけでな く、ダイニングやキッチン にも。換気をすることで、食 事などのニオイがお部屋に こもるのを防ぐことができ ます。
各種機能性データ
● 耐汚染性試験結果
各種汚染物質に対する24時間後の汚れ防止性能を評価しています。
汚染物質 フィルム汚れ防止壁紙 バリアタイプ 一般ビニル壁紙 水 中性洗剤 アルコール 水 中性洗剤 アルコール コーヒー ◎ ◎ ◎ △ △ △
醤油 ◎ ◎ ◎ × △ △ ソース ◎ ◎ ◎ ×× × × オレンジジュース ◎ ◎ ◎ ○ ◎ ◎
水性ペン ○ ◎ ◎ × × ×
クレヨン △ ◎ ◎ ×× ×× ××
油性ペン ×× × ◎ ×× ×× ××
口紅 △ ◎ ◎ ×× × ××
[試験方法]�
壁紙工業会規定 汚れ防止壁紙性能試験に準じ、汚染物質については当社基準による。
[評価基準]�
JIS L 0805に定める汚染用グレースケールを用い、汚染度合いを評価する。
◎:5級 汚れが残らない ◯:4級 ほとんど汚れが残らない
△:3級 やや汚れが残る ×:2級 かなり汚れが残る ××:1級 汚れが濃く残る
● 抗菌性能比較表
規定値である[<0.63]の性能を有しています。
菌A 菌B 菌C
接種直後 24時間後 接種直後 24時間後 接種直後 24時間後 フィルム汚れ防止壁紙 バリアタイプ 1.2×104 <0.63 1.1×104
[試験方法]�壁紙工業会規定 抗菌性能試験に準ずる。
※上記の試験結果は測定値であり、保証値ではありません。
※色や柄によって試験結果は異なります。
表面のエバール ®フィルム が、キズや剥がれを防止!
※「 EVAL ® 」および「エバール® 」は 株式会社クラレのエチレン-ビニ ルアルコール共重合樹脂の登録 商標です。
塩化ビニル 樹脂層 裏打紙 エバ
● 耐薬品性試験結果
各種薬品に対する24時間後の耐薬品性能を評価しています。
薬品名
次亜塩素酸ナトリウム(6%)
無水エタノール(99.5vol%)
過酸化水素水(3.5w/v%)
ポピドンヨード(7%)
塩酸(9.5%)
ベンザルコニウム水溶液(10%)
ホルマリン液(37%)
クレゾール石鹸液(3%)
シンナー(原液)
ルゴール液(原液)
アクリノール(原液)
[試験方法]
JIS K 6902Bに準じ、汚染物質については当社基準による。
[評価基準]
色相変化および状態変化により総合評価を行う。
色相変化:�JIS L 0805に定める汚染用グレースケールを用い、汚染度合い を評価する。
状態変化:�目視により外観の状態変化を評価する。
◎…変化なし ◯…軽微な変化 △…変化あり ×…明らかな変化 ※上記の試験結果は測定値であり、保証値ではありません。
※色や柄によって試験結果は異なります。
▶「フィルム汚れ防止壁紙 バリアタイプ」の施工上の注意 モルタル・ベニヤ下地に施工する場合は、フクレやアクを防ぐため、シーラー処理をしてください。 オープンタイムは長めに取ってください。オープンタイム不足はフクレ等の原因になります。 糊付け後は大きくたたみ、折りジワや糊ダマリに注意して、上積みは避けてください。 エアーや水分が抜けにくく、特に低温時にはフクレが生じやすいためご注意ください。 出隅の納めの際は折り曲げた壁紙の表面からきれいな布でしっかりとおさえてください。 施工後は表面に付着した糊や汚れをきれいに拭き取ってください。拭き残しがあると変色の原因になります。 一般ビニル壁紙と比較して施工難易度が高いため、施工費が割増しになる場合があります。

壁紙:RE55422・55415・55241
床材:WD-2031-W(2023-2026 FLOOR TILE)
フィルム汚れ防止壁紙 バリアタイプ
<0.63 1.2×104 <0.63 ポリエチレンフィルム 1.2×104 1.5×106 1.1×104 3.6×104 1.2×104 7.6×104
フィルム汚れ防止壁紙 バリアタイプ 一般ビニル壁紙
◎ ○
◎ ◎
◎ ◎
アンモニア水(25%)
◎ ◎
△ ×
○ △
○ △
◎ ◎
◎ ◎
◎ ○
○ ×
○ ×
◎ △
MEK(原液)
ル ® フィルム層
キズ や 剥 が れに強い P O N T ニ オイを バリアする P O N T 汚れを拭き取りやすい P O N T
汚れ成分 薬品成分 臭気成分
103


RE55411

RE55412

RE55413

RE55414
準不燃
巾92cm
防火種別2-3 AA 1,090円/㎡
防かび 抗菌 汚れ防止
▶ 施工注意
間接照明の場合など使用環境によって下地が目立つ商品です。 入念な下地処理を行い、糊ダマリに注意して施工してください。
糊付け後は大きくたたみ、折りジワに注意して、上積みは避けてください。

RE55415

RE55416

RE55417

RE55418
おだやかな質感の石目調。 キーカラーの4配色は、キッチンのアクセントにもおすすめです。

RE55419

RE55420

RE55421

RE55422
バリアタイプ」の施工上の注意につきましてはP.103をご参照ください。 一般ビニル壁紙と比較して施工難易度が高いため、施工費が割増しになる場合があります。
▶ 施工注意 「フィルム汚れ防止壁紙
イメージ写真を 全点見る 104
フィルム汚れ防止壁紙 バリアタイプ フィルム汚れ防止バリアタイプ

RE55425


RE55423 ロングセラ

RE55424 NEW
準不燃
防火種別2-3 AA 1,090円/㎡
巾92cm ↕32cm ↕ 46cm ● 無地貼可
防かび 抗菌 汚れ防止
▶ 施工注意

RE55427 NEW
準不燃
防火種別2-3 AA 1,090円/㎡
巾92cm ↕48.1cm ↕ 46.1cm
防かび 抗菌 汚れ防止
▶ 施工注意
間接照明の場合など使用環境によって下地が目立つ商品です。
入念な下地処理を行い、糊ダマリに注意して施工してください。

RE55425 ロングセラ

RE55426 NEW

RE55428 NEW
「フィルム汚れ防止壁紙 バリアタイプ」の施工上の注意につきましてはP.103をご参照ください。 一般ビニル壁紙と比較して施工難易度が高いため、施工費が割増しになる場合があります。
▶ 施工注意
RE55427・55428
ロングセラー イメージ写真を 全点見る 105

RE55429 リフォームおすすめ
準不燃
防火種別2-3 AA 1,090円/㎡
巾92.5cm ↕62.8cm ↕ 92.5cm エンボスリピート
防かび 抗菌 汚れ防止
▶ 施工注意

RE55431 NEW リフォームおすすめ
準不燃
防火種別2-3 AA 1,090円/㎡
巾92cm ↕12.8cm ↕ 15.4cm エンボスリピート
防かび 抗菌 汚れ防止
▶ 施工注意

RE55433 リフォームおすすめ
準不燃
防火種別2-3 AA 1,090円/㎡
巾92cm ↕31.8cm ↕ 92cm エンボスリピート
防かび 抗菌 汚れ防止
▶ 施工注意

RE55430
準不燃
防火種別2-3 AA 1,090円/㎡
巾92cm ↕20.9cm ↕ 30.8cm エンボスリピート
防かび 抗菌 汚れ防止
▶ 施工注意 製法やデザインの特性により、ジョイント部分 を正確に合わせることが困難です。

RE55432 NEW リフォームおすすめ


RE55434 リフォームおすすめ

▶
「フィルム汚れ防止壁紙 バリアタイプ」の施工上の注意につきましてはP.103をご参照ください。 一般ビニル壁紙と比較して施工難易度が高いため、施工費が割増しになる場合があります。
施工注意
RE55430
リフォームおすすめ イメージ写真を 全点見る 106
RE55429・55462
フィルム汚れ防止バリアタイプ

準不燃
防火種別2-3 AA 1,090円/㎡ 巾92cm ↕32.3cm ↕ 46.2cm エンボスリピート 防かび 抗菌 汚れ防止
▶ 施工注意

準不燃
防火種別2-3 AA 1,090円/㎡ 巾92.5cm ↕32cm ↕ 46.3cm エンボスリピート ● 無地貼可 防かび 抗菌 汚れ防止
▶ 施工注意

▶ 施工注意 「フィルム汚れ防止壁紙 バリアタイプ」の施工上の注意につきましてはP.103をご参照ください。 一般ビニル壁紙と比較して施工難易度が高いため、施工費が割増しになる場合があります。 RE55435 リフォームおすすめ ロングセラ RE55437 リフォームおすすめ


RE55438 リフォームおすすめ

ロングセラ
RE55436 リフォームおすすめ
RE55438
ロングセラー
イメージ写真を 全点見る 107
RE55435
リフォームおすすめ
フィルム汚れ防止壁紙 バリアタイプ




準不燃
防火種別2-3 AA 1,090円/㎡
巾92.5cm ↕64cm ↕ 92.5cm エンボスリピート
防かび 抗菌 汚れ防止
▶ 施工注意

準不燃
巾92cm
防火種別2-3 AA 1,090円/㎡
防かび 抗菌 表面強化 汚れ防止
▶ 施工注意

準不燃
巾92cm
防火種別2-3 AA 1,090円/㎡
防かび 抗菌 汚れ防止
▶ 施工注意

準不燃
巾92cm
防火種別2-3 AA 1,090円/㎡
防かび 抗菌 汚れ防止
▶ 施工注意
▶ 施工注意 「フィルム汚れ防止壁紙 バリアタイプ」の施工上の注意につきましてはP.103をご参照ください。 一般ビニル壁紙と比較して施工難易度が高いため、施工費が割増しになる場合があります。 RE55439 リフォームおすすめ ロングセラ RE55440 リフォームおすすめ ロングセラ RE55441 リフォームおすすめ ロングセラ RE55443 リフォームおすすめ ロングセラ RE55442 リフォームおすすめ ロングセラ RE55444 リフォームおすすめ ロングセラ RE55440 ロングセラー リフォームおすすめ イメージ写真を 全点見る 108
フィルム汚れ防止壁紙 バリアタイプ フィルム汚れ防止バリアタイプ
スーパー耐久性
フィルム汚れ防止壁紙 バリアタイプの 表面強度をさらにアップ
ペットのいるお部屋や壁にキズがつくのを防ぎ たい空間におすすめ。掲載商品の中で、最も表 面強度が高い壁紙です。


一般ビニル壁紙 スーパー耐久性 表面強化壁紙の約6倍の表面強度!
衝撃に強い壁紙
物を出し入れする空間にもおすすめ!衝撃に強 いスーパー耐久性は、物をぶつけやすいシュー ズクロークなどにもおすすめです。
清 潔 に保 ちたい 空間 に P O N T
フィルム汚れ防止壁紙 バリアタイプと同じく、エバー ル ®フィルムの効果で汚れやニオイの染み付きを防 止。抗菌性や耐薬品性など、清潔に保ちたい空間に うれしい機能も充実!
※「EVAL®」および「エバール®」は株式会社クラレのエチレン-ビニルア ルコール共重合樹脂の登録商標です。
各種機能性データ
ハ イ ボリューム タイプもお す すめ
RE5545 1 ~55453、RE5545 7 ~ 55459、RE55468、RE5546 9 ~ 55472は、厚みのあるハイボリューム タイプ。下地の凹凸をカバーする厚みと 表面強度を兼ね 備えています。
● サンゲツオリジナルのスーパー耐久性試験 ● 表面強化性能比較 スーパー耐久性はより厳しい表面強度の基準値を満たしています。
試験材 5回往復 15回往復 30回往復 スーパー耐久性 性能基準 (※自社基準) 5級 5級 4級以上
表面強化壁紙 性能基準 (※壁紙工業会規定) 4級以上 - -
[試験方法] 壁紙工業会規定 表面強化壁紙性能試験に準ずる。 [評価基準] 所定の摩擦子(荷重200g)を取り付け、5回・15回・30回往復させ、目視により 表面のキズつき度合いを評価する。
5級:�一見視で特に変化がみられない 4級:�多少表面キズがみられるが、比較的大きな表面層の破れなどはみられない 3級:�表面層の破れが明確にみえる
2級:�表面が破れて紙などの裏打ち材が明らかにみえる(長さ1cm未満) 1級:�表面が破れて紙などの裏打ち材が明らかにみえる(長さ1cm以上)
スーパー耐久性
表面強化壁紙 5回(4級保持) 0
※上記の試験結果は測定値であり、保証値ではありません。
※上記の試験結果は測定値であり、保証値ではありません。
▶「スーパー耐久性」の施工上の注意 モルタル・ベニヤ下地に施工する場合は、フクレやアクを防ぐため、シーラー処理をしてください。 オープンタイムは長めに取ってください。オープンタイム不足はフクレ等の原因になります。 糊付け後は大きくたたみ、折りジワや糊ダマリに注意して、上積みは避けてください。 エアーや水分が抜けにくく、特に低温時にはフクレが生じやすいためご注意ください。 出隅の納めの際は折り曲げた壁紙の表面からきれいな布でしっかりとおさえてください。 施工後は表面に付着した糊や汚れをきれいに拭き取ってください。拭き残しがあると変色の原因になります。 一般ビニル壁紙と比較して施工難易度が高いため、施工費が割増しになる場合があります。

5 10 15 20 25 30(回) 30回(4級保持)
P O N T 引っかきキズに強い P O N T
RE55455・55202 109


準不燃
防火種別2-3 AA

RE55452 NEW リフォームおすすめ



RE55453 NEW リフォームおすすめ スーパー耐久性 ハイボリュームタイプ

▶ 施工注意 「スーパー耐久性」の施工上の注意につきましてはP.109をご参照ください。 一般ビニル壁紙と比較して施工難易度が高いため、施工費が割増しになる場合があります。
スーパー耐久性 ハイボリュームタイプ
RE55451 リフォームおすすめ
RE55454
ハイボリュームタイプ
スーパー耐久性
RE55455
リフォームおすすめ イメージ写真を 全点見る 110
RE55456
1,090円/㎡ 巾92.5cm ↕32cm ↕ 46.4cm エンボスリピート 防かび 抗菌 表面強化 ス パ 耐久性 汚れ防止 ▶ 施工注意
防火種別2-3 AA 1,090円/㎡ 巾92cm ↕64.1cm ↕ 92cm 防かび 抗菌 表面強化 ス パ 耐久性 汚れ防止 ▶ 施工注意
スーパー耐久性 スーパー耐久性
準不燃
スーパー耐久性

ハイボリュームタイプ
スーパー耐久性

RE55457 リフォームおすすめ
準不燃
防火種別2-3 AA 1,090円/㎡
巾92.5cm ↕64.1cm ↕ 92.5cm エンボスリピート
防かび 抗菌 表面強化 ス パ 耐久性 汚れ防止
▶ 施工注意

RE55460
準不燃
巾92cm
防火種別2-3 AA 1,090円/㎡
防かび 抗菌 表面強化 ス パ 耐久性 汚れ防止
▶ 施工注意
ハイボリュームタイプ

RE55458 リフォームおすすめ
RE55459 NEW リフォームおすすめ


RE55461
▶ 施工注意 「スーパー耐久性」の施工上の注意につきましてはP.109をご参照ください。 一般ビニル壁紙と比較して施工難易度が高いため、施工費が割増しになる場合があります。

スーパー耐久性 ハイボリュームタイプ
RE55462
イメージ写真を 全点見る 111
RE55457
リフォームおすすめ
スーパー耐久性




準不燃
巾92cm
防火種別2-3 AA 1,090円/㎡
防かび 抗菌 表面強化 ス パ 耐久性 汚れ防止 ▶ 施工注意

準不燃
防火種別2-3 AA 1,090円/㎡
巾92.5cm ↕32.2cm ↕ 46.3cm ● 無地貼可 防かび 抗菌 表面強化 ス パ 耐久性 汚れ防止
▶ 施工注意
見る角度や環境によってジョイント部分が目立つ商品です。
▶ 施工注意 「スーパー耐久性」の施工上の注意につきましてはP.109をご参照ください。 一般ビニル壁紙と比較して施工難易度が高いため、施工費が割増しになる場合があります。 RE55463
準不燃
防火種別2-3 AA 1,090円/㎡ 巾92cm ↕30cm ↕ 46cm エンボスリピート 防かび 抗菌 表面強化 ス パ 耐久性 汚れ防止 ▶ 施工注意

準不燃
防火種別2-3 AA 1,090円/㎡
巾92cm ↕29.3cm ↕ 46cm エンボスリピート
防かび 抗菌 表面強化 ス パ 耐久性 汚れ防止 ▶ 施工注意
準不燃
防火種別2-3 AA 1,090円/㎡ 巾92.5cm ↕30.6cm ↕ 46.4cm エンボスリピート ● 無地貼可 防かび 抗菌 表面強化 ス パ 耐久性 汚れ防止 ▶ 施工注意

RE55465 RE55464 ロングセラ RE55466 RE55467 ロングセラ RE55468 スーパー耐久性 ハイボリュームタイプ
ロングセラー イメージ写真を 全点見る 112
RE55467
スーパー耐久性 スーパー耐久性

RE55469 NEW
準不燃
巾92cm
RE55470 NEW スーパー耐久性 ハイボリュームタイプ
防火種別2-3 AA 1,090円/㎡
防かび 抗菌 表面強化 ス パ 耐久性 汚れ防止
▶ 施工注意

ハイボリュームタイプ

RE55471 NEW
RE55472 NEW スーパー耐久性 ハイボリュームタイプ


RE55474

RE55473

RE55474
準不燃
準不燃 防火種別2-3 AA 1,090円/㎡ 巾92cm ↕32cm ↕ 46.2cm ● 無地貼可
防火種別2-3 AA 1,090円/㎡ 巾92cm 防かび 抗菌 表面強化 ス パ 耐久性 汚れ防止 ▶ 施工注意
施工注意
一般ビニル壁紙と比較して施工難易度が高いため、施工費が割増しになる場合があります。
▶ 施工注意 「スーパー耐久性」の施工上の注意につきましてはP.109をご参照ください。
スーパー耐久性 ハイボリュームタイプ
スーパー耐久性
ロングセラ
ロングセラ
ロングセラー イメージ写真を 全点見る 113
防かび 抗菌 表面強化 ス パ 耐久性 汚れ防止 ▶
スーパー耐久性









準不燃
防火種別2-3 AA 1,090円/㎡
巾92.5cm ↕32cm ↕ 46.4cm
防かび 抗菌 表面強化 ス パ 耐久性 汚れ防止 ▶ 施工注意


RE55483
RE55482 RE55481 RE55477
準不燃
巾92cm
防火種別2-3 AA 1,090円/㎡
見る角度や環境によってジョイント部分が目立つ商品です。
▶ 施工注意 「スーパー耐久性」の施工上の注意につきましてはP.109をご参照ください。 一般ビニル壁紙と比較して施工難易度が高いため、施工費が割増しになる場合があります。
RE55483
イメージ写真を 全点見る 114
RE55476 RE55475 RE55480 RE55479 RE55478
RE55475・55480・55181
防かび 抗菌 表面強化 ス パ 耐久性 汚れ防止 ▶ 施工注意
スーパー耐久性 スーパー耐久性
フィルム汚れ防止壁紙 バランスタイプ
水汚れに強く、施工性にも優れる
P O N T
水汚れを拭き取りやすい
水汚れに特化した汚れ防止 性能で、水まわりのメンテナ ンスもらくらく。表面のファ ンクレア®フィルムの効果で、 水拭きや中性洗剤を使用し て汚れを落とすことができ ます。
※�「 ファンクレア®」はグンゼ株式会 社の登録商標です。


ファンクレ
塩化ビニル樹脂層
汚れ成分
表面のフィルムに柔軟性があるため、 施工性にも優れます。施工性や仕上が りが気になる場所におすすめ。 裏打紙下地基材
一般ビニル壁紙 フィルム汚れ防止壁紙 バランスタイプ ※壁紙表面に水性ペンで汚れを付着させ、 中性洗剤で拭き取りを行った。
薬品成分
抗菌性・耐薬品性で衛生面が気に なる水まわりを清潔に保ちます。
各種機能性データ
● サンゲツオリジナルの柔軟性試験 ● 耐薬品性試験結果
フィルム汚れ防止壁紙 バランスタイプは、温度環境を問わず一般ビ ニル壁紙と同等程度の柔軟性を有します。
各種薬品に対する24時間後の耐薬品性能を評価しています。
フィルム汚れ防止壁紙
薬品名
(低温環境) 20℃ (常温環境) 30℃ (高温環境) フィルム汚れ防止壁紙
バランスタイプ 115mm 138mm 145mm
一般ビニル壁紙
(フィルムラミネート無し) 115mm 142mm 150mm
[試験方法]
机上に乗せた壁紙を机上の端から17cm程度押し出した際の、垂れ下 がった長さ(mm)を測定。
※数値が大きいほど、柔軟性が高いことを示します。
※上記の試験結果は測定値であり、保証値ではありません。
● 耐汚染性試験結果
各種汚染物質に対する24時間後の汚れ防止性能を評価しています。
汚染物質 フィルム汚れ防止壁紙 バランスタイプ 一般ビニル壁紙 水 中性洗剤 アルコール 水 中性洗剤 アルコール コーヒー ◎ ◎ ◎ △ △ △
醤油 ◎ ◎ ◎ × △ △ ソース ◎ ◎ ◎ ×× × × オレンジジュース ◎ ◎ ◎ ○ ◎ ◎
水性ペン ◎ ◎ × × ×
クレヨン ◎ ◎ ×× ×× ××
油性ペン △ ○ ×× ×× ××
口紅 △ × ×× × ×× 5℃
[試験方法]�
壁紙工業会規定 汚れ防止壁紙性能試験に準じる。
[評価基準]�
JIS L 0805に定める汚染用グレースケールを用い、汚染度合いを評価する。
◎:5級 汚れが残らない ◯:4級 ほとんど汚れが残らない △:3級 やや汚れが残る ×:2級 かなり汚れが残る ××:1級 汚れが濃く残る ※上記の試験結果は測定値であり、保証値ではありません。 ※色や柄によって試験結果は異なります。
バランスタイプ 一般ビニル壁紙
次亜塩素酸ナトリウム(6%) ◎ ○
無水エタノール(99.5vol%) ◎ ◎
アンモニア水(25%) ◎ ◎
過酸化水素水(3.5w/v%) ◎ ◎
ポピドンヨード(7%) ◎ ×
塩酸(9.5%) ◎ △
ベンザルコニウム水溶液(10%) ◎ △
ホルマリン液(37%) ◎ ◎
クレゾール石鹸液(3%) ◎ ◎
シンナー(原液) ◎ ○
ルゴール液(原液) △ ×
アクリノール(原液) ◎ ×
MEK(原液) ◎ △
[試験方法] JIS K 6902Bに準じ、汚染物質については当社基準による。
[評価基準] 色相変化および状態変化により総合評価を行う。
色相変化:�JIS L 0805に定める汚染用グレースケールを用い、汚染 度合いを評価する。
状態変化:�目視により外観の状態変化を評価する。
◎…変化なし ◯…軽微な変化 △…変化あり ×…明らかな変化

P O N
施
P O
衛生面も安心
T
工性に優れる
N T
ア ®フ ィ ル ム 層 ( 抗 菌 剤 入 り )
抗菌剤
RE55494・55491 115


RE55491 NEW リフォームおすすめ

RE55492 NEW リフォームおすすめ
準不燃
防火種別2-3 AA 1,090円/㎡
巾92.5cm ↕31.5cm ↕ 46.3cm エンボスリピート
防かび 抗菌 汚れ防止
▶ 施工注意

RE55495 NEW リフォームおすすめ
準不燃
防火種別2-3 AA 1,090円/㎡
巾92.5cm ↕31.4cm ↕ 92.5cm エンボスリピート
防かび 抗菌 汚れ防止
▶ 施工注意

RE55493 NEW リフォームおすすめ

RE55494 NEW リフォームおすすめ
ラフな凹凸感が使いやすい石目調壁紙。 ベーシックにお使いいただけます。

RE55496 NEW リフォームおすすめ
よりニュアンスのあるプリントとエンボスが魅力的。 少し温かみを感じるグレーに仕上げました。
▶「フィルム汚れ防止壁紙 バランスタイプ」の施工上の注意 モルタル・ベニヤ下地に施工する場合は、フクレやアクを防ぐため、シーラー処理をしてください。 オープンタイムは長めに取ってください。オープンタイム不足はフクレ等の原因になります。 糊付け後は大きくたたみ、折りジワや糊ダマリに注意して、上積みは避けてください。 エアーや水分が抜けにくく、特に低温時にはフクレが生じやすいためご注意ください。
出隅の納めの際は折り曲げた壁紙の表面からきれいな布でしっかりとおさえてください。 施工後は表面に付着した糊や汚れをきれいに拭き取ってください。拭き残しがあると変色の原因になります。 一般ビニル壁紙と比較して施工難易度が高いため、施工費が割増しになる場合があります。 壁紙:RE55495 床材:IS-2072-A(2023-2026 FLOOR TILE) リフォームおすすめ イメージ写真を 全点見る 116
フィルム汚れ防止壁紙 バランスタイプ フィルム汚れ防止 バランスタイプ


RE55497 NEW リフォームおすすめ

RE55498 NEW リフォームおすすめ
準不燃
防火種別2-3 AA 1,090円/㎡ 巾92cm
防かび 抗菌 汚れ防止
▶ 施工注意

RE55499 NEW リフォームおすすめ

RE55500 NEW リフォームおすすめ
▶ 施工注意 「フィルム汚れ防止壁紙 バランスタイプ」の施工上の注意につきましてはP.116をご参照ください。 一般ビニル壁紙と比較して施工難易度が高いため、施工費が割増しになる場合があります。
壁紙:RE55501・55504・55181
FLOOR TILE)



RE55503 NEW

RE55502 NEW RE55501 NEW
準不燃
防火種別2-3 AA 1,090円/㎡
巾92cm ↕32.1cm ↕ 46.2cm
防かび 抗菌 汚れ防止
▶ 施工注意
濃色の商品は、ひっかきキズや糊の拭き残しにご注意ください。

RE55504 NEW
床材:WD-2068(2023-2026
壁紙:RE55498
イメージ写真を
117
リフォームおすすめ
全点見る
RE55505・55586



RE55505 NEW
準不燃
防火種別2-3 AA 1,090円/㎡
巾92.5cm ↕64.1cm ↕ 92.5cm
防かび 抗菌 表面強化 汚れ防止
▶ 施工注意
糊付け後は大きくたたみ、折りジワや糊ダマリに注意して、上積みは避けてください。

RE55505(1目盛り10cm)

RE55506 NEW

RE55507 NEW
準不燃
防火種別2-3 AA 1,090円/㎡
巾92.5cm ↕32cm ↕ 46.3cm
防かび 抗菌 表面強化 汚れ防止
▶ 施工注意

RE55507(1目盛り10cm)
▶ 施工注意 「フィルム汚れ防止壁紙 バランスタイプ」の施工上の注意につきましてはP.116をご参照ください。 一般ビニル壁紙と比較して施工難易度が高いため、施工費が割増しになる場合があります。
RE55506
全点見る 118
イメージ写真を
フィルム汚れ防止壁紙 バランスタイプ フィルム汚れ防止 バランスタイプ
水性ペン
スーパークリーン
抜群の防汚性で、頑固な汚れもサッと一拭き
P O N T
汚れがとても落ちやすい
防汚性が非常に高く、水拭きや乾拭 きでも汚れが 落 とせる!
安 心・安 全 の 壁紙 P O N T
T-VOCがほとんど検出されない、安心・安全の環境対 応型壁紙。シックハウス症候群の原因とされる13 物質 を使用していません。また可塑剤不使用のオレフィン 樹脂壁紙です。
スーパークリーンの構造
UVの約1,000倍のエネルギーを持つ電子 線 (EB)を表面に照射した、高機能壁紙です。
EB(電子線)照射
EBコーティング層 (硬化技術)
フィルム層
EB樹脂層 (架橋技術)
EB照射イメージ図

は大日本印刷株式会社の登録商標です。
各種機能性データ
● 耐汚染性試験結果
油性ペンの汚れが 乾拭きで落ちる!
スーパークリーン 一般ビニル壁紙
水拭き前 水拭き後 水拭き前 水拭き後

油性ペン


スーパークリーン 一般ビニル壁紙
乾拭き前 乾拭き後 乾拭き前 乾拭き後



[試験方法]
水性ペン・油性ペンをそれぞれ付着させ、直ぐに水拭きおよび乾拭きした壁紙を目 視で確認する。
※壁紙の色柄やペンの種類、付着からの経過時間等により消去性には差があります。
● 耐薬品性試験結果
各種薬品に対する24時間後の耐薬品性能を評価しています。
薬品名 スーパークリーン 一般ビニル壁紙
次亜塩素酸ナトリウム ◎ 〇
無水エタノール ◎ ◎
アンモニア水 ◎ ◎
過酸化水素水 ◎ ◎ ポピドンヨード △ ×
塩酸 ◎ △ ベンザルコニウム水溶液 ◎ △ ホルマリン液 ◎ ◎ クレゾール石鹸液 ◎ ◎ シンナー ◎ 〇 ルゴール液 △ × アクリノール ◎ × MEK ◎ △
[試験方法]JIS K 6902Bに準じ、汚染物質については当社基準による。
[評価基準]色相変化および状態変化により総合評価を行う。
色相変化:�JIS L 0805に定める汚染用グレースケールを用い、汚染 度合いを評価する。
状態変化:�目視により外観の状態変化を評価する。
◎…変化なし ◯…軽微な変化 △…変化あり ×…明らかな変化
※上記の試験結果は測定値であり、保証値ではありません。
※色や柄によって試験結果は異なります。
▶「スーパークリーン」の施工上の注意 モルタル・ベニヤ下地に施工する場合は、フクレやアクを防ぐため、シーラー処理をしてください。 オープンタイムは長めに取ってください。オープンタイム不足はフクレ等の原因になります。 糊付け後は大きくたたみ、折りジワや糊ダマリに注意して、上積みは避けてください。 エアーや水分が抜けにくく、特に低温時にはフクレが生じやすいためご注意ください。 出隅の納めの際は折り曲げた壁紙の表面からきれいな布でしっかりとおさえてください。 施工後は表面に付着した糊や汚れをきれいに拭き取ってください。拭き残しがあると変色の原因になります。 表面にEB樹脂コートが施してあるため、テープやコーキングなど種類によっては表面につきにくいものがあります。 一般ビニル壁紙と比較して施工難易度が高いため、施工費が割増しになる場合があります。
ふっくらとした質感がやわらかい印象に仕上げてくれる、 グレージュカラーの織物調シリーズです。

壁紙:RE55512・55181 床材:WD-2023(2023-2026 FLOOR TILE)
架橋前 架橋後
119

RE55511 ロングセラ

RE55512 NEW
準不燃
巾92cm
防火種別2-3 AA 1,090円/㎡
防かび 抗菌 汚れ防止
▶ 施工注意

RE55513 NEW

RE55514 NEW


RE55515 ロングセラ

RE55516 NEW リフォームおすすめ
準不燃
防火種別2-3 AA 1,090円/㎡
巾92cm ↕23cm ↕ 46cm エンボスリピート
防かび 抗菌 汚れ防止
▶ 施工注意

RE55519 ロングセラ
準不燃
巾92cm
防火種別2-3 AA 1,090円/㎡
防かび 抗菌 汚れ防止
▶ 施工注意

RE55517 NEW リフォームおすすめ

RE55518 NEW リフォームおすすめ

RE55520 ロングセラ
準不燃
防火種別2-3 AA 1,090円/㎡
巾92cm ↕46.5cm ↕ 92cm エンボスリピート
防かび 抗菌 汚れ防止
▶ 施工注意
▶
一般ビニル壁紙と比較して施工難易度が高いため、施工費が割増しになる場合があります。
施工注意 「スーパークリーン」の施工上の注意につきましてはP.119をご参照ください。
壁紙:RE55515 カーテン:AC2285・2561(2023-2026 AC) ロングセラー リフォームおすすめ イメージ写真を 全点見る 120
スーパークリーン スーパークリーン
吸放湿量(
吸放湿壁紙
室内の湿気を快適にコントロール
結露やかびの発生を軽減 P O N T
壁紙に配合された吸水性ポリマーが湿気対策をお手伝い!湿度の変化に応じ て吸湿・放湿し、結露やかびの発生を軽減。
● 吸放湿性試験
[試験方法]
壁紙を石膏ボードに貼り付け試験体とする。
室温30℃ 湿度95%の状態で吸湿させた後、室温27℃ 湿度43%で放湿させた場合の重さの変化を測定する。
[試験結果]
g/ m 2 ) 0 40 60 20
湿度 95% 湿度 43%
吸放湿壁紙
一般ビニル壁紙
コップ 6杯分 の湿気を 吸収・放出 24 48 72 96 120 144 168 192 時間(h)
※6畳の部屋に施工した場合の理論値です。
※上記の試験結果は測定値であり、保証値ではありません。 ※環境や気候によって効果には差があります。

121



RE55531 NEW リフォームおすすめ

RE55532 NEW リフォームおすすめ

RE55533 NEW リフォームおすすめ
準不燃
防火種別2-3 AA 1,090円/㎡ 巾92cm 防かび 吸放湿 ウレタンコ ト
▶ 施工注意 濃色の商品は、ひっかきキズや糊の拭き残しにご注意ください。
アクセントにおすすめの可愛いカラーを取り入れた6配色。 お部屋のイメージをがらっと変えられます。
RE55534 NEW リフォームおすすめ

RE55535 NEW リフォームおすすめ

RE55536 NEW リフォームおすすめ
※親水性高分子ポリマーが空気中や接着剤の水分を吸収し、白い粉末状となって撫で刷毛等に付着することがありますが、
品質や性能には問題ございません。
壁紙:RE55535・55531 床材:WD-2023(2023-2026 FLOOR TILE) リフォームおすすめ イメージ写真を 全点見る 122
吸放湿壁紙 吸放湿

RE55537 リフォームおすすめ

RE55538 NEW リフォームおすすめ

RE55539 NEW リフォームおすすめ
ウレタンコ ト 準不燃
防火種別2-2 AA 1,090円/㎡ 巾92cm ↕29.4cm ↕ 46.2cm エンボスリピート 防かび 吸放湿

RE55540 リフォームおすすめ

RE55541 リフォームおすすめ

RE55542 リフォームおすすめ

※親水性高分子ポリマーが空気中や接着剤の水分を吸収し、白い粉末状となって撫で刷毛等に付着することがありますが、 品質や性能には問題ございません。
壁紙:RE55537・55542・55564
イメージ写真を 全点見る 123
床材:WD-2018(2023-2026 FLOOR TILE) リフォームおすすめ
吸放湿壁紙






防火種別2-3 AA 1,090円/㎡ 巾92cm
1,090円/㎡
防火種別2-3 AA 1,090円/㎡ 巾92.5cm ↕32cm ↕ 92.5cm エンボスリピート 防かび 吸放湿
防火種別2-3 AA 1,090円/㎡ 巾92cm ↕21cm ↕ 18.5cm エンボスリピート 防かび 吸放湿 ウレタンコ ト 準不燃
※親水性高分子ポリマーが空気中や接着剤の水分を吸収し、白い粉末状となって撫で刷毛等に付着することがありますが、品質や性能には問題ございません。 RE55543 RE55544 リフォームおすすめ RE55545 RE55546 ロングセラ
RE55543 ロングセラー リフォームおすすめ イメージ写真を 全点見る 124
RE55545
防かび
ウレタンコ ト 準不燃
吸放湿
防火種別2-3 AA
巾92cm 防かび 吸放湿 ウレタンコ ト 準不燃
ウレタンコ ト 準不燃
吸放湿






※親水性高分子ポリマーが空気中や接着剤の水分を吸収し、白い粉末状となって撫で刷毛等に付着することがありますが、品質や性能には問題ございません。 RE55547 ロングセラ RE55548 リフォームおすすめ ロングセラ RE55549 リフォームおすすめ ロングセラ RE55550 ロングセラ RE55548 RE55547・55783 ロングセラー リフォームおすすめ イメージ写真を 全点見る 125 防火種別2-2 AA
巾92cm 防かび 吸放湿 ウレタンコ ト 準不燃 防火種別2-3 AA 1,090円/㎡ 巾92cm 防かび 吸放湿 ウレタンコ ト 準不燃 防火種別2-3 AA
巾92cm 防かび 吸放湿 ウレタンコ ト 準不燃
巾92.4cm 防かび 吸放湿 ウレタンコ ト 準不燃
1,090円/㎡
1,090円/㎡
防火種別2-3 AA 1,090円/㎡







※親水性高分子ポリマーが空気中や接着剤の水分を吸収し、白い粉末状となって撫で刷毛等に付着することがありますが、品質や性能には問題ございません。 RE55551 RE55552 RE55553 リフォームおすすめ RE55554 リフォームおすすめ RE55551
RE55553 リフォームおすすめ イメージ写真を 全点見る 126 防火種別2-3 AA
巾92cm ↕62.8cm ↕ 92cm エンボスリピート ● 無地貼可 防かび 吸放湿 ウレタンコ ト 準不燃
巾92.5cm ↕63cm ↕ 46.4cm エンボスリピート 防かび 吸放湿 ウレタンコ ト 準不燃
巾92cm 防かび 吸放湿 ウレタンコ
吸放湿
RE55552
1,090円/㎡
防火種別2-3 AA 1,090円/㎡
防火種別2-3 AA 1,090円/㎡
ト 準不燃
通気性壁紙
高い通気性で、壁を通して湿気を排出
結露やかびに強い P O N T
お部屋の湿気を外に逃して結露やかびの発生リスクを軽減。
一般ビニル壁紙と比較して通気性に優れています。
機能性石膏 ボ ドとの 組 み合 わ せがおすすめ
塩ビ樹脂 下地(石膏ボード)
調湿やホルムアルデヒド低減などの 機能性付き石膏ボードの性能を阻 害しにくい商品構造です。
● 透湿度データ

室内側 裏打紙

湿気 空気

壁紙:RE55561 床材:WD-2023(2023-2026 FLOOR TILE)
RE55564
壁紙 透湿度(g/m2・24h) 通気性壁紙(RE55569) 2,700
一般ビニル壁紙 240 [試験方法]�
JIS Z 0208 B法に準ずる。 条件:40℃・90% 上記の条件で24時間に試験体(壁紙)透過する水蒸気質量を1m2あたりに換算する。
※�上記の試験結果は測定値であり、保証値ではありません。
※�試験結果は代表品番によるものであり、数値は商品によって異なります。
▶「通気性壁紙」の選択上の注意
施工時に使用した糊が乾燥するまで、黒いシミのように製品表面に見える場合があります。この症状は乾燥後には解消するものであり、 製品異常ではありません。
また通気性を高めるため、裏打紙が壁紙表面に露出している箇所が多く、一般ビニル壁紙と比較して水汚れを若干吸い込みやすくなって います。
水が頻繁にかかる場所や過度に湿度の高い場所に使用すると、カビの原因になることがありますのでご注意ください。

127

RE55561 リフォームおすすめ ロングセラ
準不燃
巾92cm
防火種別2-3 AA 1,090円/㎡
抗 アレ ル
防かび 通気性
▶ 選択上の注意

RE55563
準不燃
巾92cm
防火種別2-3 AA 1,090円/㎡
抗 アレ ル
防かび 通気性
▶ 選択上の注意

RE55565 NEW
準不燃
防火種別2-3 AA 1,090円/㎡
抗 アレ ル
巾92cm ↕32cm ↕ 46.2cm
防かび 通気性
▶ 選択上の注意

RE55562 リフォームおすすめ ロングセラ
準不燃
防火種別2-3 AA 1,090円/㎡
抗 アレ ル
巾92cm ↕32cm ↕ 46cm
防かび 通気性
▶ 選択上の注意

RE55564 リフォームおすすめ
準不燃
防火種別2-3 AA 1,090円/㎡
抗 アレ ル
巾92.5cm ↕32cm ↕ 46.3cm 防かび 通気性
▶ 選択上の注意

RE55566 NEW
▶ 選択上の注意 「通気性壁紙」の選択上の注意につきましてはP.127をご参照ください。

RE55567 リフォームおすすめ
準不燃
防火種別2-3 AA 1,090円/㎡
抗 アレ ル
巾92cm ↕32cm ↕ 46.2cm
防かび 通気性
▶ 選択上の注意

RE55569 リフォームおすすめ
準不燃
巾92cm
防火種別2-3 AA 1,090円/㎡
抗 アレ ル
防かび 通気性
▶ 選択上の注意

RE55571 NEW
準不燃
巾92cm
防火種別2-3 AA 1,090円/㎡
抗 アレ ル
防かび 通気性
▶ 選択上の注意

RE55568 リフォームおすすめ ロングセラ
準不燃
防火種別2-3 AA 1,090円/㎡
抗 アレ ル
巾92cm ↕32cm ↕ 30.8cm 防かび 通気性
▶ 選択上の注意

RE55570 リフォームおすすめ
準不燃
抗 アレ ル
防火種別2-3 AA 1,090円/㎡ 巾92cm ↕32.1cm ↕ 46.2cm ● 無地貼可 防かび 通気性
▶ 選択上の注意

RE55572 NEW
ロングセラー
イメージ写真を 全点見る 128
リフォームおすすめ
通気性壁紙 通気性


RE55581 NEW

RE55582 NEW

RE55583 NEW リフォームおすすめ
準不燃
防火種別2-3 AA 1,080円/㎡ 巾93cm ↕125cm ↕ 93cm 木種:ウォルナット
防かび
▶ 施工注意
商品特性上、ベース原反に着色をしていないため、施工環境、条件、品番によってジョイン ト部分が白いライン状に目立ちます。
また断面がより目立ちやすくなるため、突き付けでの施工を避け、重ね切りで施工してく ださい。重ね切り施工時、カッターが斜めに入るとカット断面が目立ちやすくなるため、 必ず垂直に入れていただき、また、下地を切らないようにご注意ください。
特に濃色の商品については、目立ちやすくなるためご注意ください。

巾なり93cm RE55582
定番のウォルナット柄は高級感のあるインテリア におすすめです。
壁紙:RE55583・55229 カーテン:AC2437(2023-2026 AC) イメージ写真を 全点見る 129
木目 木 目

RE55584 NEW リフォームおすすめ

RE55585 NEW リフォームおすすめ

RE55586 NEW リフォームおすすめ
準不燃
防火種別2-3 AA 1,090円/㎡ 巾92cm ↕90cm ↕ 92cm 木種:チェスナット 防かび 抗菌
吸放湿 撥水

巾なり92cm RE55585
抑揚のある質感と表情が雰囲気を高めてくれる チェスナット柄です。

壁紙:RE55584 床材:WD-2031-W(2023-2026 FLOOR TILE) リフォームおすすめ イメージ写真を 全点見る 130
木 目



準不燃
防火種別2-3 AA 1,080円/㎡ 巾93cm ↕125cm ↕ 93cm 木種:チーク
防かび
▶ 施工注意
商品特性上、ベース原反に着色をしていないため、施工環境、条件、品番によってジョイン ト部分が白いライン状に目立ちます。
また断面がより目立ちやすくなるため、突き付けでの施工を避け、重ね切りで施工してく ださい。重ね切り施工時、カッターが斜めに入るとカット断面が目立ちやすくなるため、 必ず垂直に入れていただき、また、下地を切らないようにご注意ください。 特に濃色の商品については、目立ちやすくなるためご注意ください。


RE55589(1目盛り10cm)
RE55588
RE55587
RE55588・55311・55422
全点見る 131
RE55589
イメージ写真を
厚みがあり、ベーシックに使いやすいチーク材の柄です。 木目 木 目





準不燃
防火種別2-3 AA 1,090円/㎡ 巾92cm ↕79.8cm ↕ 92cm 木種:オーク
防かび 抗菌
吸放湿 撥水
▶ 施工注意 濃色の商品は、ひっかきキズや糊の拭き残しにご注意ください。
 RE55590(1目盛り10cm)
RE55591
RE55590
RE55590(1目盛り10cm)
RE55591
RE55590
壁紙:RE55591・55721・55723 床材:WD-2085(2023-2026 FLOOR TILE)
RE55592
イメージ写真を 全点見る 132
RE55590・55235
木目 木 目
リフォームおすすめ

RE55593 リフォームおすすめ

RE55594 リフォームおすすめ
準不燃
防火種別2-3 AA 1,090円/㎡ 巾92.5cm ↕64.2cm ↕ 92.5cm 板巾:約11.6cm 木種:オーク 防かび

RE55595 NEW

RE55596 NEW リフォームおすすめ
準不燃
防火種別2-3 AA 1,090円/㎡ 巾92cm ↕124cm ↕ 92cm 木種:オーク 防かび

RE55594(1目盛り10cm)

壁紙:RE55595・55651・55172 床材:IS-2100(2023-2026 FLOOR TILE)

RE55596(1目盛り10cm)
 RE55593
RE55593
イメージ写真を 全点見る 133
木目 木 目
希少性から実物をインテリアに取り入れるのが難 しいオリーブの木。その特徴的な木目をリアルに 再現した壁紙です。


RE55597 NEW
準不燃
防火種別2-3 AA 1,090円/㎡ 巾92cm ↕124cm ↕ 92cm 木種:オリーブ 防かび

温かみのある色合いとマットな質感が可愛いらし いアップルの木目柄です。

人気のレッドシダー柄を、天井にも使いやすい目 地ありのデザインに仕上げました。
壁紙:RE55598 カーテン:AC2553(2023-2026 AC) 床材:IS-2074-B(2023-2026 FLOOR TILE) RE55599・55483・55233

RE55598 NEW
準不燃
防火種別2-3 AA 1,090円/㎡ 巾92cm ↕125cm ↕ 92cm 木種:アップル 防かび



RE55599 NEW
準不燃
防火種別2-3 AA 1,090円/㎡ 巾92cm ↕124cm ↕ 92cm 木種:レッドシダー 防かび

RE55598(1目盛り10cm)
RE55597(1目盛り10cm) RE55599(1目盛り10cm)
RE55597
イメージ写真を 全点見る 134
木 目



準不燃
防火種別2-3 AA 1,090円/㎡ 巾92cm ↕64cm ↕ 92cm 板巾:約9.2cm 防かび 抗菌 表面強化 抗ウイルス ウレタンコ ト 吸放湿 撥水


準不燃
防火種別2-3 AA 1,080円/㎡ 巾93cm ↕94cm ↕ 93cm 防かび



準不燃
防火種別2-3 AA 1,090円/㎡ 巾92.5cm ↕64.2cm ↕ 92.5cm 防かび

RE55601(1目盛り10cm) RE55602(1目盛り10cm) RE55600(1目盛り10cm)
ウレタンコート
RE55600 リフォームおすすめ ロングセラ
RE55601 ロングセラ
RE55602
RE55600
RE55601
ロングセラー
イメージ写真を 全点見る 135
RE55602
リフォームおすすめ
木 目
壁紙:RE55603・55181
床材:IS-2124(2023-2026 FLOOR TILE)


壁紙:RE55604・55181
床材:WD-2058(2023-2026 FLOOR TILE) RE55605・55613・55229


RE55603 NEW RE55604 NEW
準不燃
防火種別2-3 AA 1,090円/㎡
巾92cm ↕93cm ↕ 92cm 防かび
準不燃
防火種別2-3 AA 1,090円/㎡


準不燃

巾92.5cm ↕61.3cm ↕ 46.3cm 防かび 抗菌
▶ 施工注意
吸放湿 撥水
商品特性上、ベース原反に着色をしていないため、施工環境、条件、品番によってジョイン ト部分が白いライン状に目立ちます。また断面がより目立ちやすくなるため、突き付けで の施工を避け、重ね切りで施工してください。重ね切り施工時、カッターが斜めに入ると カット断面が目立ちやすくなるため、必ず垂直に入れていただき、また、下地を切らないよ うにご注意ください。特に濃色の商品については、目立ちやすくなるためご注意ください。

防火種別2-3 AA 1,090円/㎡ 巾92cm ↕124cm ↕ 92cm 防かび
▶ 施工注意
濃色の商品は、ひっかきキズや糊の拭き残しにご注意ください。

巾なり92cm RE55603 巾なり92cm RE55605 巾なり92.5cm RE55604
リフォームおすすめ
RE55605 NEW
リフォームおすすめ イメージ写真を 全点見る 136
木 目
コンクリート・ストーン








ロングセラ ウレタンコート
ウレタンコート
ロングセラ ウレタンコート RE55613 ウレタンコート RE55612 ウレタンコート RE55611 ウレタンコート RE55613・55616 RE55614 ロングセラー イメージ写真を 全点見る 137 防火種別2-3 AA 1,090円/㎡ 巾92cm ↕64cm ↕ 92cm 防かび 抗菌 表面強化 抗ウイルス ウレタンコ ト 吸放湿 撥水 準不燃
RE55616
RE55615
RE55614

RE55617 NEW リフォームおすすめ

RE55618 NEW リフォームおすすめ

RE55619 NEW リフォームおすすめ
準不燃
防火種別2-3 AA 1,090円/㎡
吸放湿
巾92cm ↕63.8cm ↕ 92cm
防かび 抗菌
▶ 施工注意

NEW リフォームおすすめ

NEW リフォームおすすめ

RE55622 NEW リフォームおすすめ
撥水
濃色の商品は、ひっかきキズや糊の拭き残しにご注意ください。
MOTTLED RUST
Designed by MIKIYA KOBAYASHI
 RE55621
RE55620
RE55621
RE55620
壁紙:RE55621 床材:IS-2071-B(2023-2026 FLOOR TILE) リフォームおすすめ イメージ写真を 全点見る 138
ストーン
コンクリート・

RE55623 NEW

RE55624 NEW

RE55625 NEW
準不燃
防火種別2-3 AA 1,090円/㎡ 巾92cm ↕124cm ↕ 92cm 防かび

巾なり92cm RE55624
パールで抑揚を再現した美しいモルタル調。
照明効果で静かに煌めく光沢感が魅力。

RE55625・55215
全点見る 139
イメージ写真を
コンクリート・ストーン

壁紙:RE55627・55237
床材:WD-2061(2023-2026 FLOOR TILE)

壁紙:RE55629・55583
床材:WD-2058(2023-2026 FLOOR TILE)
コンクリート・ストーン

RE55626 NEW

RE55627 NEW
準不燃
防火種別2-3 AA 1,090円/㎡
巾92cm ↕90cm ↕ 92cm
防かび 抗菌 吸放湿 撥水

RE55628 NEW リフォームおすすめ

RE55629 NEW リフォームおすすめ
準不燃
防火種別2-3 AA 1,090円/㎡
巾92cm ↕125cm ↕ 92cm
防かび
▶ 施工注意 商品特性上、ベース原反に着色をしていないため、施工環境、条件、品番 によってジョイント部分が白いライン状に目立ちます。 また断面がより目立ちやすくなるため、突き付けでの施工を避け、重ね切 りで施工してください。重ね切り施工時、カッターが斜めに入るとカット 断面が目立ちやすくなるため、必ず垂直に入れていただき、また、下地を 切らないようにご注意ください。特に濃色の商品については、目立ちやす くなるためご注意ください。

巾なり92cm
RE55626
塗りのテクスチャーがリアルなモルタル調。 ナチュラルな色味に仕上げました。

巾なり92cm
RE55628
ラフなテクスチャーのコンクリート柄。 落ち着いたモダンな空間を演出します。
リフォームおすすめ イメージ写真を 全点見る 140
コンクリート・ストーン

RE55630 NEW リフォームおすすめ

RE55631 NEW リフォームおすすめ
準不燃
防火種別2-3 AA 1,080円/㎡ 巾93cm ↕125cm ↕ 93cm 防かび
▶ 施工注意

RE55632 NEW リフォームおすすめ

RE55633 NEW リフォームおすすめ
準不燃
防火種別2-3 AA 1,090円/㎡ 巾92.5cm ↕87.5cm ↕ 92.5cm 防かび 抗菌 表面強化
吸放湿 撥水

巾なり93cm RE55630

壁紙:RE55630・55229 床材:WD-2060(2023-2026 FLOOR TILE)

巾なり92.5cm RE55632

RE55633・55462
▶ 施工注意 商品特性上、ベース原反に着色をしていないため、施工環境、条件、品番によってジョイント部分が白いライン状に目立ちます。また断面がより目立ち やすくなるため、突き付けでの施工を避け、重ね切りで施工してください。重ね切り施工時、カッターが斜めに入るとカット断面が目立ちやすくなる ため、必ず垂直に入れていただき、また、下地を切らないようにご注意ください。特に濃色の商品については、目立ちやすくなるためご注意ください。
イメージ写真を 全点見る 141
リフォームおすすめ
コンクリート・ストーン
壁紙:RE55634
床材:IS-2071-B(2023-2026 FLOOR TILE)



ウレタンコート RE55635
RE55634
準不燃
防火種別2-3 AA 1,090円/㎡
巾92cm ↕64cm ↕ 46.2cm 防かび 抗菌 表面強化 抗ウイルス ウレタンコ ト 吸放湿 撥水

巾なり92cm RE55634
リフォームおすすめ

準不燃
防火種別2-3 AA 1,090円/㎡
巾92cm ↕64.2cm ↕ 92cm 防かび

巾なり92cm RE55635


リフォームおすすめ RE55636
準不燃
防火種別2-3 AA 1,090円/㎡
巾92.5cm ↕61.3cm ↕ 92.5cm 防かび 抗菌 吸放湿 撥水 ▶ 施工注意 商品特性上、ベース原反に着色をしていないため、施工環境、条件、品番によってジョイン ト部分が白いライン状に目立ちます。

巾なり92.5cm RE55636
また断面がより目立ちやすくなるため、突き付けでの施工を避け、重ね切りで施工してく ださい。重ね切り施工時、カッターが斜めに入るとカット断面が目立ちやすくなるため、 必ず垂直に入れていただき、また、下地を切らないようにご注意ください。 特に濃色の商品については、目立ちやすくなるためご注意ください。
RE55635
リフォームおすすめ イメージ写真を 全点見る 142
RE55636
コンクリート・ストーン



準不燃
防火種別2-3 AA 1,090円/㎡
巾92.5cm ↕64.2cm ↕ 92.5cm 防かび 抗菌 吸放湿 撥水

巾なり92.5cm RE55637

防火種別2-3 AA 1,090円/㎡
巾92cm ↕31.5cm ↕ 92cm エンボスリピート
防かび
▶ 施工注意
間接照明の場合など使用環境によって下地が目立つ商品です。
入念な下地処理を行い、糊ダマリに注意して施工してください。 準不燃

RE55639(1目盛り10cm)
RE55639・55589・55181 リフォームおすすめ

RE55637 リフォームおすすめ RE55638 リフォームおすすめ RE55639
RE55638
イメージ写真を 全点見る 143
コンクリート・ストーン

準不燃
防火種別2-3 AA 1,090円/㎡
巾92cm ↕64.1cm ↕ 92cm 防かび

RE55640(1目盛り10cm)


準不燃
防火種別2-3 AA 1,090円/㎡
巾92.5cm ↕64cm ↕ 92.5cm 防かび 抗菌

RE55641(1目盛り10cm)

準不燃
防火種別2-3 AA 1,090円/㎡
巾92cm ↕94.1cm ↕ 92cm 防かび

RE55642(1目盛り10cm)

RE55640 RE55641 壁紙:RE55642・55239
床材:WD-2072(2023-2026

RE55641 リフォームおすすめ RE55642 NEW リフォームおすすめ
RE55640 リフォームおすすめ
FLOOR TILE) リフォームおすすめ イメージ写真を 全点見る 144
吸放湿
撥水
コンクリート・ストーン コンクリート・ストーン
タイル・レンガ
壁紙:RE55651・55229
床材:WD-2069(2023-2026 FLOOR TILE)


RE55651 NEW

RE55652 NEW

RE55653 NEW
準不燃
防火種別2-3 AA 1,090円/㎡ 巾92cm ↕64.1cm ↕ 92cm 防かび 抗菌

RE55653(1目盛り10cm)
タイルの質感をリアルに再現した柄。 モダンなお部屋のアクセントにおすすめです。
145
イメージ写真を 全点見る

RE55654 NEW リフォームおすすめ
準不燃
防火種別2-3 AA 1,090円/㎡
巾92cm ↕93cm ↕ 92cm
防かび

RE55655 リフォームおすすめ

RE55656 リフォームおすすめ
準不燃
防火種別2-3 AA 1,090円/㎡
巾92cm ↕84.3cm ↕ 92cm
防かび
▶ 施工注意
柄の特性上、表面がややキズつきやすいため、施工やメンテナンスの際は慎重にお取り扱 いください。

巾なり92cm RE55654

巾なり92cm RE55655

壁紙:RE55654・55181 カーテン:AC2561(2023-2026 AC)

リフォームおすすめ イメージ写真を 全点見る 146
RE55656
タイル・レンガ
リフォームおすすめ

RE55657 リフォームおすすめ

RE55658 リフォームおすすめ
準不燃
防火種別2-3 AA 1,090円/㎡
巾92.5cm ↕64cm ↕ 92.5cm
防かび

RE55659 NEW

RE55660 NEW
準不燃
防火種別2-3 AA 1,090円/㎡

RE55657(1目盛り10cm)

RE55659・55936

RE55660(1目盛り10cm)
巾92.5cm ↕61.2cm ↕ 92.5cm
防かび 抗菌 吸放湿 撥水
▶ 施工注意
柄の特性上、表面がややキズつきやすいため、施工やメンテナンスの際は慎重にお取り扱 いください。
製法やデザインの特性により、ジョイント部分を正確に合わせることが困難です。
 RE55658
RE55658
全点見る 147
イメージ写真を
タイル・レンガ

ルームエアー(消臭)
RE55662


RE55661 リフォームおすすめ

RE55662 リフォームおすすめ
準不燃
防火種別2-3 AA 1,090円/㎡

RE55661(1目盛り10cm)
ルームエアー(消臭)
巾92.5cm ↕32cm ↕ 46.3cm エンボスリピート
防かび 抗菌
吸放湿 撥水

RE55663 リフォームおすすめ

RE55664
準不燃
防火種別2-3 AA 1,090円/㎡
巾92cm ↕31.6cm ↕ 46.1cm エンボスリピート
防かび 抗菌 消臭

RE55663(1目盛り10cm)
リフォームおすすめ
リフォームおすすめ
RE55664
イメージ写真を 全点見る 148
タイル・レンガ タイル・レンガ

壁紙:RE55666 スマートジョイナー:SRJ-251


RE55665

RE55666
準不燃
防火種別2-3 AA 1,090円/㎡

RE55665(1目盛り10cm)
柄合せについて 特殊なリピート構成となっています。1巾(92cm)ごとに 左側を18cmずつ上げて柄合せをしてください。 ※要尺計算の際はご注意ください。

巾92cm ↕32cm ↕ 92cm ● ステップ柄合せ
防かび 抗菌
吸放湿 撥水
▶ 施工注意 柄の特性上、表面がややキズつきやすいため、施工やメンテナンスの際 は慎重にお取り扱いください。

RE55667 NEW リフォームおすすめ

RE55668 NEW リフォームおすすめ
準不燃
防火種別2-3 AA 1,090円/㎡
巾92cm ↕32cm ↕ 92cm
防かび 抗菌

RE55667(1目盛り10cm)
吸放湿 撥水
RE55668 リフォームおすすめ イメージ写真を 全点見る 149

RE55669

RE55670
準不燃
防火種別2-3 AA 1,090円/㎡
吸放湿
巾92cm ↕21.4cm ↕ 92cm
防かび 抗菌
▶ 施工注意
撥水
間接照明の場合など使用環境によって下地が目立つ商品です。 入念な下地処理を行い、糊ダマリに注意して施工してください。

RE55671

RE55672
準不燃
防火種別2-3 AA 1,090円/㎡
吸放湿
巾92.5cm ↕64.1cm ↕ 92.5cm
防かび 抗菌
▶ 施工注意

RE55669(1目盛り10cm)

撥水
製法やデザインの特性により、ジョイント部分を正確に合わせることが困難です。
濃色の商品は、ひっかきキズや糊の拭き残しにご注意ください。

RE55672(1目盛り10cm)
 RE55669
RE55669
イメージ写真を 全点見る 150
RE55672
タイル・レンガ




準不燃
防火種別2-3 AA 1,090円/㎡
巾92cm ↕32cm ↕ 46.2cm エンボスリピート 防かび 抗菌 ▶ 施工注意 見る角度や環境によってジョイント部分が目立つ商品です。


準不燃
防火種別2-3 AA 1,090円/㎡

準不燃
防火種別2-3 AA 1,090円/㎡
巾92.5cm ↕62.6cm ↕ 46.4cm エンボスリピート 防かび 抗菌
吸放湿 撥水

巾92.5cm ↕63.5cm ↕ 92.5cm エンボスリピート 防かび 抗菌
※タイル面によって質感が異なる商品です。施工例写真やサンプル等でご確認ください。

RE55673(1目盛り10cm)
RE55674(1目盛り10cm) RE55675(1目盛り10cm)
RE55673
RE55674
RE55675
RE55673
RE55674
イメージ写真を 全点見る 151
RE55675



準不燃
防火種別2-3 AA 1,090円/㎡ 巾92cm ↕32cm ↕ 46cm 防かび 表面強化 抗ウイルス ウレタンコ ト


準不燃
防火種別2-3 AA 1,090円/㎡ 巾92.5cm ↕63.9cm ↕ 92.5cm エンボスリピート 防かび 抗菌
吸放湿 撥水



準不燃
防火種別2-3 AA 1,090円/㎡ 巾92cm ↕32cm ↕ 46.2cm 防かび 抗菌 表面強化 抗ウイルス ウレタンコ ト 吸放湿 撥水

RE55678(1目盛り10cm) RE55676(1目盛り10cm) RE55676
RE55677(1目盛り10cm)
ロングセラ
RE55677
RE55678
ウレタンコート
リフォームおすすめ
ウレタンコート
RE55676
ロングセラー
イメージ写真を 全点見る 152
RE55677 RE55678・55593
リフォームおすすめ
タイル・レンガ




準不燃
防火種別2-3 AA 1,090円/㎡
巾92.5cm ↕64.1cm ↕ 92.5cm 防かび 抗菌 吸放湿 撥水

準不燃
防火種別2-3 AA 1,090円/㎡

準不燃
防火種別2-3 AA 1,090円/㎡
リフォームおすすめ

巾92.5cm ↕64cm ↕ 92.5cm 防かび 抗菌
吸放湿 撥水

巾92.5cm ↕64cm ↕ 46.4cm 防かび

RE55681(1目盛り10cm) RE55680(1目盛り10cm) RE55679(1目盛り10cm) RE55679 リフォームおすすめ RE55680 リフォームおすすめ RE55681 リフォームおすすめ
RE55679
RE55680
RE55681
イメージ写真を 全点見る 153



準不燃
防火種別2-3 AA 1,090円/㎡
巾92cm ↕64cm ↕ 46cm 防かび 抗菌 表面強化 抗ウイルス ウレタンコ ト 吸放湿 撥水


準不燃
防火種別2-3 AA 1,080円/㎡ 巾93cm ↕60.6cm ↕ 46.5cm 防かび



準不燃
防火種別2-3 AA 1,090円/㎡ 巾92cm ↕93cm ↕ 92cm 防かび

RE55683(1目盛り10cm) RE55684(1目盛り10cm) RE55682(1目盛り10cm) RE55682 リフォームおすすめ ロングセラ ウレタンコート RE55683 ロングセラ RE55684 NEW リフォームおすすめ
RE55682
RE55683
ロングセラー リフォームおすすめ イメージ写真を 全点見る 154
RE55684・55100
タイル・レンガ


RE55691 NEW リフォームおすすめ

RE55692 リフォームおすすめ ロングセラ

RE55693 NEW リフォームおすすめ
準不燃
防火種別2-3 AA 1,090円/㎡
巾92.5cm ↕46cm ↕ 92.5cm
防かび
▶ 施工注意
濃色の商品は、ひっかきキズや糊の拭き残しにご注意ください。

RE55694 NEW リフォームおすすめ

RE55695 NEW リフォームおすすめ

RE55696 NEW リフォームおすすめ
出隅・入隅への施工の際に、硬い刷毛や布などで強く擦ると表面が白化します。
壁紙:RE55693・55727・55229 床材:WD-2051(2023-2026 FLOOR TILE) ロングセラー リフォームおすすめ イメージ写真を 全点見る 155
和 和

RE55697 NEW リフォームおすすめ
準不燃
防火種別2-3 AA 1,090円/㎡
巾92cm ↕64cm ↕ 92cm
防かび 抗菌 吸放湿 撥水
ルームエアー(消臭)
RE55699 ロングセラ ルームエアー(消臭)
ルームエアー(消臭)

ルームエアー(消臭)

RE55700 リフォームおすすめ ロングセラ
準不燃
防火種別2-3 AA 1,090円/㎡
巾92.5cm ↕21.4cm ↕ 30.9cm
防かび 抗菌 消臭
▶ 施工注意
濃色の商品は、ひっかきキズや糊の拭き残しにご注意ください。

RE55698 NEW リフォームおすすめ

RE55701 リフォームおすすめ ロングセラ

RE55702 リフォームおすすめ ロングセラ

壁紙:RE55698・55697 床材:GT-2002-T(2023-2026 FLOOR TILE)
 RE55699
RE55699
ロングセラー リフォームおすすめ イメージ写真を 全点見る 156
和
リフォームおすすめ

RE55703 リフォームおすすめ

RE55704 リフォームおすすめ
準不燃
防火種別2-3 AA 1,090円/㎡
巾92cm ↕64.2cm ↕ 92cm
防かび 抗菌

RE55705 リフォームおすすめ

RE55706 リフォームおすすめ
準不燃
防火種別2-3 AA 1,090円/㎡
巾92.5cm ↕46.1cm ↕ 46.3cm 防かび 抗菌 吸放湿

RE55703(1目盛り10cm)

RE55704・55655・55593

RE55706(1目盛り10cm)
 RE55705
RE55705
イメージ写真を 全点見る 157
撥水
和 和



RE55707 リフォームおすすめ

RE55708 リフォームおすすめ
準不燃
防火種別2-3 AA 1,090円/㎡
巾92cm ↕75cm ↕ 92cm
防かび
▶ 施工注意
濃色の商品は、ひっかきキズや糊の拭き残しにご注意ください。

RE55709 NEW リフォームおすすめ

RE55710 NEW リフォームおすすめ
準不燃
防火種別2-3 AA 1,090円/㎡
吸放湿
巾92cm ↕30.4cm ↕ 30.8cm エンボスリピート
防かび 抗菌
▶ 施工注意
撥水
濃色の商品は、ひっかきキズや糊の拭き残しにご注意ください。

RE55708(1目盛り10cm)

RE55709(1目盛り10cm)
リフォームおすすめ
RE55710・55036
RE55707
イメージ写真を 全点見る 158
和 和



RE55711 NEW リフォームおすすめ
準不燃
防火種別2-3 AA 1,090円/㎡
巾92.5cm ↕64cm ↕ 92.5cm エンボスリピート
防かび

RE55713 リフォームおすすめ ロングセラ
準不燃
巾92cm
防かび
防火種別2-3 AA 1,090円/㎡

RE55715 NEW リフォームおすすめ
準不燃
防火種別2-3 AA 1,090円/㎡
巾92cm ↕93cm ↕ 92cm
防かび

RE55712 リフォームおすすめ ロングセラ

RE55714 リフォームおすすめ ロングセラ

RE55716 NEW リフォームおすすめ
壁紙:RE55716・55692 床材:GT-2001-T(2023-2026 FLOOR TILE) RE55712 ロングセラー リフォームおすすめ イメージ写真を 全点見る 159
和


RE55719 NEW 杉柾目 RE55717 NEW リフォームおすすめ
防火種別2-3 AA 1,090円/㎡ 巾92cm ↕78.8cm ↕ 92cm
防かび
▶ 施工注意

準不燃
防火種別2-3 AA 1,090円/㎡
巾92.5cm ↕20.7cm ↕ 18.5cm
防かび
▶ 施工注意
濃色の商品は、ひっかきキズや糊の拭き残しにご注意ください。


RE55718(1目盛り10cm)

巾なり92cm
RE55719
商品特性上、ベース原反に着色をしていないため、施工環境、条件、品番によってジョイント部分が白いライン状に目立ちます。また断面がより目立ち やすくなるため、突き付けでの施工を避け、重ね切りで施工してください。重ね切り施工時、カッターが斜めに入るとカット断面が目立ちやすくなるた め、必ず垂直に入れていただき、また、下地を切らないようにご注意ください。特に濃色の商品については、目立ちやすくなるためご注意ください。

RE55720 NEW 杉板目
準不燃
防火種別2-3 AA 1,090円/㎡
巾92cm ↕125cm ↕ 92cm
防かび

巾なり92cm
RE55720
▶ 施工注意 商品特性上、ベース原反に着色をしていないため、施工環境、条件、品番によってジョイント部分が白いライン状に目立ちます。また断面がより目立ち やすくなるため、突き付けでの施工を避け、重ね切りで施工してください。重ね切り施工時、カッターが斜めに入るとカット断面が目立ちやすくなるた め、必ず垂直に入れていただき、また、下地を切らないようにご注意ください。特に濃色の商品については、目立ちやすくなるためご注意ください。


RE55718 NEW リフォームおすすめ RE55717・55714・55046
RE55719・55714
リフォームおすすめ イメージ写真を 全点見る 160
RE55720・55713
準不燃
和 和
捨てるはずの素材を粉砕して壁紙の表面材として再利用。
裏紙にもリサイクル材を使用した、環境に配慮した壁紙です。


は 脱炭素社会の実現に向けたCO2 削減に貢献します
36
CO 2 削減率
リサイクル材を使用することで、 ライフサイクルにおける CO2 排出量を削減します。

壁紙:RE55726・55721・55229 床材:WD-2017(2023-2026 FLOOR TILE)
壁紙:RE55727・55229 床材:WD-2023(2023-2026 FLOOR TILE)
「MEGUReWALL」の 特設サイトはこちら。
76 %
再生材比率
商品における再生材比率を 表示しています。
※ CO2 削減率はメグリウォールの代表品番と一般的なビニル壁紙を比較算定した数値を表示しています。
※ 再生材比率は商品仕様に基づき算定した理論値となります。
※ 上記数値は算定値であり、保証値ではありません。
【施工ならびにお取り扱い上の注意】
一般ビニル壁紙とは素材が異なりますので施工やメンテナンスの際には注意が必要です。
製法上、粒子が欠落するおそれがありますのでお含みおきください。
天然素材のため、ジョイント部分で色差が生じる場合があります。
表面がややキズつきやすいため、施工やメンテナンスの際は慎重にお取り扱いください。 汚れがつきやすいため、お取り扱いにはご注意ください。
素材の特性により経年変化で部分的な変色などが起こる場合があります。
フクレやアクを防ぐため、シーラー処理をしてください。
シーラー処理をすることで下地の通気性を安定させ、壁紙表面の経年変化を軽減します。 オープンタイムは15分程度を目安として短めに取ってください。
糊付け後、長時間の養生は表面の粒子の欠落の原因となりますのでご注意ください。 糊付け後は折りジワがつかないように大きくたたみ、上積みは避けてください。
重ね裁ちをする場合は、常に鋭い刃先のカッターを使用し、下敷きテープを入れて施工してください。
表面素材が剥がれるおそれがありますので、糊付け後のお取り扱いにはご注意ください。 一般ビニル壁紙と比較して施工難易度が高いため、施工費が割増しになる場合があります。
選択・施工上の注意は こちら。

161 MEGURe WALL
KIRARI MADARA
捨てられるはずだった樹脂の端材をリサイクル。やさしい素材感と上質な輝き。心地よい抑揚のテクスチャーが魅力のデザイン。

RE55721

RE55724 NEW
準不燃
巾92cm
防火種別2-3 AA 1,090円/㎡
材料区分:その他(骨材)
防かび
▶ 施工注意
※P.161の施工ならびにお取り扱い上の注意をご参照ください。

RE55722 NEW

RE55725 NEW


RE55727 NEW

RE55726 NEW

RE55728 NEW
準不燃
巾92cm
防火種別2-3 AA 1,090円/㎡
材料区分:その他(骨材)
防かび
▶ 施工注意
RE55723
イメージ写真を 全点見る 162
CO 削減率 36 再生材比率 76 %
CO 削減率 36 再生材比率 76 % MEGURe WALL
EDAはイギリス人アーティストの感性と、日本人の 緻密で繊細なものづくりの技術が融合したサンゲ ツオリジナルブランドです。イギリスに拠点を構え るSanderson Design Groupの貴重なデザイ ンアーカイブをもとに、日本の空間に取り入れやす いデザインを厳選しています。
郊外の美しい自然あふれるハンプシャーをテーマ にした、コレクションの世界観をお楽しみください。
about

ハンプシャーはイングランド南部に位置する、イギリス屈 指の美しいガーデンを有する穏やかなエリア。街や海 岸、田園風景。雄大なハンプシャーの自然をモチーフに、 世界的に愛されている英国スタイルを表現したエレガント なコレクションです。
「EDA」の 特設サイトはこちら。

163

Jasminum ジャスミナム 伸びやかな流れが美しいジャスミンの壁紙。 シノワズリの雰囲気も感じさせる上品なデザインです。

RE55731 NEW

RE55732 NEW

RE55733 NEW
準不燃
防火種別2-3 AA 1,090円/㎡ 巾92cm ↕32.1cm ↕ 30.8cm 防かび ▶ 施工注意 濃色の商品は、ひっかきキズや糊の拭き残しにご注意ください。

RE55731(1目盛り10cm)
壁紙:RE55733・55229 床材:WD-2002(2023-2026 FLOOR TILE) イメージ写真を 全点見る 164
イメージ写真を
Fleur フルール ガーデンを彩る可愛らしい小花のトレリスは、 お部屋を明るく華やかに魅せてくれます。

RE55734 NEW

RE55735 NEW

RE55736 NEW
準不燃
防火種別2-3 AA 1,090円/㎡ 巾92cm ↕32.1cm ↕ 30.8cm 防かび
▶ 施工注意 濃色の商品は、ひっかきキズや糊の拭き残しにご注意ください。 入念な下地処理を行い、糊ダマリに注意して施工してください。

RE55734(1目盛り10cm)

壁紙:RE55736・55746・55229
床材:WD-2038-W(2023-2026 FLOOR TILE)
全点見る 165
Rosa ローザ イギリスの国花でもあるバラをペイントタッチで表現しました。 かすれたデザインがシャビーな空間にぴったり。

RE55737 NEW

RE55738 NEW

RE55739 NEW
準不燃
防火種別2-3 AA 1,090円/㎡ 巾92.5cm ↕32.1cm ↕ 46.3cm 防かび

RE55737(1目盛り10cm)

壁紙:RE55739・55745・55229 モールド:MM81・83 カーテン:AC2300 シェード:AC2167(2023-2026 AC) 床材:WD-2022(2023-2026 FLOOR TILE)
イメージ写真を 全点見る 166
NEW FERNDOWN ニュー フェーンダウン ニューフォレスト国立公園に由来して名付けられたフェーンダウン。
新緑にあふれた自然の豊かさを感じさせてくれます。

RE55740 NEW

RE55741 NEW
防火種別2-3 AA 1,090円/㎡ 巾92cm ↕64.1cm ↕ 46.2cm 防かび

RE55741(1目盛り10cm)

イメージ写真を 全点見る 167
RE55740
準不燃
WHITCHURCH ウィットチャーチ キバナクリンザクラ、セイヨウツナユキソウ、ノコギリソウにワスレナグサ など、イギリスの森にある草花をあしらった可愛らしいデザイン。

RE55742

RE55743
準不燃
防火種別2-3 AA 1,090円/㎡
巾92cm ↕64.1cm ↕ 46.2cm 防かび
▶ 施工注意 柄の特性上、表面がややキズつきやすいため、施工やメ ンテナンスの際は慎重にお取り扱いください。商品特 性上、ジョイント部分で色差が生じる場合があります。

RE55742(1目盛り10cm)

NEW LANGLEY ニュー ラングリー アールデコ調とコンテンポラリーが融合したトレリス柄は、モダンなインテリアをより洗練されたものに仕上げてくれます。

RE55744 NEW
準不燃
防火種別2-3 AA 1,090円/㎡
巾92.5cm ↕21.3cm ↕ 18.5cm 防かび

RE55744(1目盛り10cm)

AC)
AC) イメージ写真を 全点見る 168
壁紙:RE55743 シェード:AC2173・2025(2023-2026
壁紙:RE55744 カーテン:AC2176(2023-2026
NEW HURSTBOURNE ニュー ハーストボーン 質感のある壁紙は、インテリアスタイルに関わらず、エレガントな美しさを演出。 飽きのこない洗練されたデザインです。

RE55745 NEW

RE55746 NEW

RE55747 NEW
防火種別2-3 AA 1,090円/㎡ 巾92cm

RE55748 NEW

RE55749 NEW

RE55750 NEW

壁紙:RE55750・55229
床材:WD-2049(2023-2026 FLOOR TILE)
イメージ写真を 全点見る 169
吸放湿 撥水 準不燃
防かび 抗菌 表面強化

壁紙:RE55756・55229
カーテン:AC2565(2023-2026 AC)
床材:WD-2002(2023-2026 FLOOR TILE)
NEW STOUR ニュー スタウ マットな質感ときめ細かい肌触りにこだわった壁紙。 美しく絶妙なニュアンスカラーが、生活をやさしく彩ります。

RE55751 NEW

RE55752 NEW

RE55753 NEW

RE55754 NEW
準不燃
防火種別2-3 AA 1,090円/㎡ 巾92cm 防かび 抗菌 表面強化
▶ 施工注意

RE55755 NEW

RE55756 NEW

RE55757 NEW

RE55758 NEW
間接照明の場合など使用環境によって下地が目立つ商品です。 入念な下地処理を行い、糊ダマリに注意して施工してください。 糊付け後は大きくたたみ、折りジワに注意して、上積みは避けてください。 下地に配慮した施工を行うため、施工費が割増しになる場合があります。

RE55759 NEW

RE55760 NEW

RE55761 NEW

RE55762 NEW
イメージ写真を 全点見る 170
吸放湿 撥水
FINLAYSON(フィンレイソン)は、 1820年に創業された、北欧フィンランド の最古のテキスタイルブランドです。 1820年、タンペレ(フィンランド)に設 立した紡績工場の敷地内には、学校や図 書館、教会などの各施設が作られ、フィン ランド最大の工業都市として発展を遂げま した。1951年にはフィンランドで最も早 く自社内にデザインアトリエを設立。 1950年代(CORONNA)、1960年代 (TAIMI, ELEFANTTI)に生まれた、何 十年もの間親しまれている人気のクラシッ ク柄と、そのシーズンのトレンドカラーや モチーフをとらえた魅力的な新柄による豊 富なバリエーションは国内外で広く親しま れています。

ニッティポルクとは「草原の小道」と いう意味。フィンランドの夏とミッ ドサマーのお祭りがテーマになって いる。ノラニンジン、クローバー、シ ダそして忘れな草が咲き乱れる様子 が描かれ、ミッドサマーの不思議な 力を感じさせる。アヌ・カネルボによ るデザイン。

NIITTYPOLKU
Anu Kanervo
「Finlayson」の 特設サイトはこちら。


準不燃
防火種別2-3 AA 1,090円/㎡ 巾92.5cm ↕32.1cm ↕ 46.3cm 防かび

フィンレイソンの壁紙は海外での販売はできません。国内のみのライセンス契約です。 また、壁紙用途以外での使用や、ブランド名による営利目的での使用はできません。 Finlayson™ © Finlayson Oy

RE55772(1目盛り10cm)
リフォームおすすめ
RE55771 NEW
リフォームおすすめ
RE55772 NEW
ニッティポルク
リフォームおすすめ イメージ写真を 全点見る 171
壁紙:RE55771 床材:WD-2075(2023-2026 FLOOR TILE)
TAIMI
Aini Vaari

タイミとは「小さな植物」という意味。
伝統的な花々が咲き乱れる夕暮れ。種 まきをしていると、どこかしら悲しげ なスラブの歌が聞こえる。フィンレイ ソンのクラシックデザインのひとつ であるこのパターンは、愛らしく、昔 の懐かしい記憶を呼び起こす。1961 年、アイニ・ヴァーリによるデザイン。


RE55773

RE55774 NEW
準不燃
防火種別2-3 AA 1,090円/㎡ 巾92.5cm ↕30.7cm ↕ 46.3cm 防かび

RE55773(1目盛り10cm)
フィンレイソンの壁紙は海外での販売はできません。国内のみのライセンス契約です。 また、壁紙用途以外での使用や、ブランド名による営利目的での使用はできません。 Finlayson™ © Finlayson Oy
タイミ
壁紙:RE55774 床材:WD-2013(2023-2026 FLOOR TILE) イメージ写真を 全点見る 172
フィンレイソン| Finlayson
イメージ写真を 全点見る
リフォームおすすめ
心をくすぐられ思わず引き込まれる ような、魅惑の森。おとぎ話のような 森の中はちょっとワクワクするけれ ど、全然怖くはない。2016年、カロ リーナ・エルキンユッティによるデザ イン。

SADUSSA
Karoliina Erkinjuntti

RE55775 NEW リフォームおすすめ

RE55776 NEW リフォームおすすめ
防火種別2-3 AA 1,090円/㎡ 巾92.5cm ↕46cm ↕ 46.3cm 防かび 準不燃

RE55775(1目盛り10cm)
フィンレイソンの壁紙は海外での販売はできません。国内のみのライセンス契約です。 また、壁紙用途以外での使用や、ブランド名による営利目的での使用はできません。 Finlayson™ © Finlayson Oy

サドゥッサ
壁紙:RE55775 床材:WD-2114(2023-2026 FLOOR TILE)
173
Finlayson
フィンレイソン|
ANNI
Osmi Koskinen



RE55777

RE55778 生き生きとして親しみの持てる花柄はフィ ンランドの女性の名前から名付けられた。 シンプルなシェイプと細かなディティール のないパターンは、素早くごくわずかな筆 のタッチで制作した。伝統的でもあり、 どこか懐かしいパターンは、継続して使 える新鮮な魅力を持っている。2018年 制作。オスミ・コスキネンによるデザイン。
準不燃
防火種別2-3 AA 1,090円/㎡ 巾92cm ↕64.2cm ↕ 92cm 防かび

RE55777(1目盛り10cm)
フィンレイソンの壁紙は海外での販売はできません。国内のみのライセンス契約です。 また、壁紙用途以外での使用や、ブランド名による営利目的での使用はできません。 Finlayson™ © Finlayson Oy
アンニ
壁紙:RE55778 床材:WD-2128(2023-2026 FLOOR TILE) イメージ写真を 全点見る 174
Finlayson
フィンレイソン|
イメージ写真を
オンップとは「リンゴ」の愛称。世界最 古の果物であるリンゴは、時を超えて 愛される象徴的なアイテム。2015年 にデザイナー、アイニ・ヴァーリ監修の もとリニューアルされた。オリジナルと はリンゴの並び方を変え、よく見ると 虫の姿やリンゴをかじった跡が描かれ ている。


RE55779 NEW

RE55780 NEW
準不燃
防火種別2-3 AA 1,090円/㎡ 巾92cm ↕64.1cm ↕ 92cm 防かび

RE55780 巾なり92cm
フィンレイソンの壁紙は海外での販売はできません。国内のみのライセンス契約です。 また、壁紙用途以外での使用や、ブランド名による営利目的での使用はできません。 Finlayson™ © Finlayson Oy
Aini Vaari

RE55779・55597
オンップ
OMPPU
175
全点見る
フィンレイソン| Finlayson
ELEFANTTI
Laina Koskela



RE55781

RE55781(1目盛り10cm)
エレファンティ リエム
ELEFANTTI RIEMU
Laina Koskela & Finlayson
防火種別2-3 AA 1,090円/㎡ 巾92.5cm ↕21.3cm ↕ 92.5cm 防かび ▶ 施工注意 柄の特性上、表面がややキズつきやすいため、施工やメンテナンスの際 は慎重にお取り扱いください。
子どものころ、近所の友だちの家に遊びに行っ た日の思い出。かわいいゾウのカーテンがか かっていて、子ども部屋は宝ものであふれてい た。ベッドから椅子へジャンプしても誰からもし かられなかった。1969年フィンレイソンと芸術 デザイン大学が共演したデザインコンペでライ ナ・コスケラが発表したデザイン。


RE55782 NEW
準不燃
準不燃 防火種別2-3 AA 1,090円/㎡ 巾92cm ↕64.2cm ↕ 46.2cm 防かび
1969年以来、多くの人に愛される「エレファンティ」。一列に並んで行進し ていたゾウたちが、自由を謳歌する時が来た。
2023年に続き、2024年春夏コレクションでもライナ・コスケラとフィンレ イソンが共同でデザインした新たなエレファンティが誕生。RIEMUはフィン ランド語で「喜び」という意味で、自由に自分らしく生きるゾウたちの喜びを 表現している。

RE55782(1目盛り10cm)
フィンレイソンの壁紙は海外での販売はできません。国内のみのライセンス契約です。 また、壁紙用途以外での使用や、ブランド名による営利目的での使用はできません。 Finlayson™ © Finlayson Oy RE55781
エレファンティ
RE55782 イメージ写真を 全点見る 176
Finlayson
フィンレイソン|
CORONNA コロナ
Aini Vaari

1950年代の典型的なパターン。幾何 学的でシンプル、そして現実的なクラ シックデザイン。「毎日の生活に美を」と いう当時のキャッチフレーズを象徴的 にあらわしたスタイリッシュでタイムレ スなパターン。1958年、アイニ・ヴァー リによるデザイン。


RE55783

RE55784

RE55785
準不燃
防火種別2-3 AA 1,090円/㎡ 巾92cm ↕32cm ↕ 30.8cm
防かび
※製法やデザインの特性により、ジョイント部分を正確に合わせることが困難です。

RE55784(1目盛り10cm)
フィンレイソンの壁紙は海外での販売はできません。国内のみのライセンス契約です。 また、壁紙用途以外での使用や、ブランド名による営利目的での使用はできません。 Finlayson™ © Finlayson Oy
全点見る 177
RE55785 イメージ写真を
PAMPULA


RE55786

RE55787

RE55788
準不燃
防火種別2-3 AA 1,090円/㎡ 巾92.5cm ↕32cm ↕ 46.4cm 防かび

RE55786(1目盛り10cm)
 Sami Vulli
Sami Vulli
縦に連なる不揃いの毛糸玉が、流れる ように美しいリズムを表現。フィンラン ドデザイン黄金時代のノスタルジックな デザインをモダンで斬新にアレンジ。 サミ・ヴッリによるデザイン。 フィンレイソンの壁紙は海外での販売はできません。国内のみのライセンス契約です。 また、壁紙用途以外での使用や、ブランド名による営利目的での使用はできません。 Finlayson™ © Finlayson Oy
パンプーラ
イメージ写真を 全点見る 178
RE55788
kippis(キッピス)は、北欧デザインのラ イフスタイルブランド。北欧在住のデザイ ナーが描いた温かみのあるモチーフや、 洗練されたカラーづかいが魅力のさまざ まなテキスタイルデザインをお届けしま す。そんなkippisのデザインから、日々の 暮らしにあたたかなひと時を与えてくれる 可愛らしいパターンを壁紙にしてご提案し ます。
「kippis」の 特設サイトはこちら。

壁紙:RE55801 床材:WD-2013(2023-2026 FLOOR TILE) 179


RE55801 NEW

RE55802 NEW
準不燃
防火種別2-3 AA 1,090円/㎡ 巾92cm ↕46cm ↕ 30.8cm

RE55803 NEW

RE55804 NEW
準不燃
防火種別2-3 AA 1,090円/㎡ 巾92.5cm ↕64.1cm ↕ 30.9cm 防かび
Pupu [プープ]
長い耳と、もふもふとした丸みのある 体。フィンランドでは、親しみをもって プープと呼ばれています。単純化した シルエットで表したうさぎを均等に並 べたシンプルな構成は、キッピスの動 物柄の定番であり人気のデザイン。う さぎの涼しげな表情が均整のとれた デザインの魅力を盛り上げています。

RE55802(1目盛り10cm)
Jääkarhu [ヤーカルフ]
北欧の寒くて長い冬を象徴するモ チーフとしてのシロクマ。そのモフ モフとした愛らしいルックスには多 くの人の心を引き付けてやまない魅 力があります。凍てつくような寒い 冬があるからこそ発揮されるその存 在感は、そのまま北欧デザインの存在 価値を体現しているかのよう。kippis のロゴマークにも使われています。

RE55804(1目盛り10cm)
kippisの壁紙は海外での販売はできません。国内のみのライセンス契約です。 壁紙用途以外での使用や、ブランド名による営利目的での使用はできません。
RE55804 イメージ写真を 全点見る 180
防かび
キッピス| kippis
壁紙:RE55806・55181 カーテン:2024-2028 STRINGS
床材:WD-2031-W(2023-2026 FLOOR TILE)

Var pu [ヴァルプ]

RE55805 NEW

準不燃
防火種別2-3 AA 1,090円/㎡
巾92.5cm ↕64.1cm ↕ 46.3cm
防かび 抗菌 表面強化 吸放湿 撥水

RE55805(1目盛り10cm)
kippis Designer フィンランドを象徴する深い森の風景からインスパイアされた小 枝の柄です。フィンランドの暮らしに、森は欠かせない要素。森への お散歩は多くの人にとって日々の習慣です。デザイナーもそんな フィンランドの一人。森の地面は、いつも小さな小枝がいっぱいで す。深い茂みの中から枝に実ったブルーベリーやコケモモをかご いっぱいに摘みながら散歩する。季節ごとの移り変わりを楽しむ。 そんなデザイナーの日常をガッシュで描いたデザインです。
RE55806 NEW ハンネレ・アイヤラ Hannele Äijälä
kippisの壁紙は海外での販売はできません。国内のみのライセンス契約です。 壁紙用途以外での使用や、ブランド名による営利目的での使用はできません。
全点見る 181
イメージ写真を
ウレタンコート
ウレタンコート
Tip pa [ティッパ]

RE55807 NEW

RE55808 NEW
準不燃
防火種別2-3 AA 1,090円/㎡ 巾92cm ↕32cm ↕ 30.8cm 防かび 抗菌 表面強化 抗ウイルス ウレタンコ ト 吸放湿 撥水

RE55807(1目盛り10cm)
フィンランド語で雫という意味。雨は恵みの雨。雨が降ると、森の ベリーや苔がいきいきとし、キノコがすくすくと育ちます。雫が 滴る様子から楽しくポップなデザインが生まれました。シンプル な構成だからこそ、手描きのあたたかみがポイントです。
kippis Designer
エリ・シマツカ Eri Shimatsuka
kippisの壁紙は海外での販売はできません。国内のみのライセンス契約です。 壁紙用途以外での使用や、ブランド名による営利目的での使用はできません。 壁紙:RE55808 床材:WD-2023(2023-2026 FLOOR TILE)

イメージ写真を 全点見る 182
ウレタンコート
イメージ写真を 全点見る
ウレタンコート
Salmiakki [サルミアッキ]

RE55809 NEW

RE55810 NEW
防火種別2-3 AA 1,090円/㎡ 巾92cm ↕64cm ↕ 92cm 防かび 抗菌 表面強化 抗ウイルス ウレタンコ ト 吸放湿 撥水

巾なり92cm RE55809
フィンランド人が大好きなサルミアッキと呼ばれる黒いお菓子 がモチーフ。鼻がつんとする刺激的な味わいのお菓子ですが、子 どもも口を真っ黒に染めながら食べるほどみんな大好き。一度食 べるとクセになる、そんなフィンランド定番のお菓子がストライ プになりました。
kippis Designer
エリ・シマツカ Eri Shimatsuka
kippisの壁紙は海外での販売はできません。国内のみのライセンス契約です。 壁紙用途以外での使用や、ブランド名による営利目的での使用はできません。 壁紙:RE55810 床材:WD-2075(2023-2026 FLOOR TILE)

183
キッピス|
準不燃
kippis

Villik ukka [ヴィリクッカ]

RE55811 NEW

準不燃
防火種別2-3 AA 1,090円/㎡ 巾92.5cm ↕32cm ↕ 46.3cm 防かび

巾なり92.5cm
kippisの壁紙は海外での販売はできません。国内のみのライセンス契約です。 壁紙用途以外での使用や、ブランド名による営利目的での使用はできません。 壁紙:RE55811・55181
イメージ写真を 全点見る
kippis Designer
RE55812 NEW エリ・シマツカ Eri Shimatsuka
RE55812
自然と人々の暮らしが密接な距離にある北欧。日々野原や森に出 かけては、イラクサを摘んでスープにしたり、森で摘んだ花を夏小 屋に飾ったり、という暮らしの一部分を切り取ったデザインです。 陽の光を浴びて、元気いっぱい咲く野生の花々に、デザイナーが 自然の恵みを感じながら作ったというこの柄。不規則に、緻密に 並ぶ花々の集積が圧倒的な力を持つデザインです。
シェード:AC2028(2023-2026 AC) 床材:WD-2023(2023-2026 FLOOR TILE)
184
キッピス| kippis
壁紙:RE55821・55255・55181 カーテン:AC2561(2023-2026 AC) 床材:WD-2031-W(2023-2026 FLOOR TILE)


RE55821 NEW

RE55822 NEW
準不燃
防火種別2-3 AA 1,090円/㎡ 巾92cm ↕32.1cm ↕ 46.2cm 防かび 抗菌

RE55822(1目盛り10cm)
優しいカラーのリーフ柄は、広い空間にもよくなじみます。
全点見る 185
イメージ写真を
パターン

準不燃

RE55823(1目盛り10cm)
防火種別2-3 AA 1,090円/㎡
巾92cm ↕64.1cm ↕ 92cm 防かび 抗菌
吸放湿 撥水
底光りするパールとカラーグラデーションが美しい、 エレガントなフラワー柄です。

RE55823 NEW RE55824 NEW
準不燃
防火種別2-3 AA 1,090円/㎡ 巾92cm ↕30.6cm ↕ 30.8cm 防かび 抗菌
カーテンで人気のデザインを壁紙に仕立てました。 水彩タッチの鳥と草花が可愛らしいデザイン。

壁紙:RE55823・55048・モールド:MM82 床材:WD-2022(2023-2026 FLOOR TILE)

RE55824(1目盛り10cm)

イメージ写真を 全点見る 186
RE55824・55028
パターン
ウレタンコート

RE55825 NEW

RE55826 NEW
準不燃
防火種別2-3 AA 1,090円/㎡ 巾92.5cm ↕32cm ↕ 46.4cm
防かび 抗菌 表面強化
吸放湿 撥水

RE55827
ウレタンコート
リフォームおすすめ

RE55828
準不燃
防火種別2-3 AA 1,090円/㎡ 巾92cm ↕64cm ↕ 92cm
防かび 抗菌 表面強化
抗ウイルス ウレタンコ ト 吸放湿 撥水
▶ 施工注意 濃色の商品は、ひっかきキズや糊の拭き残しにご注意ください。
リフォームおすすめ
線描のリーフ柄は、クラシック な空間を演出します。

RE55826(1目盛り10cm)

RE55827(1目盛り10cm)
エスニックなリーフ柄の中に は、可愛い鳥が隠れています。

壁紙:RE55828・55229 ウッドブラインド:WB107(2022 RB COLLECTION vol.1) 床材:WD-2061(2023-2026 FLOOR TILE)

RE55825・55462
イメージ写真を 全点見る 187
リフォームおすすめ
パターン
壁紙:RE55830・55119・55229
カーテン:AC2296(2023-2026 AC)
床材:WD-2058(2023-2026 FLOOR TILE)

壁紙:RE55832・55229
カーテン:AC2025(2023-2026 AC)


RE55829 NEW

RE55830 NEW
準不燃
防火種別2-3 AA 1,090円/㎡
巾92.5cm ↕64.1cm ↕ 92.5cm
防かび 抗菌

RE55831 NEW リフォームおすすめ

RE55832 NEW
準不燃
防火種別2-3 AA 1,090円/㎡
巾92.5cm ↕64.2cm ↕ 92.5cm
防かび 抗菌
▶ 施工注意
濃色の商品は、ひっかきキズや糊の拭き残しにご注意ください。

巾なり92.5cm
RE55829
近年トレンドのトライバル柄を、使いやすく落ち 着いたカラーの壁紙に仕上げました。
リフォームおすすめ

RE55831(1目盛り10cm)
高級感のあるパームツリー柄です。 ボヘミアンスタイルにおすすめ。
リフォームおすすめ
イメージ写真を 全点見る 188
パターン パターン

RE55833 リフォームおすすめ ロングセラ

RE55834 リフォームおすすめ ロングセラ
準不燃
防火種別2-3 AA 1,090円/㎡
巾92cm ↕21.4cm ↕ 23cm
防かび

RE55834(1目盛り10cm)



RE55836 NEW
準不燃
防火種別2-3 AA 1,080円/㎡
ウレタンコ ト
巾93cm ↕32cm ↕ 18.6cm
防かび 吸放湿
※親水性高分子ポリマーが空気中や接着剤の水分を吸収し、白い粉末状となって撫で刷 毛等に付着することがありますが、品質や性能には問題ございません。

 RE55835(1目盛り10cm)
RE55835(1目盛り10cm)
吸放湿
RE55835
吸放湿
RE55835
ロングセラー リフォームおすすめ イメージ写真を 全点見る 189
RE55834
パターン


準不燃
防火種別2-3 AA 1,090円/㎡
ウレタンコ ト
巾92cm ↕23cm ↕ 46.2cm 防かび 吸放湿
※親水性高分子ポリマーが空気中や接着剤の水分を吸収し、白い粉末状となって撫で刷 毛等に付着することがありますが、品質や性能には問題ございません。

吸放湿

吸放湿 RE55838・55420

準不燃
防火種別2-3 AA 1,090円/㎡
ウレタンコ ト
巾92.5cm ↕32cm ↕ 46.3cm 防かび 吸放湿

壁紙:RE55839・55537
床材:WD-2032-W(2023-2026 FLOOR TILE)

NEW
※親水性高分子ポリマーが空気中や接着剤の水分を吸収し、白い粉末状となって撫で刷毛等に付着することがありますが、品質や性能には問題ございません。

RE55839(1目盛り10cm) RE55837(1目盛り10cm) RE55837
ロングセラ
RE55838
吸放湿
RE55839
RE55837 ロングセラー イメージ写真を 全点見る 190
パターン

RE55841・55181


RE55840 NEW

RE55841 NEW
準不燃
防火種別2-3 AA 1,090円/㎡
巾92.5cm ↕64.1cm ↕ 92.5cm
防かび

RE55842 NEW

RE55840(1目盛り10cm)
光の当たり方でパールの見 え方が変わる、可愛らしい 北欧テイストの鳥柄です。
リフォームおすすめ
リフォームおすすめ

RE55843
準不燃
防火種別2-3 AA 1,090円/㎡
巾92cm ↕64cm ↕ 30.7cm
防かび
リフォームおすすめ

RE55842(1目盛り10cm)
ナチュラルな幾何パターン 柄は、広い面積にもお使い いただけます。
RE55843
イメージ写真を 全点見る 191
ウレタンコート

RE55844 NEW リフォームおすすめ

巾なり92cm RE55844
壁紙:RE55845・55181 シェード:AC2046(2023-2026 AC) 床材:WD-2031-W(2023-2026 FLOOR TILE)
ウレタンコート

RE55845 NEW リフォームおすすめ
準不燃
防火種別2-3 AA 1,090円/㎡ 巾92cm ↕64cm ↕ 92cm 防かび 抗菌 表面強化 抗ウイルス ウレタンコ ト 吸放湿 撥水
ルームエアー(消臭)

RE55846 NEW
ルームエアー(消臭)

RE55847 NEW
準不燃
防火種別2-3 AA 1,090円/㎡ 巾92.5cm ↕46.1cm ↕ 30.9cm 防かび 抗菌 消臭
AC2046のシェードと同柄のデザイン。
北欧らしい手描きのタッチをぷっくりと 表現しました。


RE55846(1目盛り10cm)
ニュアンスカラーとナチュラルな質感 が大人っぽいストライプ。
壁紙:RE55847・55050 床材:WD-2013(2023-2026 FLOOR TILE)

リフォームおすすめ イメージ写真を 全点見る 192
パターン

RE55848
準不燃
防火種別2-3 AA 1,090円/㎡ 巾92.5cm ↕50cm ↕ 46.4cm 防かび

RE55848(1目盛り10cm)

RE55849 NEW

RE55850 NEW
準不燃
防火種別2-3 AA 1,080円/㎡ 巾93cm ↕64cm ↕ 9.3cm 防かび 抗菌

RE55849(1目盛り10cm)

RE55848・55050
パールが光るチェック柄。可愛らしい 空間にも、トラディショナルな空間に もおすすめです。

イメージ写真を 全点見る 193
壁紙:RE55850・55754・モールド:MM87 カーテン:AC2560(2023-2026 AC) 床材:WD-2049(2023-2026 FLOOR TILE)
パターン

RE55852・55851


RE55851 ロングセラ
準不燃
防火種別2-3 AA 1,090円/㎡
巾92cm ↕23cm ↕ 30.7cm エンボスリピート
防かび

RE55852

RE55853
準不燃
防火種別2-3 AA 1,090円/㎡
巾92.5cm ↕32cm ↕ 46.3cm
防かび
▶ 施工注意
濃色の商品は、ひっかきキズや糊の拭き残しにご注意ください。

RE55851(1目盛り10cm)

RE55852(1目盛り10cm)
RE55851
ロングセラー イメージ写真を 全点見る 194
パターン パターン



準不燃
防火種別2-3 AA 1,090円/㎡
巾92.5cm ↕21.3cm ↕ 30.9cm
防かび
▶ 施工注意
エンボスリピートは合いません。
間接照明の場合など使用環境によって下地が目立つ商品です。 入念な下地処理を行い、糊ダマリに注意して施工してください。

RE55855

準不燃
防火種別2-3 AA 1,090円/㎡
巾92.5cm ↕16cm ↕ 15.4cm
防かび

RE55854(1目盛り10cm)

RE55855(1目盛り10cm)
RE55854
RE55856
RE55854
イメージ写真を 全点見る 195
RE55855
ルームエアー(消臭)

RE55857 NEW リフォームおすすめ
準不燃
防火種別2-3 AA 1,090円/㎡ 巾92.5cm ↕64cm ↕ 92.5cm ● ステップ柄合せ 防かび 抗菌

巾なり92.5cm
RE55857
厚みがあり施工性の良い空柄の壁紙。 壁にも天井にもご使用いただけます。

RE55858
準不燃
防火種別2-3 AA 1,090円/㎡
巾92.5cm ↕63.8cm ↕ 92.5cm エンボスリピート ● ステップ柄合せ 防かび 抗菌 消臭 ※RE55858・55859はコーディネートしてお使いいただける商品ですが、直接継ぎ合わ せて施工した場合、色違いが生じます。
変則リピートの商品です。要尺計算ならびに柄合わせの際は十分にご注意ください。

準不燃
防火種別2-3 AA 1,090円/㎡ 巾92.5cm 防かび 抗菌 消臭
壁紙:RE55857・55027・55229
ロールスクリーン:RS136(2022 RB COLLECTION vol.1)
床材:WD-2038-W(2023-2026 FLOOR TILE)


柄アップ

RE55858施工図
巾なり92.5cm

RE55858 巾なり92.5cm 20.8cm
※実際はエンボスの凹凸のみの商品です。

一巾(92.5cm)ごとに左側が20.8cm高くなっています。
一巾につき20.8cmを要尺に加えて計算してください。

 RE55859
RE55859
ルームエアー(消臭)
RE55858 リフォームおすすめ イメージ写真を 全点見る 196
パターン

RE55860 NEW

RE55861 NEW
準不燃
防火種別2-3 AA 1,090円/㎡
巾92.5cm ↕10.7cm ↕ 10.3cm
防かび

RE55860(1目盛り10cm)
シンプルな構成とさり気ないパール感 が使いやすい壁紙。北欧モダンな空 間におすすめです。
▶ 施工注意 柄の特性上、表面がややキズつきやすいため、施工やメンテナンスの際は慎重にお取り扱いください。 製法やデザインの特性により、ジョイント部分を正確に合わせることが困難です。

RE55862

RE55863
準不燃
防火種別2-3 AA 1,090円/㎡
巾92cm ↕32cm ↕ 30.8cm
防かび

RE55862(1目盛り10cm)

 RE55861
RE55861
イメージ写真を 全点見る 197
RE55863
パターン
RE55865

RE55866


RE55864

RE55865
防火種別2-3 AA 1,090円/㎡
巾92cm ↕64.2cm ↕ 92cm 防かび

RE55866

RE55867
準不燃
防火種別2-3 AA 1,090円/㎡
巾92cm ↕64cm ↕ 92cm
防かび 抗菌

巾なり92cm
RE55864

RE55867(1目盛り10cm)
ウレタンコート
ウレタンコート
イメージ写真を 全点見る 198
準不燃
表面強化 抗ウイルス ウレタンコ ト 吸放湿 撥水
パターン パターン

壁紙:RE55868・55629
床材:WD-2074(2023-2026 FLOOR TILE)


RE55868 NEW リフォームおすすめ
準不燃
防火種別2-3 AA 1,090円/㎡
巾92.5cm ↕64cm ↕ 92.5cm
防かび
繊細なテクスチャーを立体的なプリントとラメで 表現したモダンな商品です。

RE55869 リフォームおすすめ

RE55870 リフォームおすすめ
準不燃
防火種別2-3 AA 1,090円/㎡
巾92.5cm ↕92cm ↕ 92.5cm エンボスリピート
防かび 抗菌
▶ 施工注意
見る角度や環境によってジョイント部分が目立つ商品です。

巾なり92.5cm RE55868

巾なり92.5cm RE55870
RE55870 リフォームおすすめ イメージ写真を 全点見る 199
壁紙:RE55871
カーテン:AC2566(2023-2026 AC)
床材:WD-2037-W(2023-2026 FLOOR TILE)

RE55871 リフォームおすすめ
準不燃
防火種別2-3 AA 1,090円/㎡
巾92cm ↕64.2cm ↕ 92cm
防かび

RE55872 NEW リフォームおすすめ

RE55873 NEW リフォームおすすめ
準不燃
防火種別2-3 AA 1,090円/㎡
巾92.5cm ↕64.1cm ↕ 46.3cm
防かび

RE55871(1目盛り10cm)

RE55872(1目盛り10cm)
和モダンな空間によく合うリーフ柄。 パールが高級感を演出します。


壁紙:RE55873・55074
床材:WD-2074(2023-2026 FLOOR TILE)
イメージ写真を 全点見る 200
リフォームおすすめ
パターン


巾なり92cm RE55874

準不燃
防火種別2-3 AA 1,090円/㎡
巾92cm ↕63.8cm ↕ 92cm
防かび
▶ 施工注意 柄の特性上、表面がややキズつきやすいため、施工やメンテナンスの際 は慎重にお取り扱いください。



準不燃
防火種別2-3 AA 1,090円/㎡ MADE IN CHINA
巾92cm ↕52.4cm ↕ 92cm エンボスリピート
▶ 施工注意
濃色の商品は、ひっかきキズや糊の拭き残しにご注意ください。
製法や柄の特性上、柄が正確に合いません。
また、ジョイント部分で色差が生じる場合があります。

巾なり92cm RE55877
 RE55874
RE55875
RE55876
RE55877
RE55875・55859
RE55874
RE55875
RE55876
RE55877
RE55875・55859
イメージ写真を 全点見る 201
RE55877
パターン

壁紙:RE55879・55045 スマートジョイナー:SRJ-216


RE55878 NEW

RE55879 NEW
準不燃
巾92cm
防かび
防火種別2-3 AA 1,090円/㎡

RE55878(1目盛り10cm)
▶ 施工注意 柄の特性上、表面がややキズつきやすいため、施工やメンテナンスの際は慎重にお取り扱いください。 またこの商品は海外での販売はできません。国内での使用に限られますのでご注意ください。

RE55880 NEW

RE55881 NEW

巾なり92cm
RE55880
準不燃 シックカラーのランダムストライプ柄は、 繊細なテクスチャーが魅力です。
防火種別2-3 AA 1,090円/㎡
巾92cm ↕64.2cm ↕ 92cm
防かび
▶ 施工注意
間接照明の場合など使用環境によって下地が目立つ商品です。 入念な下地処理を行い、糊ダマリに注意して施工してください。
床材:WD-2075(2023-2026
TILE) イメージ写真を 全点見る 202
壁紙:RE55881・55181 カーテン:AC2285・2561(2023-2026 AC)
FLOOR
パターン パターン
RE55882

RE55884


RE55882

RE55883
準不燃
防火種別2-3 AA 1,090円/㎡
巾92cm ↕64.2cm ↕ 92cm
防かび
CRACK
Designed by MIKIYA KOBAYASHI

RE55883(1目盛り10cm)
▶ 施工注意 間接照明の場合など使用環境によって下地が目立つ場合があります。入念な下地処理を行い、糊ダマリに注意して施工して ください。またスジがつきやすいため、糊付け後は折り目がつかないように施工してください。

RE55884 NEW

RE55885 NEW
準不燃
防火種別2-3 AA 1,090円/㎡
巾92cm ↕32cm ↕ 46.1cm
防かび
SMALL CRACK
Designed by MIKIYA KOBAYASHI

RE55885(1目盛り10cm)
▶ 施工注意 間接照明の場合など使用環境によって下地が目立つ場合があります。入念な下地処理を行い、糊ダマリに注意して施工して ください。またスジがつきやすいため、糊付け後は折り目がつかないように施工してください。
全点見る 203
イメージ写真を

RE55886

RE55887
準不燃
防火種別2-3 AA 1,090円/㎡
巾92.5cm ↕64.2cm ↕ 92.5cm
防かび
▶ 施工注意 柄の特性上、表面がややキズつきやすいため、施工やメンテナンスの際 は慎重にお取り扱いください。

RE55888 ロングセラ

RE55889 ロングセラ
準不燃
防火種別2-3 AA 1,090円/㎡
巾92cm ↕2.4cm ↕ 1.4cm
防かび

RE55886(1目盛り10cm)


RE55888(1目盛り10cm)
 RE55887
RE55887
ロングセラー イメージ写真を 全点見る 204
RE55888・55889
パターン
RE55890 NEW ウレタンコート


RE55891 NEW
準不燃
防火種別2-3 AA 1,090円/㎡ 巾92cm ↕21.3cm ↕ 30.8cm
防かび 抗菌 表面強化
抗ウイルス ウレタンコ ト 吸放湿 撥水

RE55892 NEW

RE55893 NEW
準不燃
防火種別2-3 AA 1,090円/㎡ 巾92cm ↕32cm ↕ 23.1cm 防かび

RE55890(1目盛り10cm)
ベース使いにもおすすめできる、 クラシック調の格子柄です。 ゴールドのアクセントが美しい、 エレガントなクラシック柄です。

壁紙:RE55891 床材:WD-2039-W(2023-2026 FLOOR TILE)

RE55892(1目盛り10cm)

壁紙:RE55893・55128・55181 床材:WD-2039-W(2023-2026 FLOOR TILE)
ウレタンコート
イメージ写真を 全点見る 205
パターン
RE55895

フィルム汚れ防止 バリアタイプ

RE55894 NEW

RE55895
準不燃
防火種別2-3 AA 1,090円/㎡
巾92cm ↕16cm ↕ 15.4cm
防かび
▶ 施工注意 濃色の商品は、ひっかきキズや糊の拭き残しにご注意ください。

フィルム汚れ防止

RE55896 ロングセラ

RE55897
準不燃
防火種別2-3 AA 1,090円/㎡
巾92cm ↕23cm ↕ 23.1cm
防かび 抗菌 汚れ防止
▶ 施工注意
「フィルム汚れ防止壁紙 バリアタイプ」の施工上の注意につきましてはP.103をご参照ください。
一般ビニル壁紙と比較して施工難易度が高いため、施工費が割増しになる場合があります。

RE55895(1目盛り10cm)

RE55896(1目盛り10cm)
バリアタイプ
RE55896 ロングセラー イメージ写真を 全点見る 206
パターン
パターン



準不燃
防火種別2-3 AA 1,090円/㎡
巾92cm ↕21.4cm ↕ 13.2cm 防かび


準不燃
防火種別2-3 AA 1,080円/㎡
巾93cm ↕30.7cm ↕ 13.3cm 防かび



準不燃
防火種別2-3 AA 1,090円/㎡
巾92.5cm ↕64.1cm ↕ 92.5cm
防かび

RE55899(1目盛り10cm) RE55900(1目盛り10cm) RE55898(1目盛り10cm) RE55899 リフォームおすすめ ロングセラ RE55900 リフォームおすすめ RE55898 ロングセラ
RE55898
RE55899
ロングセラー リフォームおすすめ イメージ写真を 全点見る 207
RE55900


準不燃
防火種別2-3 AA 1,090円/㎡
巾92.5cm ↕64.1cm ↕ 92.5cm 防かび 抗菌



準不燃
防火種別2-3 AA 1,090円/㎡
巾92.5cm ↕64.1cm ↕ 92.5cm
防かび 抗菌


準不燃
防火種別2-3 AA 1,090円/㎡
巾92.5cm ↕64.1cm ↕ 92.5cm 防かび
▶ 施工注意 濃色の商品は、ひっかきキズや糊の拭き残しにご注意ください。

RE55901(1目盛り10cm) RE55902(1目盛り10cm) RE55903(1目盛り10cm)
リフォームおすすめ
リフォームおすすめ
RE55901
RE55902
RE55903
RE55901
リフォームおすすめ イメージ写真を 全点見る 208
RE55903
パターン





RE55904(1目盛り10cm)


RE55906(1目盛り10cm) RE55904 ロングセラ
準不燃
防火種別2-3 AA 1,090円/㎡
巾92cm ↕32cm ↕ 46cm 防かび

準不燃
防火種別2-3 AA 1,090円/㎡
巾92.5cm ↕21.4cm ↕ 18.5cm 防かび

RE55905(1目盛り10cm)

準不燃
防火種別2-3 AA 1,080円/㎡
巾93cm ↕32cm ↕ 31cm 防かび
RE55905
ロングセラ
RE55907
ロングセラ
RE55906
RE55904
RE55905
ロングセラー イメージ写真を 全点見る 209
RE55907


RE55908 ロングセラ
準不燃
防火種別2-3 AA 1,090円/㎡
巾92.5cm ↕8cm ↕ 5.8cm
防かび 表面強化
抗ウイルス ウレタンコ ト

RE55909 NEW
準不燃
防火種別2-3 AA 1,090円/㎡
巾92cm ↕64.1cm ↕ 46.2cm
防かび

壁紙:RE55909・55181 カーテン:AC2319・2571(2023-2026 AC)

RE55908(1目盛り10cm)



RE55909(1目盛り10cm)


準不燃
防火種別2-3 AA 1,090円/㎡
巾92cm ↕10.7cm ↕ 7.7cm 防かび
RE55911(1目盛り10cm)
ウレタンコート
RE55910
RE55911
RE55908
イメージ写真を 全点見る 210
RE55910 ロングセラー
パターン
リフォームおすすめ

RE55912 NEW リフォームおすすめ

RE55913 NEW リフォームおすすめ
準不燃
防火種別2-3 AA 1,090円/㎡
巾92cm ↕21.4cm ↕ 13.2cm 防かび

RE55914 NEW

RE55915 NEW
準不燃
防火種別2-3 AA 1,090円/㎡
巾92cm ↕64.1cm ↕ 92cm 防かび

RE55912(1目盛り10cm)
ベースにもアクセントにも使える、 王道のダマスク柄です。


RE55914(1目盛り10cm)
シンプルで使いやすい、 繊細なタッチの花柄です。
 RE55913・55296
RE55915
RE55913・55296
RE55915
イメージ写真を 全点見る 211
パターン



RE55916(1目盛り10cm)
金細工を思わせる繊細な表現 が魅力の花柄です。

RE55916 NEW

RE55917 NEW
準不燃
防火種別2-3 AA 1,090円/㎡ 巾92cm ↕32cm ↕ 23.1cm 防かび

RE55918(1目盛り10cm)
表面の装飾が繊細で美しい、 エレガントなタイル柄です。

RE55918

RE55919
準不燃
防火種別2-3 AA 1,090円/㎡ 巾92cm ↕32cm ↕ 46.2cm 防かび 抗菌 表面強化 抗ウイルス ウレタンコ ト 吸放湿 撥水
ウレタンコート
ウレタンコート
RE55918 イメージ写真を 全点見る 212
RE55917
パターン パターン



準不燃
防火種別2-3 AA 1,090円/㎡
巾92cm ↕32cm ↕ 30.8cm
防かび 抗菌 表面強化


準不燃
防火種別2-3 AA 1,090円/㎡
巾92cm ↕25cm ↕ 46.2cm エンボスリピート
防かび 抗菌
▶ 施工注意
入念な下地処理を行い、糊ダマリに注意して施工してください。



準不燃
防火種別2-3 AA 1,090円/㎡
巾92.5cm ↕32cm ↕ 46.4cm
防かび 抗菌 消臭

RE55922(1目盛り10cm) RE55921(1目盛り10cm) RE55920(1目盛り10cm)
RE55920
NEW
RE55921 NEW
RE55922 ロングセラ
ルームエアー(消臭)
RE55920
RE55921
ロングセラー イメージ写真を 全点見る 213
RE55922

壁紙:RE55923 モールド:MM87

RE55923
準不燃
防火種別2-3 AA 1,090円/㎡
巾92cm ↕34.4cm ↕ 46.2cm 防かび


壁紙:RE55924 床材:WD-2120(2023-2026 FLOOR TILE)

RE55924 NEW
準不燃
防火種別2-3 AA 1,090円/㎡
巾92.5cm ↕21.3cm ↕ 46.3cm 防かび 表面強化


壁紙:RE55925 床材:WD-2018(2023-2026 FLOOR TILE)

RE55925
準不燃
防火種別2-3 AA 1,090円/㎡
巾92.5cm ↕46cm ↕ 92.5cm 防かび 抗菌 吸放湿 撥水

RE55925(1目盛り10cm)
RE55924(1目盛り10cm) RE55923(1目盛り10cm)
イメージ写真を 全点見る 214
パターン

RE55926
リフォームおすすめ

RE55926(1目盛り10cm)

RE55928
準不燃
防火種別2-3 AA 1,090円/㎡
巾92cm ↕29cm ↕ 23cm エンボスリピート
防かび 抗菌 汚れ防止
▶ 施工注意

RE55927
準不燃
防火種別2-3 AA 1,090円/㎡
巾92.5cm ↕46cm ↕ 46.4cm
防かび 抗菌 汚れ防止
▶ 施工注意
リフォームおすすめ
リフォームおすすめ ロングセラ

RE55928(1目盛り10cm)

RE55929
準不燃
防火種別2-3 AA 1,090円/㎡
巾92cm ↕32.1cm ↕ 46cm
防かび 抗菌 汚れ防止
▶ 施工注意

RE55929(1目盛り10cm)
▶ 施工注意 「フィルム汚れ防止壁紙 バリアタイプ」の施工上の注意につきましてはP.103をご参照ください。 一般ビニル壁紙と比較して施工難易度が高いため、施工費が割増しになる場合があります。
RE55926・55419



フィルム汚れ防止 バリアタイプ
フィルム汚れ防止 バリアタイプ
フィルム汚れ防止 バリアタイプ
バリアタイプ
フィルム汚れ防止
RE55928
ロングセラー リフォームおすすめ イメージ写真を 全点見る 215
RE55929
パターン
フィルム汚れ防止
バランスタイプ

RE55930 NEW
フィルム汚れ防止
バランスタイプ

RE55931 NEW
準不燃
防火種別2-3 AA 1,090円/㎡
巾92.5cm ↕16cm ↕ 18.5cm
防かび 抗菌 汚れ防止
▶ 施工注意 「フィルム汚れ防止 バランスタイプ」の施工上の注意につきましては P.116をご参照ください。一般ビニル壁紙と比較して施工難易度が高い ため、施工費が割増しになる場合があります。

フィルム汚れ防止

バランスタイプ
RE55930(1目盛り10cm)

RE55932 NEW
準不燃
防火種別2-3 AA 1,090円/㎡
巾92cm ↕21.4cm ↕ 30.8cm
防かび 抗菌 汚れ防止
▶ 施工注意 「フィルム汚れ防止 バランスタイプ」の施工上の注意につきましては P.116をご参照ください。一般ビニル壁紙と比較して施工難易度が高い ため、施工費が割増しになる場合があります。

RE55932(1目盛り10cm)
フィルム汚れ防止

RE55933
準不燃
防火種別2-3 AA 1,090円/㎡
巾92cm ↕16.1cm ↕ 30.7cm
防かび 抗菌 汚れ防止

RE55933(1目盛り10cm)
リフォームおすすめ
▶ 施工注意 「フィルム汚れ防止壁紙 バリアタイプ」の施工上の注意につきましては P.103をご参照ください。一般ビニル壁紙と比較して施工難易度が高いた め、施工費が割増しになる場合があります。


リフォームおすすめ
バリアタイプ RE55931 RE55932 RE55933
イメージ写真を 全点見る 216
パターン パターン
フィルム汚れ防止

RE55934 NEW
準不燃
防火種別2-3 AA 1,090円/㎡
巾92.5cm ↕32.1cm ↕ 46.3cm 防かび 抗菌 汚れ防止
▶ 施工注意

RE55934(1目盛り10cm)
フィルム汚れ防止

RE55935 NEW
準不燃
防火種別2-3 AA 1,090円/㎡
巾92cm ↕21.3cm ↕ 23.1cm
防かび 抗菌 汚れ防止
▶ 施工注意

RE55935(1目盛り10cm)

RE55936 NEW
RE55934~RE55936はテキスタイルデザイナー 青山佳世さんの情緒あるデザインです。
▶ 施工注意 「フィルム汚れ防止 バランスタイプ」の施工上の注意につきましてはP.116をご参照ください。
一般ビニル壁紙と比較して施工難易度が高いため、施工費が割増しになる場合があります。


フィルム汚れ防止 バランスタイプ
リフォームおすすめ
バランスタイプ
リフォームおすすめ
バランスタイプ RE55936・55659 RE55934・55046 リフォームおすすめ イメージ写真を 全点見る 217
パターン
フィルム汚れ防止
バリアタイプ
フィルム汚れ防止 バリアタイプ



RE55937
準不燃
防火種別2-3 AA 1,090円/㎡
巾92cm ↕57.3cm ↕ 23.1cm
防かび 抗菌 表面強化 汚れ防止 ▶ 施工注意 「フィルム汚れ防止壁紙 バリアタイプ」の施工上の注意につきましては P.103をご参照ください。一般ビニル壁紙と比較して施工難易度が高い ため、施工費が割増しになる場合があります。

RE55937(1目盛り10cm)

RE55937・55421・55245
準不燃
防火種別2-3 AA 1,090円/㎡
巾92.5cm ↕64.1cm ↕ 92.5cm
防かび 抗菌 表面強化 汚れ防止
▶ 施工注意 「フィルム汚れ防止壁紙 バリアタイプ」の施工上の注意につきましては P.103をご参照ください。一般ビニル壁紙と比較して施工難易度が高い ため、施工費が割増しになる場合があります。

RE55938(1目盛り10cm)
RE55939 NEW
準不燃
防火種別2-3 AA 1,090円/㎡
巾92cm ↕32cm ↕ 46.2cm
防かび 抗菌 表面強化 ス パ 耐久性 汚れ防止
▶ 施工注意 「スーパー耐久性」の施工上の注意につきましてはP.109をご参照くださ い。一般ビニル壁紙と比較して施工難易度が高いため、施工費が割増し になる場合があります。

RE55939(1目盛り10cm)

 RE55938
RE55938
スーパー耐久性
RE55938
イメージ写真を 全点見る 218
RE55939・55094
パターン パターン

National Museum of Nature and Science,Tokyo SANGETSU, Special Project

Day and Night Science Museum Day and Night Science Museum 国立科学博物館

CHAPTER: DINOSAURS, BIRDS, PLANTS, MINERALS, ROCKS, WHALES AND DOLPHINS, BEASTS

好奇心をくすぐるニューウォールアートルーム
人が幸せになれる体験に価値がある。
あらためて人々が驚き、喜び、こころ踊らせる体験ができる壁紙を作りたい。 そんな熱い想いから実現したのがこの国立科学博物館とのコラボ壁紙です。

日常の中で多くの時間、近い距離にある壁紙を通して、まるで博物館にいるかのような迫力を味わえたら。
動物や植物についての知識に思いを巡らせたり、自然の神秘を肌で感じられたら。 ワクワクする気持ちをたくさん生活に散りばめて、もっと日々が豊かになるはず。
博物館に行きたくてもなかなか行けない…そんな人にも、この感動を伝えたい。
さあ、知的好奇心をくすぐるニューウォールアートの世界を!

RE55941~55947の売上金額の一部は、国立科学博物館の活動の資金となります。

恐竜の主なグループの代表選手をイラスト化したものが集結した壁紙。

大きな竜脚類から小さな羽毛恐竜まで、大好きな恐竜に囲まれた幸せ空間を!
国立科学博物館で展示されている種類を中心に、主要な系統の代表的な恐竜をこの壁紙では集めました。 イラストは私が総監修した「学研の図鑑LIVE恐竜新版」という図鑑のもの。まずはこの壁紙を使った空 間で大好きな恐竜に囲まれた楽しく幸せな時間を過ごしてくださいね。さらにこの空間で図鑑を読みな がら恐竜の世界にタイムトラベルしてみてください。そして博物館に化石と展示を見にきてくださいね。
恐竜イラスト:「学研の図鑑LIVE恐竜新版」より © Gakken
「DAY AND NIGHT SCIENCE MUSEUM」の 特設サイトはこちら。 各分野研究者の方々へのインタビューなど、 誌面では紹介しきれない魅力もご紹介。



“四六時中・サイエンスミュージアム”
01 恐竜
CHAPTER :
D INOSAURS WORLD A ND MORE
219
RE55941 NEW
準不 燃
防火種別2- 3 AA 1,090円/㎡
巾92cm ↕124cm ↔ 92cm ●ステップ柄合せ 防か び











巾なり92cm



副館長 真鍋先生
私は、今から約2億5200万年前から約6600万年前の中生代に繁栄した恐竜やその他の 爬虫類化石を主な研究対象としています。私が子どもの頃は、恐竜は中生代末に絶滅してし まった、遠い過去の存在でした。しかし、その後、恐竜の一部は鳥類となって進化を続けているこ とが分かりました。恐竜の段階ですでに羽毛や翼をもっていて、どこまでが恐竜でどこからが 鳥類なのか境界線を引けないくらい連続的な進化がありました。今日でも新しい発見が続い ている成長著しい研究分野なのですよ。
壁紙:RE55941 カーテン:AC2584B(2023-2026 AC) 床材:WD-2031-W(2023-2026 FLOOR TILE)

国立科学博物館



National Museum of Nature and Science,Tokyo x SANGETSU, Special Project
RE55941
220



世界と日本の鳥の中からよりカラフルで鮮やかな鳥をセレクト。 個性的な色の鳥たちを眺めて、豊かな生態系を実感して。
国立科学博物館に剥製があるものの中から、世界の鳥と日本の鳥を混ぜつつ、色鮮やかで 見栄えがする鳥たちを集めた壁紙。なぜ鳥がカラフルかといえば、人と感覚が近く、視覚と 聴覚に頼るので、鮮やかな色で目立つ異性の鳥に恋心を持つからです。また、アマゾンなど 熱帯地域にいくほど色が鮮やかになる特徴も。鳥たちの多様な生態系を感じ取って。

動物研究部
動物研究部に所属し、鳥を研究しており、分子生態学というDNAを 使って生態を調べる分野が専門です。特に日本起源の鳥を調べ、どの ように世界に広がったかをDNAで立証しています。この壁紙を見て やっぱり鳥はカラフルだなと(笑)。特にキンバトには思い入れがあり、 西表島の調査で私が不在時に他の研究者たちが窓衝突した死体を 見つけて寄贈してくれたもの。




























B IRDS WORLD A ND MORE
鳥類 RE55942 巾なり92cm 壁紙:RE55942・55760 床材:WD-2031-W(2023-2026 FLOOR TILE) RE55942 NEW 221 防火種別2-3 AA 1,090円/㎡ 巾92cm ↕125cm ↕ 92cm ● ステップ柄合せ 防かび ▶ 施工注意 商品特性上、ベース原反に着色をしていないため、施工環境、条件、品番によってジョイント部分が白いライン状 に目立ちます。また断面がより目立ちやすくなるため、突き付けでの施工を避け、重ね切りで施工してください。 重ね切り施工時、カッターが斜めに入るとカット断面が目立ちやすくなるため、必ず垂直に入れていただき、ま た、下地を切らないようにご注意ください。特に濃色の商品については、目立ちやすくなるためご注意ください。 準不燃
CHAPTER : 02

明治時代から収集された日本のおし葉標本を一斉にズラリ! 長年に渡り人の手が積み重ねた緑の知識と、繊細で美しい葉形の展覧。
博物館に約130万点ほど収集されているおし葉標本の中で、日本に固有の植物をテーマに 形がユニークなものを集めたのがこの壁紙。各標本一つひとつにラベルがついており、 植物の名前はもちろん、採集された地名や日付、採集者も記載されています。そんなおし葉 標本をこんなふうに壁一面に並べて見られるのは、博物館でも滅多にないのだとか。

植物研究部
おし葉など植物の標本を収集して管理するのが私の
には約130万点くらいあります。この
私自身シダ植物を 分 類する研究が専門というのもあって「ミヤマイ タチシダ」。日本の山でよく見かけるシダですが、切れ込ん 形が美しいんですよ!



準不燃
防火種別2-3 AA 1,090円/㎡ 巾92cm ↕124cm ↕ 92cm 防かび



P LANTS A ND MORE
National Museum of Nature and Science,Tokyo SANGETSU, Special Project
CHAPTER : 03 植物
RE55943
巾なり92cm
RE55943
222
RE55943
NEW
国立科学博物館
CHAPTER : 04

色鮮やかで、ユニークな形が興味深い鉱物たちが世界各国から大集結。 鉱物は地球を作っている材料。雄大な自然のデザインをじっくり観察。
鉱物は岩石を作っている基本構成単位で、これが集まって岩石になり、大地を作り、地球を作っています。
そして一つの結晶が独自の形となり、大きくなったりすると非常に美しくなります。この壁紙ではそんな美 しさを感じてもらえるように色鮮やかで、形がはっきりしたきれいな石を世界各地から選びました。毛のよ うなものが生えていて濡れたら二度と元に戻らないモルデン沸石など鉱物の面白さをじっくり観察して。

地学研究部 門馬先生
鉱物を自分で採集しに行ったりして、入手し分析をする仕事をやっています。新種の鉱物を探 したり、既に知られているけれどよく分かっていない鉱物を調べます。この壁紙はゴージャス な印象ですね(笑)。私は家のクローゼットに貼りたいです。特に好きなのはハート型の水晶 (日本式双晶)。2個の結晶が双子になると単結晶の数十倍にも大きくなる不思議な石なんです。


























壁紙:RE55944・55084 床材:IS-2071-B(2023-2026 FLOOR TILE) RE55944 NEW
▶ 施工注意 商品特性上、ベース原反に着色をしていないため、施工環境、条件、品番によってジョイント部分が白いライン状に目立ちます。また断面がより目立ちやすくなるため、突き付けでの施工を避け、重ね切りで施工 してください。重ね切り施工時、カッターが斜めに入るとカット断面が目立ちやすくなるため、必ず垂直に入れていただき、また、下地を切らないようにご注意ください。特に濃色の商品については、目立ちやす くなるためご注意ください。 濃色の商品は、ひっかきキズや糊の拭き残しにご注意ください。



M
鉱物
RE55944
り92cm
223 防火種別2-3 AA 1,090円/㎡ 巾92cm ↕125cm ↕ 92cm ● ステップ柄合せ 防かび 準不燃
CHAPTER : 05 岩石

まだ生物が存在していなかった遥か昔にできた大地の産物……







National Museum of Nature and Science,Tokyo SANGETSU, Special Project
巾なり92cm
RE55945
RE55945 NEW 224 防火種別2-3 AA 1,090円/㎡ 巾92cm ↕124cm ↕ 92cm 防かび 準不燃
RE55945
国立科学博物館
CHAPTER : 06 海棲哺乳類

同じ哺乳類でも、比べ物にならないスケール感をもつ彼らが、 この日本の海で多種多様に息づいていること、知ってましたか?
国立科学博物館でも人気の「世界のクジラ」のポスター。実際のクジラは大きすぎて写真は撮れないため、 細密画でクジラを表現したもので、世界中の約90種類を掲載しています。この壁紙ではその中の約半分 にあたる、日本の周辺を回遊する45種類ほどのクジラとイルカをチョイス。50分の1スケールで描かれた 大小さまざまな海棲哺乳類たちが、部屋中を海遊する姿に思いを馳せて。

生活の拠点を海に託した哺乳類を研究対象としています。クジラやイルカの中には、シロナ ガスクジラのように全長30mを超える巨大な種もいますが、私たちと同じ仲間の哺乳類で ある非常に不思議な動物たちです。彼らの祖先は海からの陸上作戦に成功したにもかかわ らず、なぜか再び海に戻ってしまいました!約3500万年も昔の話ですが(笑)。





 RE55946
RE55946
RE55946 RE55946 NEW 225 防火種別2-3 AA 1,080円/㎡ 巾93cm ↕125cm ↕ 93cm ● ステップ柄合せ 防かび ▶ 施工注意 濃色の商品は、ひっかきキズや糊 の拭き残しにご注意ください。 準不燃
巾なり93cm
陸生哺乳類

世界各地に生息する動物の剥製がラインアップ。 勇ましいツノなどそのフォルムを形成した謎も想像して。
博物館の展示でも迫力がある動物の剥製。もともとはハワイのハンターの方が所有していたものでその 写真を使ってデザインした壁紙です。ヨーロッパバイソンやアフリカスイギュウといった世界各地に生息する 大小さまざまな動物の剥製は、よく見るとツノの形や体色がさまざまで、その理由を考えてみるのも知的好 奇心をくすぐります。中には絶滅危惧種など貴重なものも。

動物研究部 川田先生
僕は陸上の哺乳類の標本収集と管理をしています。特に研究しているのはモグラ!今だに 解明されていない彼らの謎に迫っています。ちなみに、この壁紙にはたくさんの種類の動物 がいますが、その全ての名前を言えるのはちょっと自慢です(笑)みなさんもチャレンジして みてください。最も好きなのはスイギュウですね、いつか飼ってみたいので。






B EASTS WORLD A ND MORE
CHAPTER : 07
National Museum of Nature and Science,Tokyo SANGETSU, Special Project
RE55947
巾なり92cm
226 防火種別2-3 AA 1,090円/㎡ 巾92cm ↕ 124cm ● 横使い 防かび
RE55947
RE55947 NEW
準不燃 国立科学博物館


暗い場所で見たときのイメージです。 消灯後の光り方イメージ









RE55951 ロングセラ RE55952 ロングセラ RE55953 ロングセラ ※ブラックライトを使用せずに
光のイルミネーション壁紙 浮かび上がる LED 対応 蓄光 ロングセラー イメージ写真を 全点見る 227 防火種別2-3 AA 1,090円/㎡ 巾92cm ↕64cm ↕ 92cm 防かび 準不燃 防火種別2-3 AA 1,090円/㎡ 巾92cm ↕64cm ↕ 92cm 防かび 準不燃 防火種別2-3 AA 1,080円/㎡ 巾93cm ↕64cm ↕ 93cm 防かび 準不燃 蓄 光
通常照明の場合 RE55951 RE55952 RE55953
通常照明の場合

光を蓄えて消灯後に約20分間 やわらかな光を発します。
※光源によって色の見え方が異なります。
蛍光灯・LED照明・ブラックライト・ 自然光下で効果があります。
※施工例写真はブラックライト使用時のものです。
※白熱電球には効果がありません。


ブラックライトを照射し続けると、 発光状態を保つことができます。



NEW
準不燃
防火種別2-3 AA 1,090円/㎡ 巾92cm ↕64cm ↕ 92cm ● ステップ柄合せ 防かび

NEW
準不燃
防火種別2-3 AA 1,090円/㎡ 巾92cm ↕64cm ↕ 92cm ● ステップ柄合せ 防かび



準不燃
防火種別2-3 AA 1,090円/㎡ 巾92.5cm ↕64cm ↕ 92.5cm 防かび ▶ 施工注意 濃色の商品は、ひっかきキズや糊の拭き残しにご注意ください。
RE55954
RE55955
RE55956
RE55954
RE55955
RE55956
イメージ写真を 全点見る 228
蓄光 蓄 光
HIGH GRAFICA
Select Order
受注生産品 不燃
デジタルプリント壁紙「ハイグラフィカ」の新シリーズ。
指定サイズの品番を選ぶだけでオーダーが可能です。
おうちアクアリウム
サンシャイン水族館の大水槽「サンシャインラグーン」がお部屋に! マリンブルーの世界で心からリラックスできます!
全15カテゴリーのバリエーションは WEBサイトをcheck!
470点以上 の豊富なラインアップ サンゲツ セレクトオーダー
Landscape photo
風景写真

壁紙:HZ-7037L・RE55483・55233
床材:WD-2036-W
HZ-7037 サンシャイン アクアリウム #1

サイズ・価格
Lサイズ(4巾)
HZ-7037L
サイズ:W3600mm×H2500mm 価 格:108,000円/セット
Mサイズ(3巾)
HZ-7037M
サイズ:W2700mm×H1875mm 価 格:60,750円/セット
Sサイズ(2巾)
HZ-7037S
サイズ:W1800mm×H1250mm
価 格:27,000円/セット

〈ご注文時の注意点〉
・�別サイズでの制作も可能ですが、価格が異なりますので別途お問い合わせください。
データによっては拡大した際に画質が粗くなる可能性があります。
・追加で発注をされる場合、同データを使用しても多少の⾊差が発生することがあります。
・インクジェット品の特性として左右の⾊味が正確に合わない場合があります。
・�パソコン画面と壁紙への印刷の場合では見え方が異なります。
デザインや⾊の確認の際は必ず現品見本をご確認ください。
・�表面を強く擦ると⾊落ちすることがあります。
拭き取りを⾏う際は固く絞った布等で優しく拭き取ってください。
※ハイグラフィカは見本帳の有効期間が異なります。
当見本帳期中に価格改定となる可能性もございますのでご了承ください。
�両サイドの10mmを重ねしろとして柄を 合わせて重ね断ちにて施工してください。
特殊掛率品
D-003 サンド調 防かび W(巾)
右から順に施工してください。 ① 天 地 ② 製品規格・割付け ※�商品に番号の印字がありますので 右から順に施工してください。 ① ← ← ← ② ③ ④ (H) 900mm 900mm 900mm 900mm ※��プリント巾は920mmです。
製品1巾 920mm(プリント巾) 900mm(有効巾) H (高さ) 229
ベース壁紙 ※�巻き取りとなっていますので、
クラゲ水族館
サンシャイン水族館の「海月空感」が壁紙に! クラゲの神秘的な浮遊感に癒されます。

壁紙:HZ-7039L・RE55629
床材:IS-2063(2023-2026 FLOOR TILE)

※ご注文時の注意点はP.229をご覧ください。
HZ-7038 サンシャイン アクアリウム #2

HZ-7003 セブ島の海

HZ-7009 波照間島 ニシ浜 #1

サイズ・価格
Lサイズ(4巾)
サイズ:W3600mm×H2500mm
価 格:108,000円/セット
Mサイズ(3巾)
サイズ:W2700mm×H1875mm
価 格:60,750円/セット
Sサイズ(2巾)
サイズ:W1800mm×H1250mm
価 格:27,000円/セット

HZ-7039L HZ-7039M HZ-7039S 特殊掛率品
▲ D-003 サンド調 防かび ベース壁紙
その他の風景写真のデザインはこちら
W(巾) H (高さ)
W(巾) H (高さ)
W(巾) H (高さ)
ライトブルー W(巾) H (高さ) 230 ハイグラフィカ
HZ-7039 クラゲアクアリウム
おうちキャンプ
世界遺産の白神山地のブナ林をリビングに。大自然の中にいるような空間が楽しめます。

HZ-7042L・RE55246・55613
HZ-7008 メタセコイアの森

HZ-7028 富良野 緑地公園

HZ-7033 軽井沢 森の朝 HZ-7042 白神山地 ブナ林

※ご注文時の注意点はP.229をご覧ください。
サイズ・価格
Lサイズ(4巾)
サイズ:W3600mm×H2500mm
価 格:108,000円/セット
Mサイズ(3巾)
サイズ:W2700mm×H1875mm
価 格:60,750円/セット
Sサイズ(2巾)
サイズ:W1800mm×H1250mm
価 格:27,000円/セット


HZ-7042L HZ-7042M HZ-7042S 特殊掛率品
D-003 サンド調 防かび ベース壁紙 W(巾) H (高さ) W(巾) H (高さ) W(巾) H (高さ) W(巾) H (高さ)
231
おうち森林浴
日本一美しい八千穂高原の白樺林で森林浴。おうちの中でグリーンを感じながら、心も体もリフレッシュ!

壁紙:HZ-7001L
床材:WD-2028(2023-2026 FLOOR TILE)
HZ-7043 奥入瀬渓流

HZ-7044 奥蓼科 御射鹿池

HZ-7045 備瀬 フクギ並木

HZ-7001 八千穂高原 白樺林

※ご注文時の注意点はP.229をご覧ください。
サイズ・価格
Lサイズ(4巾)
サイズ:W3600mm×H2500mm
価 格:108,000円/セット
Mサイズ(3巾)
サイズ:W2700mm×H1875mm
価 格:60,750円/セット
Sサイズ(2巾)
サイズ:W1800mm×H1250mm
価 格:27,000円/セット

サンド調 防かび
HZ-7001L HZ-7001M HZ-7001S 特殊掛率品 D-003
ベース壁紙
W(巾) H (高さ) W(巾) H (高さ) W(巾) H (高さ)
その他の風景写真のデザインはこちら ▲ W(巾) H (高さ)
232 ハイグラフィカ
]

遥かな山のいただきを目指しお子さま の健やかな成長をともにできる雄大な グラフィックです。 アニマルグロース マウンテンメーター
可愛らしい動物たちとともにお子さまの 成長の記録が測れる身長計をお部屋の アクセントとして取り入れてみませんか?


サイズ・価格
サイズ・価格
1巾サイズ HZ-7510T HZ-7509T
サイズ:W900mm×H2500mm 価 格:24,000円/枚

※ご注文時の注意点はP.229をご覧ください。
1巾サイズ
サイズ:W900mm×H2500mm 価 格:24,000円/枚

※�製品の性質上、寸法は正確ではない場合がありますのでお含みおきください。 ※多少の⾊ムラが生じる可能性がございます。
※巾木の寸法をご確認のうえ、床上からの目盛りの位置を合わせて施工してください。 HZ-7509T・RE55231
特殊掛率品
W900mm H2500mm W900mm H2500mm D-003 サンド調 D-003 サンド調 防かび 防かび ベース壁紙 ベース壁紙
70 60 50 40 30 20 180 160 140 120 100 80 60 40 20 233
Art & Illustration アート & イラスト [ 身長計

HZ-7503T・RE55141

HZ-7504T・RE55142
プリンセスメモリー ジョイフルツリー
北欧調のカラフルなツリーに 一度しかないお子さまの成長を 記録してみませんか。

サイズ・価格
サイズ:W900mm×H2500mm 価 格:24,000円/枚
メモリの入ったキュートなお城。
わが家のお姫様の成長を 思い出に残せる壁紙です。

サイズ・価格
1巾サイズ
1巾サイズ HZ-7504T HZ-7503T サイズ:W900mm×H2500mm 価 格:24,000円/枚

※ご注文時の注意点はP.229をご覧ください。
※�製品の性質上、寸法は正確ではない場合がありま すのでお含みおきください。
※多少の⾊ムラが生じる可能性がございます。
※�巾木の寸法をご確認のうえ、床上からの目盛りの位 置を合わせて施工してください。

特殊掛率品
W900mm H2500mm W900mm H2500mm D-003 サンド調 D-003 サンド調 防かび 防かび ベース壁紙 ベース壁紙
▲ 234 ハイグラフィカ
その他のアート&イラストの デザインはこちら
マグネット
サンマグネシタジ(下地材)
壁紙と組合わせて使用する鉄粉入りの下地材です。お好みの壁紙がマグネットボードに。
マグネット

K304
非防火
巾92cm ×12m乱巻 0.85mm厚
SS 9,790円/㎡(9,000円/m)
〈使用イメージ〉
磁力評価(参考値)
紙厚:64g/㎡
マグネットの種類 A4サイズ A3サイズ
丸形マグネット(2個止め) コクヨマク-40NB 2枚 1枚
マグネットバー コクヨマク-T201NB 200L 2枚 1枚
※K304の上にFE76217を施工した場合の測定値です。
※上記の試験結果は測定値であり、保証値ではありません。
※磁力の目安を示す資料です。掲載している磁石を推奨するものではなく、磁力の強い磁石を 使用されることをおすすめします。
〈施工ならびにご使用上のご注意〉
着磁性能は上貼りする壁紙によって異なります。厚みのある壁紙や凹凸の深い壁紙を上貼 りすると十分な性能が発揮されない場合があります。事前にサンプル等でご確認ください。 サンマグネシタジを巾継ぎした上から壁紙を施工すると、壁紙表面に継ぎ目部分の段差 が浮き出るおそれがあります。化粧断ちをしたうえで、入念なパテ処理をしていただくこと をおすすめします。
上に貼る壁紙はサンマグネシタジが十分に接着されていることを確認した上で施工して ください。
製品重量が重いため、施工難易度が高い商品です。現場状況によっては複数名で施工し てください。
裏面に鉄粉シートを使用しており、製品側面・小口がサビにより経年で変色するおそれ があります。
布ウラの商品です。ベンリダインミックス糊(BB-307)を相手糊にして施工してください。
貼り替えの現場の場合、下地に裏紙が残った状態で施工すると接着不良に繋がるおそ れがありますので、適切な下地処理を行ったうえで施工してください。
詳細はWEBサイト上の「施工要領書」をご確認ください。
(二次元コードよりアクセスできます。)
サンマグネット
鉄粉入りのため、マグネットでの掲示も可能な掲示板クロスです。




マグネット 画鋲・ピン
非防火
巾92cm ×12m乱巻 0.75mm厚 製品重量:2.0kg/㎡
SS 9,790円/㎡(9,000円/m)
磁力評価(参考値)
紙厚:64g/㎡
マグネットの種類 A4サイズ A3サイズ
丸形マグネット(2個止め) コクヨマク-40NB 3枚 2枚
マグネットバー コクヨマク-T201NB 200L 5枚 3枚
※上記の試験結果は測定値であり、保証値ではありません。
※磁力の目安を示す資料です。掲載している磁石を推奨するものではなく、磁力の強い磁石を 使用されることをおすすめします。
〈施工ならびにご使用上のご注意〉
製品重量が重いため、施工難易度が高い商品です。現場状況によっては複数名で施工し てください。
裏面に鉄粉シートを使用しており、製品側面・小口がサビにより経年で変色するおそれ があります。
布ウラの商品です。ベンリダインミックス糊(BB-307)を相手糊にして施工してください。
貼り替えの現場の場合、下地に裏紙が残った状態で施工すると接着不良に繋がるおそ れがありますので、適切な下地処理を行ったうえで施工してください。
巾継ぎして施工した場合、ジョイント部分が目立つことがあります。
詳細はWEBサイト上の「施工要領書」をご確認ください。
(二次元コードよりアクセスできます。)

特殊掛率品
K308
K302 K303 K308
サンマグネシタジ 下地 K304(サンマグネシタジ)+RE55147・55148・55021 235
壁紙
ホワイトボード
ニューサンホワイトボード
プロジェクター マグネット マーカー
ホワイトボード専用マーカーでの書き消しや、マグネットでの掲示が可能です。プロジェクター投映にも対応します。

K351-1
非防火
巾93cm ×12m乱巻 0.85mm厚
SS 20,970円/㎡(19,500円/m)
K351-2
非防火
巾121cm ×9m乱巻 0.85mm厚
SS 21,080円/㎡(25,500円/m)
マグネットの種類 A4サイズ A3サイズ
丸形マグネット(2個止め) コクヨマク-40NB 3枚 2枚
マグネットバー コクヨマク-T201NB 200L 5枚 3枚
※上記の試験結果は測定値であり、保証値ではありません。 ※磁力の目安を示す資料です。掲載している磁石を推奨するものではなく、磁力の強い磁石を 使用されることをおすすめします。
磁力評価(参考値) 紙厚:64g/㎡ 〈施工ならびにご使用上のご注意〉
ジョイント部分が目立つことがありますので、あらかじめお含みおきください。光の角度によって は、商品の表面が若干波打ったように見える場合があります。壁紙用の接着剤で施工できるよ うに、商品裏面をメリヤスにしてあります。製品重量が重いため、施工難易度が高い商品です。 現場状況によっては複数名で施工してください。商品の端部が鋭利なため、手を切らないように 注意してお取り扱いください。使用環境によっては光源の映り込みが発生する場合があります。 より精度の高い投映性能をお求めの場合は「リアテック ホワイトボードシート」をおすすめしま す。裏面に鉄粉シートを使用しており製品側面・小口がサビにより経年で変色するおそれがあり ます。布ウラの商品です。ベンリダインミックス糊(BB-307)を相手糊にして施工してください。貼 り替えの現場の場合、下地に裏紙が残った状態で施工すると接着不良に繋がるおそれがありま すので、適切な下地処理を行ったうえで施工してください。巾継ぎして施工した場合、ジョイント 部分が目立つことがあります。筆記には推奨マーカー・推奨イレーザーをご使用ください。推奨 マーカー・推奨イレーザー以外をご使用の場合、筆記性・消去性に問題が出ることがあります。 詳細はWEBサイト上の「施工要領書」をご確認ください。(二次元コードよりアクセスできます。)
リアテック ホワイトボードシート

プロジェクター マーカー
ホワイトボード専用マーカーでの書き消しや、プロジェクター投映に対応する粘着剤付化粧フィルムです。金属板と 合わせることでマグネットで掲示が可能です。また、TW-1000に限り、目地に折り曲げて施工することができます。

TW-1000
(無地テクスチャー)
不燃
防火種別1-4
書き消し + 投映
巾122cm SS 9,500円/㎡(11,400円/m)

TW-2000
(無地テクスチャー)
非防火
防火種別6-2
書き消し専用
巾122cm SS 9,500円/㎡(11,400円/m)

TWP-2001
(抽象テクスチャー)
非防火
防火種別6-2
書き消し専用
巾122cm SS 9,800円/㎡(11,760円/m)
機能比較
ホワイトボードマーカーでの 書き消し プロジェクター投映 折り曲げ施工
※推奨マーカー・イレーザーで書き消し可能
防火性能
TW-1000 ○※ ○ ○ TW-2000 ◎ × × TWP-2001 不燃材料 不燃石膏 ボード 準不燃材料 金属板 アルミニウム 合金板 TW-1000 不燃 不燃 準不燃 不燃 不燃 TW-2000 不燃 不燃 TWP-2001
※TW-2000およびTWP-2001は不燃材料、不燃石膏ボード、準不燃材料に施工した場合、 非防火になりますのでご注意ください。
※TW-1000・TW-2000・TWP-2001の表示価格や製品仕様、および継廃は 2024-2026リアテックvol.12掲載時のものであり、予告なく改定する場合があります。
最新情報につきましては、弊社営業窓口までお問合せください。
〈施工ならびにご使用上の注意〉
ジョイント部分が目立つことがありますので、あらかじめお含みおきください。基本的な施 工方法は一般的なリアテックに準じますが、一部特性が異なります。詳細は最新のリア テック見本帳をご確認ください。下地の凹凸が筆記性や消去性、投映画像に影響を与え ますので入念な下地処理をお願いします。フィルムへの光の照射具合によって、表面に細 かなキズやムラが見える場合があります。筆記には推奨マーカー・推奨イレーザーをご使 用ください。推奨マーカー・推奨イレーザー以外をご使用の場合、筆記性・消去性に問題 が出ることがあります。詳細はWEBサイト上の「施工要領書」をご確認ください。 (二次元コードよりアクセスできます。)

施工要領書は WEBページよりご覧ください
特設ページは WEBページよりご覧ください
特殊掛率品
K351
TWP-2001
236
マグネット・ホワイトボード
スマートジョイナー(見切り材)
スマートジョイナー SLIM 平面用
壁紙のジョイント部分を美しく演出する、平面用見切り材 巾7mmの細身でスタイリッシュな見切り材。アタッチメントをあらかじめ下地に施 工しておく先付けタイプの平面用見切り材です。

POINT 1
下地に施工したアタッチメントにジョイナー 本体をはめ込んで取り付け
ジョイナー本体
施工イメージ
スマートジョイナー EASY 平面用
シンプルなデザインで取り付けも簡単な、後付けタイプの平面用見切り材 壁紙の上から簡単に取り付けることができる、巾10mmの平面用見切り材です。

POINT
付属の両面テープと瞬間接着剤(BB-546)を併用し て壁紙の上から簡単に取り付けることができます。

POINT 2
アタッチメント
さまざまなインテリア空間に馴染むシンプル な形状

7mm
① 付属の両面テープと接着剤を併用 して下地にアタッチメントを取り 付ける
② パテ処理をして下地とアタッチメ ントの段差を平滑にする
③ 壁紙を貼る
④ ジョイナー本体を取り付ける
壁紙
下地(石膏ボードなど)
※ 詳細はP.238の二次元コードよりご確認 ください
スマートジョイナー CORNER コーナー用
コーナーの補強・貼り分けに最適
コーナー部分の補強や、出隅での壁紙の貼り分けを可能にする後付けタイプのコーナー用見切り材です。

ジョイナー本体
(H2,500mm×7mm巾)
アタッチメント
(H2,500mm×46.5mm巾)
約2.2mm
約2.2mm
約1mm
約1mm 46.5mm 3mm 約0.6mm
両面テープ 両面テープ
ジョイナー本体とアタッチメントは別売りとなります。 ジョイナー本体(SRJ-211~252)と、アタッチメント(SRJ-AT1)の2種類の部材をご注文いただき、 施工をお願いいたします。
POINT
付属の両面テープと瞬間接着剤(BB-546)を併用し て壁紙の上から簡単に取り付けることができます。
下地(石膏ボードなど)
壁紙
規格 H2,500mm×10mm巾(90°)
パテ
2,500mm
2,500mm 7mm
2,500mm 10mm 1.5mm 両面テ プ 2,500mm 両面テープ 10mm 10mm 1.5mm 1.5mm 2,500mm
10mm 10mm 1.5mm 1.5mm
両面テープ
特殊掛率品
237 ー ー



■ スマートジョイナー 本体価格一覧








施工要領書はこちら スマートジョイナーの施工方 法についてはこちらの二次元 コードより施工要領書をご確 認ください。
■ スマートジョイナーSLIM アタッチメント
品番:SRJ-AT1 価格:600 円/本
特殊掛率品 カラー・材質 単色 材質:ABS樹脂オレフィンシート貼 メタリック 材質:ABS樹脂PVCシート貼 カラーイメージ ホワイト オフホワイト アイボリー ライトグレージュ ウォームグレー ブラック シルバー シャンパンゴールド スマートジョイナー SLIM (アタッチメントは別売です) SRJ-211 600 円/本 SRJ-212 600 円/本 SRJ-213 600 円/本 SRJ-214 600 円/本 SRJ-215 600 円/本 SRJ-216 600 円/本 SRJ-251 900 円/本 SRJ-252 900 円/本 スマートジョイナー EASY EGJ-411 1,200 円/本 EGJ-412 1,200 円/本 EGJ-413 1,200 円/本 EGJ-414 1,200 円/本 EGJ-415 1,200 円/本 EGJ-416 1,200 円/本 EGJ-451 1,500 円/本 EGJ-452 1,500 円/本 スマートジョイナー CORNER SCN-11 1,200 円/本 SCN-12 1,200 円/本 SCN-13 1,200 円/本 SCN-14 1,200 円/本 SCN-15 1,200 円/本 SCN-16 1,200 円/本 SCN-51 1,500 円/本 SCN-52 1,500 円/本
EGJ-416・RE55879・55045 SRJ-251・SRJ-AT1・RE55666 SCN-12
238 スマ ー トジョイナ ー
モールド(装飾用見切り材)
天井の廻り縁や腰壁の見切り、額縁などに使用することで、 インテリアをエレガントに演出します。
商品の特長
■ グレードアップ 高いデザイン性で、ワンランク上のラグジュアリーな空間を 演出します。ヨーロッパの伝統的なインテリアから、 モダンなスタイルまで幅広くお使いいただけます。
■ スピード施工
寸法安定性に優れ、加工性もよく作業効率もアップします。
【額縁】

【廻り縁】

商品ラインアップは WEBページより ご覧ください
壁の仕上げ材を上下で分ける際の 見切りとして、また、壁面に設置す る絵画等の額縁やアクセント装飾 として幅広く使用できます。
MM 90(額縁)
天井と壁の接地部に使用すること で、お部屋のインテリアをグレード アップさせます。
MM 80(廻り縁)
※別途施工要領書をご用意しております。
弊社営業窓口までお問い合わせください。
※厚み・サイズ・色に多少のばらつきがございます。
施工時に現場にて調整してください。
※モールドは見本帳の有効期間が異なります。
当見本帳期中に価格や仕様が変更になる場合があります。

MM 81・MM 84 特殊掛率品
239
ラウファーザー
環境先進国ドイツで生まれた自然素材の塗装下地用壁紙
1. エコロジーな塗装下地用壁紙
耐久性に優れ、仕上がりがきれいな「フリース」、再生紙の間にウッドチップを漉き込んだ「チップス」、それぞれの素材 感が特徴的な塗装下地用壁紙です。化学物質を使用していませんのでVOCなどの有害物質は発生しません。
2. ブルーエンジェルマークを取得(チップスのみ)
ドイツ連邦環境庁が推進している環境ラベル制度で、エコマーク同様一定の基準を満たした環境負荷の少ない製品に 対して交付されます。
3. 水性アクリル樹脂系塗料を塗装して準不燃認定取得
下表のように下地とラウファーザーと水性アクリル樹脂系塗料の組み合わせにより準不燃の防火認定を取得できます。
下地基材 不燃材料 不燃石膏ボード 準不燃材料 金属板
防火認定 準不燃 準不燃 準不燃 ※ラウファーザーは塗装下地用壁紙です。無塗装仕上げとした場合、汚れやキズがつきやすく、ジョイントが 目立つ等の不具合が発生するおそれがあります。

PW-43

PW-41 [フリース]
非防火
巾100cm
C 2,200円/㎡
▶ 施工注意
MADE IN GERMANY

PW-42 [チップス]
非防火
巾75cm
A 940円/㎡
▶ 施工注意
MADE IN GERMANY

PW-43 [チップス]
非防火
巾75cm
A 940円/㎡
▶ 施工注意
MADE IN GERMANY
▶「ラウファーザー」の施工上の注意
接着剤はベンリダイン・ミックス糊(BB-307)をおすすめします。
※ラウファーザーは見本帳の有効期間が異なります。当見本帳期中に価格改定となる可能性もございますのでご了承ください。
240 モールド ラウファーザー
カラーコーク・接着剤
推奨接着剤・副資材カタログ
■カラーコーク
豊富なアクセントクロスにも対応!
カラーコークが 36 色展開にボリュームアップ!
全点
常備在庫

コンパクトな
200gタイプも ご用意

32色展開
品番 容量
BB-100〜BB-131 200 g/本
● 主成分 :アクリル共重合樹脂
● 施工可能m数 :40m/200g
● 適応下地 :石膏ボード
● 入り単位 :10本/ケース、5ケース/BOX
用途
使用方法
注意事項
内装用ワンタッチコーキング剤


4色展開
品番 容量
BB-467〜BB-470 500 g/本
● 主成分 :アクリルエマルション樹脂
● 施工可能m数 :100m/500g
● 適応下地 :石膏ボード
● 入り単位 :6本/ケース、4ケース/BOX
枠周りなどに付着しないように、養生テープなどで適切に処置してください。充填前に表面の汚れを落とし、ノズルの先端を 適度に切り落とします。充填後に指を水に濡らして平らにしてください。使用後はノズルの先端をテープで保護してください。 差し込む隙間が広い場合はお使いいただけません。実際の商品の色と見本帳掲載の色では見え方が異なりますので、ご注 意ください。硬化前の色と目標色に差がある場合がありますが、硬化後に変化し、目標色に近づきます。予告なく価格、仕 様、ラインナップを変更する場合があります。壁紙の品番毎に「おすすめカラーコーク」を掲載していますが、壁紙とは多少の 色差がありますのでご了承ください。
■接着剤


壁紙、床材の施工に使えるサンゲツの推奨 接着剤・副資材のカタログです。価格につ いてはWEBカタログにてご確認ください。 ※ベンリダインは見本帳の有効期間が異なります。当見本帳期中にベンリダイン見本帳が切り替わり、掲載商品や価格等に変更が生じる可能性もございますのでご了承ください。
◀︎WEBカタログはこちら サンゲツ ベンリダイン
でんぷん糊のスタンダードタイプ
● 室内環境に優しいホルマリンを含まない接着剤です。
NEW サンゲツ糊 JIS / F☆☆☆☆
品番 容量
BB-378 18 kg
● 主成分 :澱粉 ● 色 :白色
● 適応下地 :石膏ボード
用途 各種壁紙用接着剤
● JIS分類 :2種1号
● 施工可能面積 :180㎡/18kg
使用方法 糊と水の調合比率は10:7を基本として、均一に混ぜ合わせて ください。
原液タイプ


※印は500gのタイプです。それ以外は200gのタイプにてご用意しています。
ビニル壁紙〜エコ系壁紙にも対応
● 酢ビの配合により、高い接着力を発揮します。
● 室内環境に優しいホルマリンを含まない接着剤です。
● 貼り付け可能時間が長くゆとりをもって施工できます。
ミックス糊100 JIS / F☆☆☆☆
品番 容量 BB-304 18 kg(6 kg × 3 袋)
● 主成分 :澱粉・酢ビ
● 色 :白色
● 適応下地 :石膏ボード
● JIS分類 :2種2号
● 施工可能面積 :100~120㎡ /18kg
用途 各種壁紙用接着剤 使用方法 原液のまま使用してください。
BB467 ※ ホワイト BB129 ブルーホワイト BB118 スカイグレー BB122 シャドーホワイト BB109 ライトグレー BB126 ダークホワイト BB119 グレー BB107 アッシュグレー BB116 モスグレー BB117 ダークグレー BB121 ローズグレー BB469 ※ ライトアイボリー BB468 ※ アイボリー BB112 ライトナチュラル BB113 ナチュラル BB120 ライトベージュ BB470 ※ ニューベージュ BB106 ベージュ BB124 エクルベージュ BB123 サンドベージュ BB125 サニーブラウン BB130 ライトブラウン BB108 キャラメル BB115 ブラウン BB100 ブラック BB114 ダークブラウン BB111 ライトブルー BB128 ブルーグリーン BB127 ブルー BB105 ダークブルー BB110 パープル BB104 ライトパープル BB103 ライトピンク BB102 イエロー BB101 ライトグリーン BB131 オリーブグリーン
カラーコーク色一覧 (全36色)
水性 小分け3袋
水性
希釈タイプ
特殊掛率品
200g 500g
241
壁紙の材料特性に関する注意
1 ジョイントや剥がれについて
壁紙は石膏ボードなどの下地材に有効巾でジョイントして施工するため、 必ず継ぎ目が生じます。壁紙の仕様やデザイン、使用環境によっては継ぎ目 が目立つ場合がありますのでご了承ください。また、壁紙の伸縮による目 や経年での剥がれが生じる可能性があります。
2 変色について
壁紙自体は外的な影響を受けずに変色することはありません。紫外線によ る色褪せや、施工環境・使用環境によって変色・シミなどの変化が生じる場 合があります。
施工上の注意(一般的な壁紙)
1 下地の調整
■ 下地の平滑仕上げ
壁紙の厚みはおおよそ1㎜未満であり、下地の凹凸を壁紙だけで防ぐことは できません。下地が平滑になるよう、施工環境に応じた入念な下地処理を 行ったうえで壁紙を施工してください。また、ネジ・クギ類も施工後の不陸や 変色等の原因になるため、突起を完全に沈め、サビ止め処理をしてくださ い。パテが壁紙に付着した場合は、壁紙の凹部に入り込まないよう慎重に 除去するようにしてください。
■ 下地や状況に応じたシーラー処理 木質系・合板下地・コンクリート下地・モルタル下地に直接施工すると、壁 紙にシミや変色が発生することがあります。それぞれ専用のシーラーで必ず 下地処理をしてください。シーラー処理を施すことで、接着不良や変色を防 ぎ、また、リフォーム時に剥がしやすくなります。
■ 下地と同色のパテを使用 パテは下地と同色のものをご使用ください。下地と異なる色のパテを使用 すると、施工後に下地の色が透けて見える場合があります。
■ 下地は乾燥させてから コンクリートやモルタルなどの湿式下地、およびシーラー・パテを施した箇 所は十分に乾燥(水分率11%以下)してから施工を開始してください。乾燥 が不十分な場合、壁紙の変色・剥がれ・かびが発生することがあります。
■ 浮いた裏打紙の処理 貼り替え時、以前貼られていた壁紙の裏紙が残っている場合、残った裏紙 は完全に剥がしてから施工してください。そのまま施工すると目 や浮きの 原因になります。
■ 下地起因の変色等について 下地及び下地の内側からの影響を受けて、壁紙に変色やかびなどが発生す る場合があります。石膏ボード下地の場合でも、木質構造材や断熱材等さ まざまな施工環境要因で、明確な原因の特定が困難な変色が発生する可 能性がありますのでご了承ください。
2 接着剤
■ 商品や施工環境に合わせた準備 商品特性や施工環境に合わせて接着剤の配合やオープンタイムを調整した り、部屋を暖めるなど配慮してください。特に5℃以下の環境では接着力が弱 く、施工不良の原因になりますので、接着剤の注意事項を必ず守ってください。
■ 希釈・塗布量 接着剤の希釈は、接着剤メーカーの指定割合を守ってください。 塗布量は130~140g/㎡を目安とし、均一に塗布してください。
特に注意が必要な商品
デザインや製法、機能性などによる商品特性の違いや施工環境によって、壁 紙の施工難易度は変わります。特殊な製法や素材を用いた壁紙や製品厚の 薄い壁紙、汚れ防止機能のある壁紙などは、通常の壁紙と比較して施工難 易度が高いため、施工費が割増しになる場合があります。各商品に表示して いる施工注意と以下の内容をあらかじめご確認の上、商品をご選定いただ きますようお願いいたします。
■ 製品厚の薄い商品・表面がフラットな商品 間接照明の場合など使用環境によっては下地の凹凸が目立ちやすい商品 です。特に入念な下地処理を行い、糊ダマリに注意して施工してください。糊 付け後は大きくたたみ、折りジワに注意して、上積みは避けてください。また 見る角度や環境によってジョイント部分が目立つ場合があります。
3 表面強度について 衝撃やひっかき、摩擦によってキズや破れが発生する場合がありますのでご 注意ください。
4 ひび割れについて 建物や下地の振動により、壁紙表面にひび割れ(クラック)が生じることが あります。特に異なる下地材のジョイント部分や、構造材がない部分での下 地のつなぎ部分では、振動等による動きが大きくなり、壁紙がひび割れやす くなります。壁紙単体では振動によるひび割れを防ぐことはできませんので ご了承ください。
■ 糊付け後の注意点 壁紙に糊付け後、適切なオープンタイムを取ってください。施工を容易にす るとともに、フクレや目 の発生を防ぎます。また、壁紙をきつく折りたたん だり、湾曲部に荷重がかからないようにしてください。折りジワが発生し、元 に戻らない場合があります。
[糊付け後のたたみ方]
重ね置きをする場合は、図のように 丸めておくことをおすすめします。 また、専用ボックスに立てて入れて おくと、折りジワを防止できます。
3 貼り付け
■ ロット番号・施工上の注意の確認 同じ空間に施工する場合は、同一ロットの商品をご使用ください。別ロット 品で施工した場合、色違い等の不具合が生じることがあります。また、施工 上の注意も十分にご確認の上、施工するようにしてください。
■ 有効巾について 壁紙は必ず有効巾でご使用ください。重ねしろは有効巾に含みません。有効 巾を超えた使用は、左右色違いの原因となります。
■ 石膏ボード下地の注意点 カッターで石膏ボードの原紙まで切り込むと目 の原因となりますので、 カットの際は下敷きテープをご使用ください。また、ボードの継ぎ目付近で はジョイントしないでください。仕上がりに支障をきたすことがあります。
■ ベニヤ下地の注意点 ベニヤなどの木質下地に重ね断ち施工する場合、カッターでシーラー塗布面 を傷つけますとアクの滲み出しによる変色の原因になります。カットの際は必 ず下敷きテープを使用し、シーラー塗布面を傷つけないようにしてください。
■ 柄合わせについて
柄合わせの必要な商品は見本帳に「リピート」を表示しています。
リピートの値は理論値であり誤差が生じます。施工の際は、ジョイントマー クを参考に柄を目視で合わせて重ね断ちにて施工してください。
5 色の見え方について
見本帳の現品見本や写真と実際の商品では、多少の色差が生じる場合が あります。光源や使用環境によっても色が違って見える場合があります(メ タメリズム)。また、製造時のロットによって多少の色差が生じる場合があり ますのでご了承ください。
■ 濃色の商品 ひっかきキズや糊の拭き残しが目立ちやすいため、特に注意して施工してく ださい。出隅・入隅への施工の際に、硬い刷毛や布などで強く擦ると表面が 白化する場合があります。表面を過度にこすったり拭いたりすると、ツヤ感が 変わるおそれがありますのでご注意ください。
■ 横に方向性のあるデザイン 横に方向性のあるデザインについては、通常の商品よりもジョイントが目立 ちやすく、正確な柄合わせが困難です。あらかじめご了承ください。
■ フィルム汚れ防止・スーパー耐久性
モルタル・ベニヤ下地に施工する場合は、フクレやアクを防ぐため、シーラー
■ ジョイント位置について ジョイントは商品の端部同士としてください。端部と中央部でジョイントし た場合、色差が生じるおそれがあります。また、天地・左右を確認の上、同一 方向で施工してください。特に開口部の上下への施工や、貼り足しや部分補 修で残材を使用する場合、一部分のみを横貼りにすると色違いが起こりや すいため、ご注意ください。
[壁紙端部の表示について] ジョイントマーク ▼ 商品の両耳部に入っています。

天地マーク ▼ 商品の左耳部に入っています。

■ 付着した接着剤や汚れの処理 壁紙の表面や廻り縁などに糊・汚れなどが付かないよう十分ご注意くださ い。付着した場合は、きれいな水を含ませた布で直ちに拭き取り、最後に乾 拭きしてください。糊や汚れが付着したまま放置すると、かびや変色の原因 になります。
■ 貼り出し確認 品質には万全を期しておりますが、念のため壁紙を3巾ほど施工した時点で 商品に問題のないことをご確認ください。明らかに欠陥があると判断された 場合には、直ちに作業を中断し販売店または弊社営業窓口までご連絡いた だきますようお願い申し上げます。3巾以降の施工費賠償については、お受 けいたしかねますのでご了承ください。
4 養生
■ 施工後は自然乾燥を 施工後は、接着剤が安定するまで自然乾燥させてください。急速に乾燥させ ると剥がれ・めくれなどの原因になります。
■ 養生テープについて 粘着力の強いテープの使用は破れや汚れ、変色の原因になりますのでご注 意ください。
処理をしてください。オープンタイムは長めに取ってください。オープンタイム 不足はフクレ等の原因になることがあります。糊付け後は折りジワがつかな いように大きくたたみ、上積みは避けてください。エアーや水分が抜けにく く、特に低温時にはフクレが生じやすいためご注意ください。出隅の納めの 際は折り曲げた壁紙の表面からきれいな布でしっかりとおさえてください。 施工後は表面に付着した糊や汚れをきれいに拭き取ってください。拭き残 しがあると変色の原因になることがあります。
■ ふりまき壁紙(MEGUReWALL / 珪藻土 / 大理石チップなど) 一般ビニル壁紙とは素材が異なりますので施工やメンテナンスの際には注 意が必要です。詳細は各商品ページをあらかじめご確認ください。
242

INTERIOR STYLE BOOK


TEL.045-664-3442
FAX.011-251-3151
FAX.045-664-3376
暮らしを彩る 洗練された空間を
TEL.011-251-3150
〒108-0075 東京都港区港南2-16-4 品川グランドセントラルタワー 4F
〒984-0031 仙台市若林区六丁目字南
サンゲツ品川ショールーム サンゲツ仙台ショールーム 北海道支社 西関東支社 TEL.092-441-5181
九州支社 [東北支社]北東北営業所/福島営業所 [北関東支社]群馬営業所/栃木 [東京支社]東関東営業所 [西関東支社]多摩営業所/厚木営業所 [中部支社]岐阜営業所/岡崎営業所/北陸支店/静岡営業所 [関西支社]京都営業所/神戸営業所/東大阪営業所/南大阪営業所 [中国四国支社]岡山営業所/四国支店 [九州支社]北九州営業所/熊本営業所/南九州営業所
TEL.0570-055-134 FAX.03-5463-6744
TEL.022-287-3922 FAX.022-253-6806
FAX.092-441-5191
壁紙選びの HOW TO
お部屋の中で一番面積の広い壁紙は、インテリアイメージを左右する重要なアイテムです。
壁紙選びのポイントやアクセントクロスの取り入れ方をご紹介します。
STEP 1
どのような部屋に したいかイメージする
STEP 2
お部屋に合わせて
壁紙を選ぶ
パブリックスペース
玄関・廊下・LDK
家族みんなで長い時間を過ご すリビングは、ベーシックで 飽きのこないデザインを。モ ダンな印象にするならすっき りとした石目調、リラックス できる空間にするなら温かみ のある織物調がおすすめです。

お部屋での過ごし方や、身のまわりの家具、 雑貨などをイメージして自分のライフスタイルに 合わせたインテリアスタイルを決めましょう。
壁紙にはさまざまなデザインがあります。
お部屋に合わせて適切な壁紙を選ぶことで、 より自分好みの空間をつくることができます。
プライベートスペース
居室・書斎・子ども部屋
プライベートなお部屋には、 自分の好きな色や柄の壁紙を 選んで、お気に入りの空間を つくってみませんか?アクセ ントクロスを取り入れること で、遊び心のあるオシャレな 空間にアレンジできます。

アクアスペース
洗面室・トイレ
毎日使う洗面室には、ホワイ トやペールトーンなど清潔感 のあるカラーがおすすめ。ト イレはアクセントクロスを取 り入れやすいポイント。便器 の背面や側面にアクセントク ロスを貼ると効果的です。

2
STYLE SELECT
床色から選ぶ


ホワイト・グレー
ホワイト・グレー系の床色は お部屋を明るくやさしい印象 に。


ライト・ナチュラル
どんな色の家具にも合わせや すいナチュラルな床色は定番 の人気カラー。


ミディアム・ダーク
落ち着いた印象のカラーは寝 室や書斎などプライベートな 空間におすすめ。
床材はお部屋の雰囲気を印象付けるベースカラーです。 お好みの床色とインテリアテイストの組み合わせを選び、 あなたにピッタリのスタイルを見つけてください。


 ジャパンディ P05
ナチュラル P09
モダン P13
ジャパンディ P05
ナチュラル P09
モダン P13
3






シンプルモダン
P17
北欧
P21
ホテルライク P25 エレガント P29
4
クラシック P33 インダストリアル P37
ジャパンディ JAPANDI

左壁/RE55092
アクセント/RE55093
天井/RE55229
床材/WD-2051
5

左右壁/RE55727 アクセント/RE55693 天井/RE55229 ウッドブラインド/WB115 床材/WD-2051
ジャパンディは日本と北欧のインテリアをミックスしたスタイル。 ベージュやアースカラーを基調としたモダンな空間に 自然素材の家具をプラスして、居心地の良い暮らしを演出しました。
/ JAPANDI
ジャパンディ
/
/
6

7
壁/RE55228 天井/RE55229 床材/WD-2051

壁/RE55095 床材/HM-11162
右壁/RE55626
左壁・天井/RE55595 床材/HM-11092

/ JAPANDI / ジャパンディ /
8
ナチュラル NATURAL

左壁/RE55821
右壁/RE55255
天井/RE55181
カーテン/AC2561
床材/WD-2031-W
9

左壁/RE55678 右壁/RE55305 カウンター下/RE55613 天井/RE55595 床材/WD-2032-W
ホワイト・ベージュ・グリーンを中心としたインテリアに、 木や植物などの自然素材を取り入れたスタイル。 シンプルで温かみのある空間です。 /
NATURAL
/ ナチュラル /
10

ウッドブラインド/WB105 床材/WD-2031-W 11
左壁/RE55334 アクセント/RE55584 天井/RE55181

左右壁/RE55028 アクセント/RE55824
左壁/RE55939
右壁/RE55094
床材/HM-11057

NATURAL
ナチュラル
/
/
/
12
モダン MODERN

左壁/RE55868
右壁/RE55629
天井/RE55229
床材/WD-2074
13

左壁・天井/RE55245 アクセント/RE55625 床材/WD-2074
モノトーンでまとめたスタイリッシュな空間。 直線的なインテリアやアートが似合う、 都会的なスタイルです。
/
モダン
MODERN /
/
14
 左壁/RE55074 アクセント/RE55873
左壁/RE55074 アクセント/RE55873
15
床材/WD-2074

アクセント/RE55621 右壁/RE55223 床材/HM-11124
壁/RE55635
床材/HM-11106

/ MODERN / モダン /
16
シンプルモダン SIMPLE MODERN

アクセント/RE55654 右壁・天井/RE55241 カーテン/AC2561 床材/WD-2051 17

左壁・天井/RE55243 アクセント/RE55884
モダンインテリアにナチュラル要素を組み込んだ、 生活になじみやすいスタイルです。
落ち着いた色味の中に植物や自然素材の小物を取り入れています。
/ SIMPLE MODERN / シンプルモダン /
18

19
壁/RE55072
天井/RE55246

アクセント/RE55667 右壁/RE55491 床材/HM-11113
左壁/RE55382
右壁/RE55860
天井/RE55229
床材/HM-11113

SIMPLE MODERN / シンプルモダン /
/
20
北欧 NORDIC

アクセント/RE55061 右壁・天井/RE55181 ニッチ奥(上・中段)/RE55040 ニッチ奥(下段)/RE55065 床材/WD-2031-W 21

手前壁・ヌック天井/RE55181 ヌック左壁/RE55052 ヌック右壁/RE55809
RE55809 Salmiakki
ナチュラルなインテリアに、幾何学柄や動植物のモチーフを取り入れて可愛らしく。
少しくすんだアースカラーを織り交ぜることで、 アクセントカラーを複数使っても上品にまとまります。 / NORDIC / 北欧 /
22

アクセント/RE55782 右壁・天井/RE55181 シェード/AC2308 床材/WD-2031-W 23
ELEFANTTI RIEMU Finlayson™ © Finlayson Oy

左壁/RE55659
右壁/RE55936
天井/RE55181
左壁/RE55046
右壁/RE55934
天井/RE55582
床材/HM-11103

/ NORDIC / 北欧 /
24

ホテルライク
天井/RE55181 カーテン/AC2296 床材/WD-2075 25
HOTEL LIKE 壁/RE55107

アクセント/RE55642 右壁・天井/RE55239 下がり天井/RE55616 床材/WD-2072
統一感があり、洗練された印象のインテリアスタイル。
できるだけ物を少なくすることで非日常感を演出しつつ、 間接照明や素材感のあるファブリックで落ち着いた空間に仕上げています。
/ HOTEL LIKE / ホテルライク /
26

カーテン/AC2285・AC2561 床材/WD-2075 27
壁/RE55881 天井/RE55181

左壁/RE55431 右壁/RE55260 床材/HM-11115

/ HOTEL LIKE / ホテルライク /
左壁/RE55240 アクセント/RE55901 床材/HM-11089
28
エレガント ELEGANT

壁/RE55103
天井/RE55243
床材/WD-2013
29

壁/RE55917 床材/WD-2013
華やかな装飾が特徴の、上品なインテリアスタイル。 ホワイトやグレイッシュな色味に丸みを帯びた家具を合わせて、 優美な空間に。
ELEGANT
/
/ エレガント /
30

© ENGLISH DESIGN AGENCY 左壁/RE55746 アクセント/RE55738 天井/RE55181 カーテン/AC2235・AC2565 床材/WD-2013 31

左壁/RE55296
右壁/RE55913

/ ELEGANT / エレガント /
壁/RE55915
天井/RE55209 床材/HM-11122
32
クラシック CLASSIC

33
壁/RE55893 見切り上/RE55128 天井/RE55181 床材/WD-2039-W

壁/RE55891 床材/WD-2039-W
きらびやかな装飾やデザインを中心にまとめた、伝統的なスタイル。 ダマスク柄のような高級感のあるモチーフや、 ブラウンなどのダークカラーでより重厚感を演出しています。
/ CLASSIC / クラシック /
34

左壁・天井/RE55181 アクセント/RE55909 カーテン/AC2319・AC2571 床材/WD-2039-W 35

アクセント/RE55657 右壁/RE55270
左壁/RE55400
右壁/RE55900
床材/HM-11109

/ CLASSIC / クラシック /
36
インダストリアル INDUSTRIAL

アクセント/RE55006 右壁・天井/RE55181 カーテン/AC2539 床材/WD-2075 37

アクセント/RE55098
右壁/RE55096 床材/WD-2072
コンクリートやアイアンといった無機質な素材を生かしたインテリア。 古材風の木目やレンガ、レザー等を使用した家具や小物を取り入れることで、 無骨すぎず味のある空間に仕上げています。
/ INDUSTRIAL / インダストリアル /
38

右壁/RE55613
天井/RE55229
床材/WD-2137
左壁/RE55605
39

左壁/RE55100 右壁/RE55684
左壁/RE55505
右壁/RE55586
床材/HM-11107

/ INDUSTRIAL / インダストリアル /
40

お気に入りのインテリアに出会える一冊
壁紙の選びやすさにこだわった、住まいを彩る 壁紙見本帳「リザーブ」。現代の日本のインテ リアにマッチするカラーやデザインを数多く取 り揃えました。植物由来の原材料を使用した壁 紙や、光のエネルギーでお部屋の衛生を保つ壁 紙など、新登場のアイテムも多数収録。
施工の面でも安心してお選びいただける、全点 準不燃のラインアップです。

理想のライフスタイルを叶える壁紙見本帳
国内外の最新トレンドを取り入れた個性あふれ る商品を多数収録。壁紙を選ぶ楽しさ、そこで 過ごす楽しさを提案する、わくわくを詰め込ん だ見本帳です。戸建てやマンションなどの住宅 物件を中心に、こだわりの空間づくりを実現す るラインアップです。



2024-2027 RESERVE(壁紙)
この写真集では 右記見本帳の商品を 掲載しています。
2023-2026 AC(カーテン)
お部屋のイメージづくりに!
壁紙・床材・カーテンを使っ て自由にお部屋イメージを確 認できる着せ替えツールです。
2022 RB COLLECTION(ブラインド 他)
2023-2026 FLOOR TILE(フロアタイル)
2022-2024 H FLOOR(クッションフロア)
それぞれの見本帳は有効期間が異なるため、 掲載商品は予告なく改定または廃番になる場 合があります。最新の価格や製品仕様につい ては弊社営業窓口までお問い合わせください。
RE55050 RE55027 RE55061
41
サンゲツ品川ショールーム
〒108-0075 東京都港区港南2-16-4
品川グランドセントラルタワー 4F
TEL.0570-055-134 FAX.03-5463-6744
サンゲツ名古屋ショールーム
〒451-8575 名古屋市西区幅下1-4-1
TEL.0570-055-135 FAX.052-564-3229
サンゲツ仙台ショールーム サンゲツ金沢ショールーム
〒984-0031 仙台市若林区六丁目字南98-1
TEL.022-287-3922 FAX.022-253-6806
〒920-8205 石川県金沢市大友2-101 TEL.076-238-1411 FAX.076-238-1412
サンゲツ大阪ショールーム
〒530-0001 大阪市北区梅田2-5-25 ハービスOSAKA 4F TEL.0570-055-136 FAX.06-6347-9811
サンゲツ広島ショールーム
〒730-0017 広島市中区鉄砲町7-18 東芝フコク生命ビル 1F TEL.082-223-8115 FAX.082-223-8117
北海道支社 東北支社 北関東支社
TEL.011-251-3150 FAX.011-251-3151
西関東支社
TEL.045-664-3442 FAX.045-664-3376
九州支社
TEL.092-441-5181 FAX.092-441-5191
[東北支社]北東北営業所/福島営業所
TEL.022-287-3765 FAX.022-287-2995
中部支社
TEL.052-564-3111 FAX.052-564-3191
TEL.048-601-5500 FAX.048-711-2681
事業所一覧はこちらより ご確認いただけます
サンゲツ福岡ショールーム
〒812-0892 福岡市博多区東那珂1-11-11 TEL.0570-055-137 FAX.092-441-9503
東京支社
TEL.03-3474-1181 FAX.03-3450-5038
関西支社 中国四国支社
TEL.06-6245-2301 FAX.06-6245-2302 TEL.082-223-8110 FAX.082-223-8120
[北関東支社]群馬営業所/栃木営業所/新潟営業所/茨城営業所/長野営業所
[東京支社]東関東営業所
[西関東支社]多摩営業所/厚木営業所
[中部支社]岐阜営業所/岡崎営業所/北陸支店/静岡営業所
[関西支社]京都営業所/神戸営業所/東大阪営業所/南大阪営業所
[中国四国支社]岡山営業所/四国支店
[九州支社]北九州営業所/熊本営業所/南九州営業所
〒901-2227 沖縄県宜野湾市宇地泊1-7-20 レキオススクエア宇地泊 3F F号室 TEL.098-897-8722 FAX.098-897-8724
サンゲツ沖縄ショールーム 〒901-2227 沖縄県宜野湾市宇地泊1-7-20 レキオススクエア宇地泊 2F TEL.098-890-2025 FAX.098-890-3789
42
INTERIOR STYLE






























































































































 RE55076
RE55076



 RE55079
RE55079








 RE55084
RE55084


















































 RE55614
RE55152
RE55614
RE55152



































































































































 RE55066
RE55099(P.36)
RE55098(P.36)
RE55060
RE55065(P.18)
RE55066(P.18)
RE55066
RE55099(P.36)
RE55098(P.36)
RE55060
RE55065(P.18)
RE55066(P.18)











 RE55098 NEW
RE55099 NEW
RE55098 NEW
RE55099 NEW






























 RE55112
RE55111
RE55112
RE55111

















 RE55127 NEW
RE55126 NEW
RE55128 NEW
RE55129 NEW
RE55127 NEW
RE55126 NEW
RE55128 NEW
RE55129 NEW





 RE55132
RE55131
RE55133
RE55134
RE55132
RE55131
RE55133
RE55134

RE55397
RE55398
RE55399
RE55397
RE55398
RE55399











































































































































































































 RE55590(1目盛り10cm)
RE55591
RE55590
RE55590(1目盛り10cm)
RE55591
RE55590







 RE55593
RE55593









































 RE55621
RE55620
RE55621
RE55620

































































 RE55658
RE55658
























 RE55669
RE55669


















































 RE55699
RE55699







 RE55705
RE55705
































































































































 Sami Vulli
Sami Vulli

























































 RE55835(1目盛り10cm)
RE55835(1目盛り10cm)





















































 RE55859
RE55859







 RE55861
RE55861





























 RE55874
RE55875
RE55876
RE55877
RE55875・55859
RE55874
RE55875
RE55876
RE55877
RE55875・55859























 RE55887
RE55887




























































 RE55913・55296
RE55915
RE55913・55296
RE55915





























































 RE55938
RE55938





























































 RE55946
RE55946













































































































 ジャパンディ P05
ナチュラル P09
モダン P13
ジャパンディ P05
ナチュラル P09
モダン P13


















 左壁/RE55074 アクセント/RE55873
左壁/RE55074 アクセント/RE55873




































